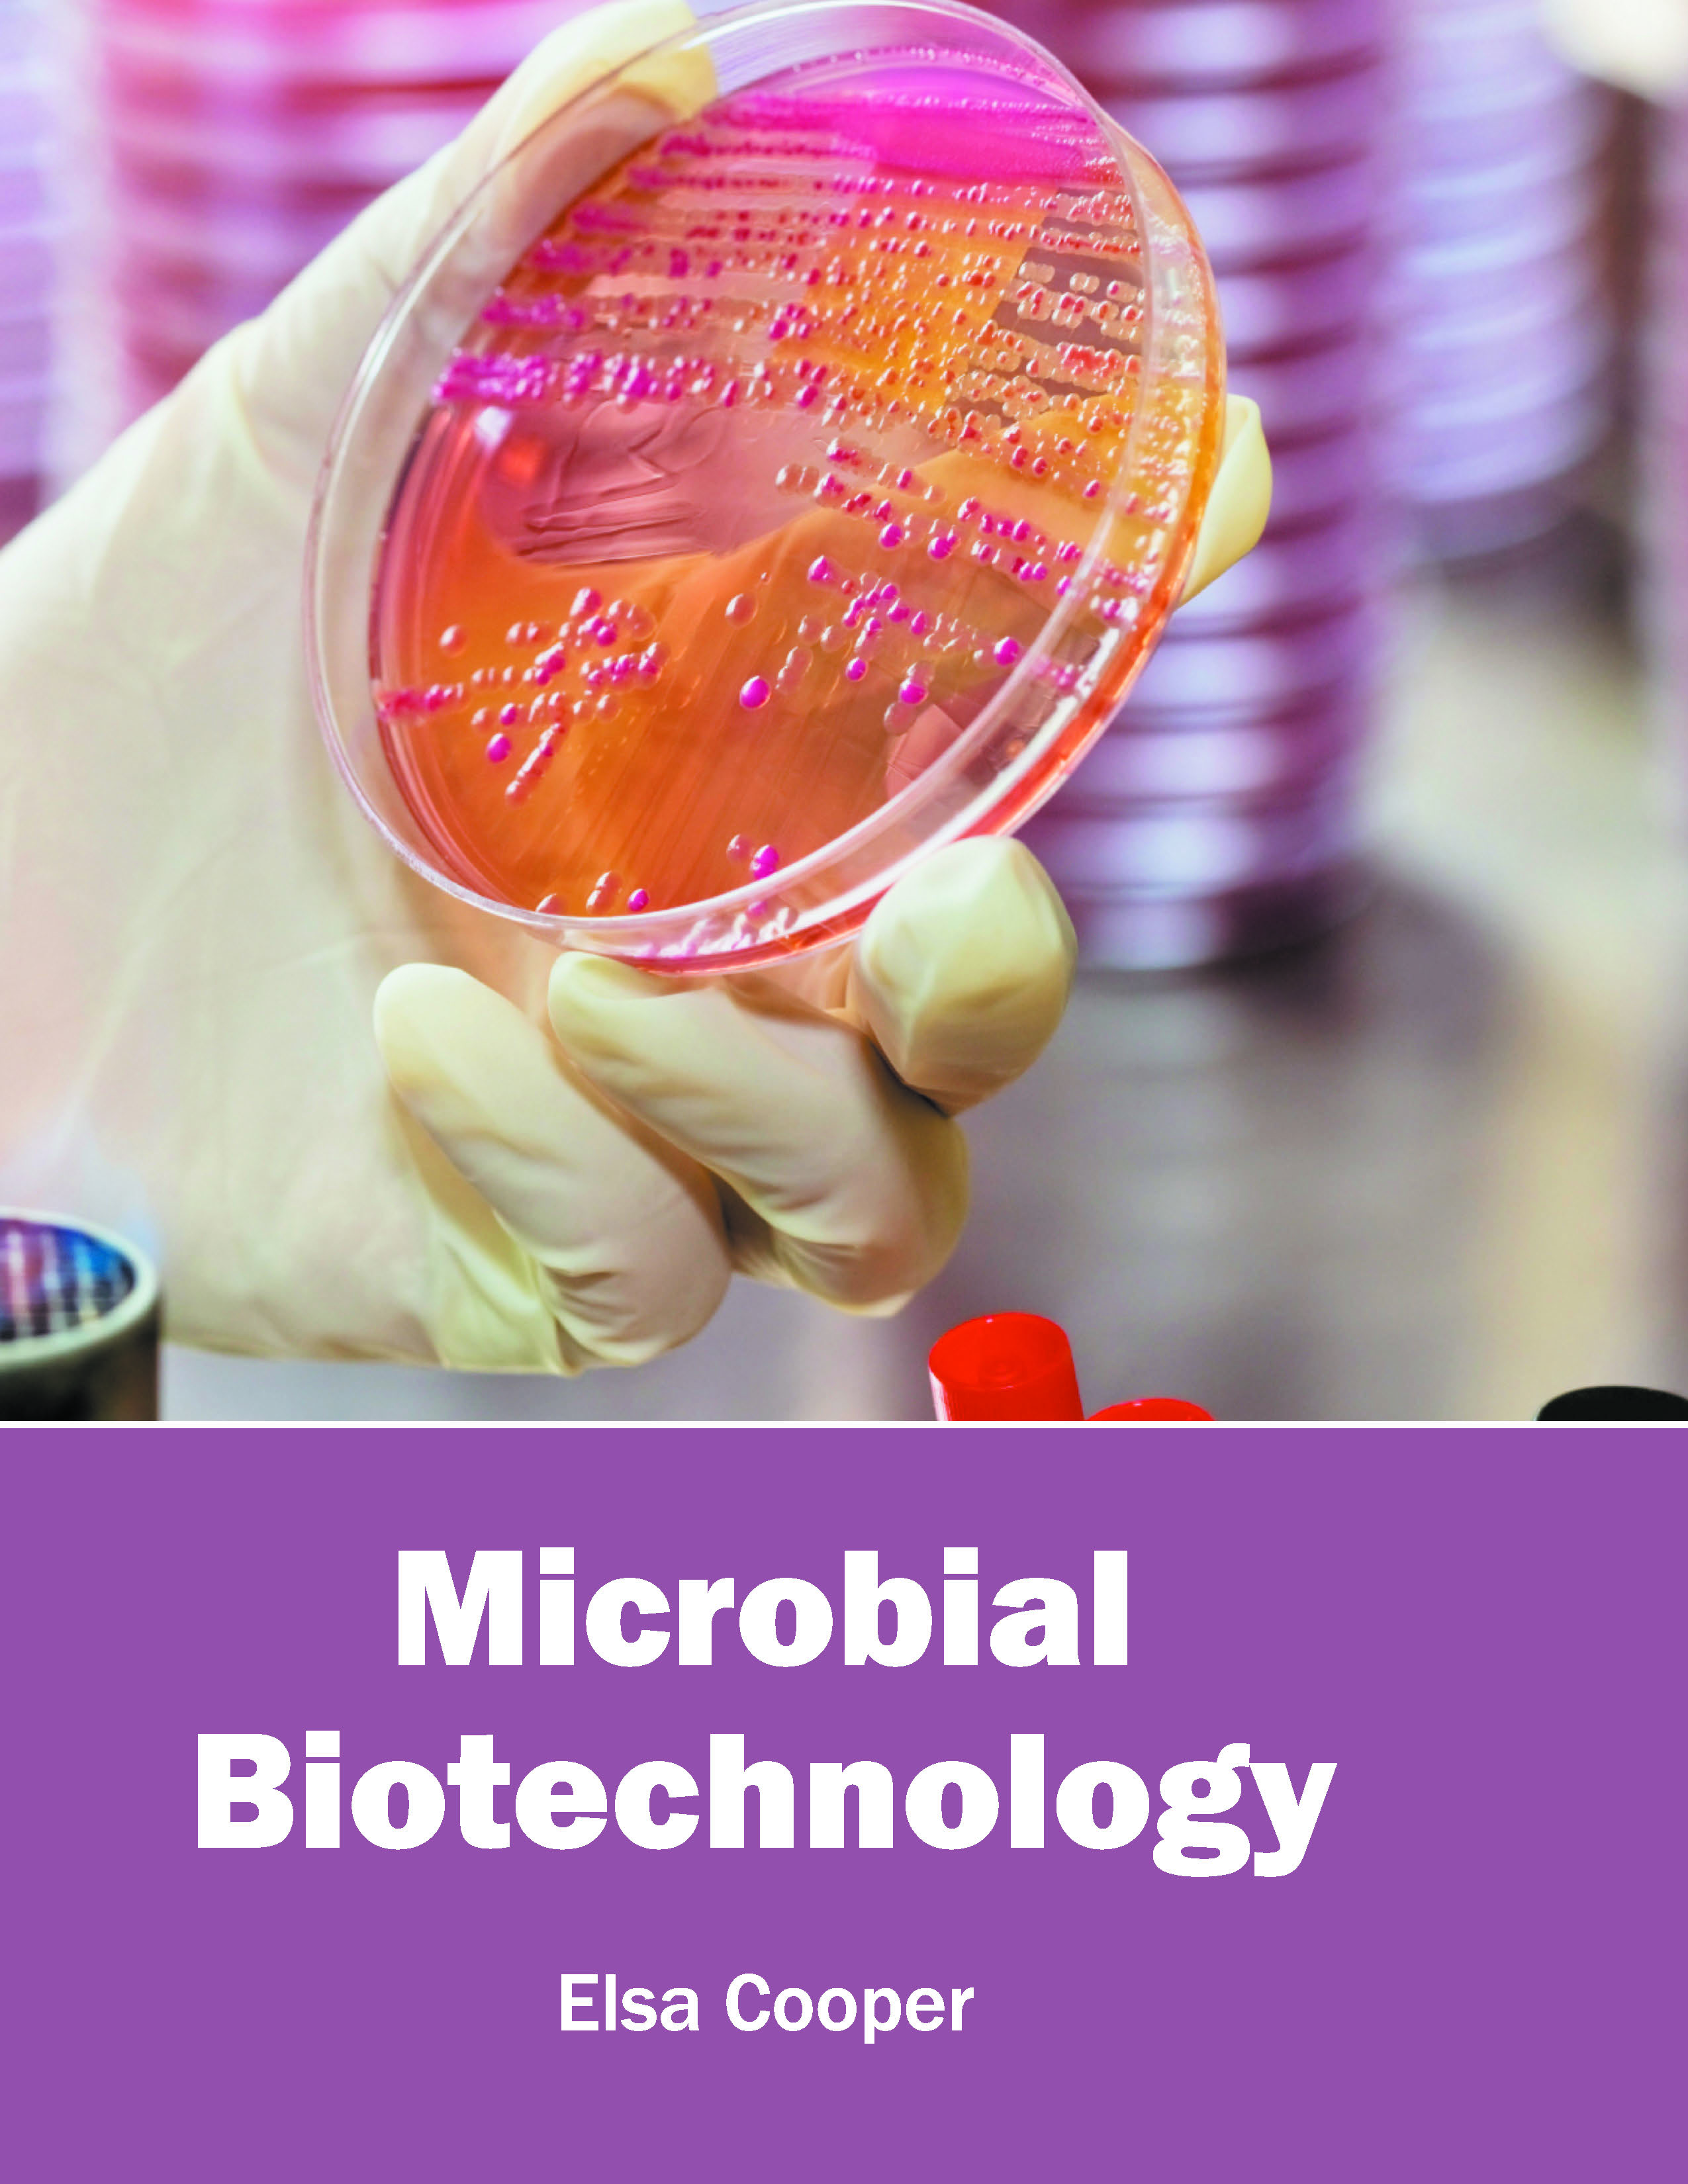

- Agricultural Sciences
- Agriculture and Plant Science
- Biochemistry, Genetics, Biotechnology and Molecular Biology
- Biological Sciences
- Business and Management
- Business, Management and Economics
- Chemistry
- Complementary and Alternative Medicine
- Computer and Information Science
- Earth and Planetary Sciences
- Education
- Energy
- Engineering & Technology
- Engineering and Technology
- Environmental Sciences
- Finance, Accounting and Business
- Food Science, Health and Nutrition
- Law
- Materials Science
- Mathematics
- Mathematics and Statistics
- Media and Communication Studies
- Medical Science
- Orthopedics, Sports and Rehabilitation Medicine
- Orthopedics,Physical, Sports and Rehabilitation Medicine
- Pharmaceutical Sciences
- Physics
- Psychology
- Public Health
- Public Health and Nursing
- Social Sciences
- Sports and Rehabilitation Medicine
- STEM
- Tourism and Hospitality
- Tourism, Hotel and Hospitality
- Veterinary Science and Medicine
- Vocational Education
- Zoology
- Zoology and Animal Science
- A.S. Duggal
- Aabhas Bansal
- Aabhas Dalal
- Aabhas Dhar
- Aabheer Arya
- Aadarsh Agarwal
- Aadarsh Gandhi
- Aadav Ahuja
- Aadav Arya
- Aadavan Ahuja
- Aadesh Arya
- Aadesh Balakrishnan
- Aadesh Batra
- Aadesh Laghari
- Aadeshwar Banerjee
- Aadhik Agarwal
- Aadhunik Burman
- Aadi Ahuja
- Aadi Khatri
- Aadi Shrivastava
- Aadidev Acharya
- Aadidev Agarwal
- Aadidev Garg
- Aadijay Chawla
- Aadil Faridi
- Aaditya Apte
- Aaditya Patel
- Aadiv Kapur
- Aagman Gokhale
- Aahat Khanna
- Aahna Saxena
- Aakaash Agarwal
- Aakash Girkar
- Aakash Grover
- Aakash Iyer
- Aakash Mehra
- Aakash Verma
- Aakesh Modi
- Aaradhya Varma
- Aarati Rao
- Aarav Dalal
- Aarav Singh
- Aarlan Golds
- Aarna Rao
- Aarohi Gupta
- Aaron Armstrong
- Aaron Clapham
- Aaron Goldenberg
- Aaron Jackson
- Aaron Mangal
- Aaron Murray
- Aaron Scott
- Aaron Sweat
- Aarul Bandyopadhyay
- Aarush Burman
- Aarush Handa
- Aarush Kapoor
- Aarush Mittal
- Aarush Singhania
- Aarusha Patil
- Aarushi Chawla
- Aarushi Tanwar
- Aaryesh Deshpande
- Aarzoo Kalra
- Aashish Anand
- Aashka Datta
- Aashna Kumar
- Aashutosh Acharya
- Aastik Balakrishnan
- Aatish Chawla
- Aavi Chakrabarti
- Aayush Shaw
- Aayushi Jain
- Abagail Morales
- Abbas Hussain
- Abbey Boyd
- Abbie Chavez
- Abby Calvin
- Abby Cusack
- Abby Todd
- Abby Tucker
- Abdul Aleem
- Abdul Azeem
- Abdul Azeez
- Abdul Baseer
- Abdul Maajid
- Abdul Maalik
- Abdul Majeed
- Abdul Mannan
- Abdul Qadeer
- Abdul Rahman
- Abdullah Sheikh
- Abdur Rahman
- Abel Hall
- Abel Walters
- Abha Joshi
- Abha Kadam
- Abhas Banerjee
- Abhay Mehrotra
- Abhay Sharma
- Abhayraj Kulkarni
- Abhi Chowdhury
- Abhidhyan Chattopadhyay
- Abhijaat Grover
- Abhijay Kaur
- Abhijeet Banerjee
- Abhijeet Dey
- Abhijeet Panda
- Abhijit Basu
- Abhijit Debbarma
- Abhijit Khatu
- Abhijit Mulye
- Abhik Gill
- Abhilash Dalal
- Abhimanyu Bindra
- Abhimanyu Burman
- Abhimanyu Chadha
- Abhimanyu Garg
- Abhimanyu Soni
- Abhinandan Mani
- Abhinash Dara
- Abhinav Chaturvedi
- Abhinav Johar
- Abhinav Verma
- Abhineet Dhawan
- Abhinendra Chauhan
- Abhiram Narayan
- Abhishek Khurana
- Abhishruti Verma
- Abhlesh Madan
- Abhyudita Kapoor
- Abigail Callahan
- Abigail Gipe
- Abigale Wells
- Abigayle Murray
- Abraham Alvarado
- Abraham Haskell
- Abrar Dar
- Abu Bakr
- Acacia Xzavier
- Acharya Bhatt
- Achyut Deshmukh
- Adalberto Renfro
- Adalina Woodbury
- Adaline Cerny
- Adam Bachman
- Adam Dargie
- Adam Garcia
- Adam Haynes
- Adam Heller
- Adam Houle
- Adam Powell
- Adam Reynolds
- Adam Rush
- Adan Wilbanks
- Adarsh Verma
- Adarsh Mendiratta
- Addison Black
- Addison Charlton
- Addison Cruz
- Adele Cullen
- Adele Raymond
- Adele Robb
- Adeline Foley
- Aden Crowley
- Adesh Bhardwaj
- Adheesh Verma
- Adhira Kapoor
- Adhira Rao
- Adil Ahmad
- Adinath Burman
- Adisyn Turney
- Aditi Dhillon
- Aditi Joura
- Aditya Bhatia
- Aditya Galvez
- Aditya Gupta
- Aditya Panchal
- Aditya Rana
- Aditya Sangram
- Aditya Semwal
- Adler Bryant
- Adnan Munavvar
- Adolph Grey
- Adolphe Thorpe
- Adonis Cruickshank
- Adonis Niles
- Adrian Bradley
- Adrian Day
- Adrian Dean
- Adrian Fletcher
- Adrian Franel
- Adrian Nolan
- Adrian Oneal
- Adrian Wolf
- Adriana Ellis
- Adriana Jones
- Adriana Winkler
- Adrianna Todd
- Adriel Brown
- Adrien Butler
- Adrien Driver
- Aduardo Hapke
- Advait Agarwal
- Advik Pandey
- Aejaz Husain
- Aganya Arya
- Agatha Williams
- Agatha Wilson
- Agnes Nolan
- Agnes Reaves
- Agnes Sim
- Agnes Wilson
- Agustin Willmott
- Ahana Mahajan
- Ahmad Crutcher
- Ahmed Faruqui
- Aidan Butler
- Aidan Foley
- Aiden Black
- Aiden Damico
- Aiden Logan
- Aiden Martinez
- Aiden Preston
- Aiden Watts
- Aiden Weaver
- Aiden West
- Aiden Williams
- Aimee Wallace
- Aisha McCullough
- Aishani Patel
- Aishna Shettty
- Aishwarya Mani
- Aizah Blair
- Ajanta Dixit
- Ajay Bakshi
- Ajay Banerjee
- Ajay Desai
- Ajay Jamatia
- Ajay Kaushik
- Ajay Kumar
- Ajay Padval
- Ajay Pillai
- Ajay Reang
- Ajay Yashpal
- Ajeet Mahto
- Ajit Balakrishnan
- Ajith Nambiar
- Akarsh Basra
- Akasa Anand
- Akash Kumar
- Akash Pakhidde
- Akash Sharma
- Akhil Jain
- Akhil Mishra
- Akhilesh Ahuja
- Akilhesh Rai
- Akira Hanako
- Akriti Pillai
- Akshara Rishi
- Akshat Raizada
- Akshay Chawla
- Akshay Gill
- Akshay Khurrana
- Akshay Rawal
- Akshaya Acharya
- Al Hundley
- Alabaster Jenkins
- Alaina Gonzales
- Alaiya Pearce
- Alan Ashman
- Alan Evans
- Alan Fraser
- Alan Klein
- Alan Lyons
- Alan Moore
- Alan Rowe
- Alba Robertson
- Albert Copeland
- Albert Harmon
- Albert Kelly
- Albert Marinelli
- Albert Maxwell
- Albert McCoy
- Albert Plummer
- Albert Traver
- Alberto Ascari
- Albie Morris
- Albie Reid
- Alden Putman
- Alden Whitley
- Alejandra Donaldson
- Alejandro Carlin
- Alejandro Cooke
- Aleksey Leach
- Alena Ross
- Alessandro Torello
- Alessio Boyle
- Alex Bradley
- Alex Collins
- Alex Duncan
- Alex Hall
- Alex Simpson
- Alex Vedder
- Alexa Dixon
- Alexa Franklin
- Alexander Castro
- Alexander Chapman
- Alexander Clark
- Alexander Gomez
- Alexander Hernandez
- Alexander Palumbo
- Alexander Reed
- Alexander Toker
- Alexandra Hewitt
- Alexandra Scott
- Alexandro Binder
- Alexis Callahan
- Alexis Crum
- Alexis Federer
- Alexis Sanders
- Alexis Taylor
- Alexis White
- Alexzander Leclair
- Alfie King
- Alfie Lloyd
- Alfie Williams
- Alfred Galswells
- Alfred Mills
- Alfred Muller
- Alfred Scott
- Alfred Silva
- Alfred Webb
- Alfred White
- Alfredo Adkins
- Ali Lo
- Aliana Grimes
- Alice Grenouille
- Alice Harris
- Alice Kunek
- Alice Powers
- Alice Wheeler
- Alicia Brooks
- Alicia Harper
- Alicia Witte
- Alis Ellison
- Alisa Collins
- Alisha Charak
- Alisha Evans
- Alisha Gola
- Alison Chapman
- Alison Craft
- Alison Landers
- Alison Vaughn
- Alissa Ross
- Alistair Doyle
- Alivia Snow
- Aliyah Gonzalez
- Aliyah Wheatley
- Alize Scott
- Alka Wadhwa
- Allan Bardsley
- Allegra Smith
- Allen O'Conner
- Allen Richardson
- Allen Yuen
- Alley Webster
- Allie Gaines
- Allie Lopez
- Allie Weaver
- Allison Hopkin
- Allison Sergeant
- Ally Wadsworth
- Allyson Hall
- Allyson Westley
- Alok Anand
- Alok Bose
- Alok Khatri
- Alok Mahajan
- Alonso Delossantos
- Alva Borders
- Alvaro Crooks
- Alvaro Leone
- Alvin Fuller
- Alvin Moran
- Alvin Shinn
- Alvina Cuoco
- Alysha White
- Alyson Thomas
- Alyssa Coleman
- Alyssa Gibbs
- Alyssa Taylor
- Amalia Cladwell
- Aman Khanna
- Aman Sharma
- Amanda Dollar
- Amanda Stanton
- Amanda Wang
- Amanda Wegener
- Amanda Wilson
- Amaneesh Modi
- Amanjot Pandey
- Amar Anand
- Amar Pathak
- Amarah Williamson
- Amardeep Chahal
- Amari Gamboa
- Amber Fowler
- Amber Hall
- Amber Hooper
- Amber Jarman
- Amber Jenkins
- Amber Ward
- Ambika Acharya
- Ambrose Wilson
- Ambuj Goel
- Ameet Patel
- Amelia Armstrong
- Amelia Coppersmith
- Amelia Epps
- Amelia Foster
- Amelia Lahr
- Amelia Turner
- Amira Saddler
- Amish Bakshi
- Amish Ganguly
- Amit Chauhan
- Amit Gupta
- Amit Jamatia
- Amit Kharbanda
- Amit Reang
- Amit Saini
- Amit Saran
- Amit Saxena
- Amit Sompura
- Amit Tripura
- Amita Jain
- Amitesh Agarwal
- Amitesh Mandal
- Amiteshwar Anand
- Amol Patel
- Amol Tyagi
- Amol Verma
- Amora Edwards
- Amora Payne
- Amrik Singh
- Amrit Panesar
- Amrita Rai
- Amritpal Singh
- Amy Reed
- Amy Temple
- Amy Walker
- Anabelle Holmes
- Anahi Beaudry
- Anais Bowler
- Anaisha Khemka
- Anaita Shroff
- Anaka Verma
- Anand Bali
- Anand Gurnani
- Anandi Reddy
- Anandita Joshi
- Anant Reddy
- Ananya Mohanty
- Ananya Paramar
- Ananya Rao
- Ananya Singh
- Ananya Tripura
- Anas Siddiqi
- Anastasia Christ
- Anastasia Maddox
- Anastasia Stokes
- Anastasia Sutton
- Anaya Kapoor
- Anchal Jain
- Anderson Murphy
- Anderson Sheilds
- Andra Quinn
- Andre Douglas
- Andre Griffin
- André Walter
- Andrea Farrington
- Andrea Ferro
- Andrea Santoro
- Andreas Byers
- Andreas Hein
- Andreea Mitchell
- Andreea Thompson
- Andrei Sheppherd
- Andres Albarado
- Andres Flynn
- Andrew Black
- Andrew Burton
- Andrew Clegg
- Andrew Green
- Andrew Haynes
- Andrew Hines
- Andrew Hyman
- Andrew Stubblefield
- Andy Beveridge
- Andy Garcia
- Andy Margo
- Andy Mathews
- Andy Parker
- Angel Cathey
- Angel Craig
- Angela Bellisio
- Angela Horning
- Angela Santos
- Angelina Gleason
- Angelina Stark
- Angeline Mcnamee
- Angelique Mitchel
- Angelo Todd
- Angie Klein
- Angus Sanders
- Angus Wheeler
- Anika Stowers
- Aniket Goel
- Aniket Jadhav
- Aniket Jhaveri
- Aniket Kumar
- Aniket Matrey
- Aniket Raj
- Anil Ahuja
- Anil Ghodeshwar
- Anil Maurya
- Anil Rathod
- Anil Verma
- Anila Nair
- Animesh Ghoshal
- Anindita Ray
- Anindita Sen
- Aniruddh Arya
- Aniruddh Goswami
- Aniruddha Thakur
- Anirudh Dhumal
- Anirudh Gera
- Anirudh Singh
- Anish Khatri
- Anita Raj
- Aniya Banner
- Anjali Boro
- Anjali Burbank
- Anjali Deb
- Anjali Jain
- Anjali Patel
- Anjali Reddy
- Anjali Sinha
- Anjana Jamatia
- Anju Kapoor
- Ankhi Banerjee
- Ankit Verma
- Ankita Basu
- Ankita Saikia
- Ankita Shinde
- Ankur Gupta
- Ankur Roy
- Ankur Vyas
- Anmol Awasthi
- Anmol Mondal
- Ann Desjardins
- Ann Johnson
- Anna Freeman
- Anna Garner
- Anna Nelson
- Anna Sanders
- Anna Smith
- Annabel Fox
- Annabelle Coleman
- Annabelle Pearson
- Annabelle Perry
- Annabelle Scott
- Annabelle Turner
- Annabelle Webb
- Annalise Jaime
- Anne Gordon
- Anne Lamontagne
- Anne Offit
- Anne Shaw
- Annie Gilbert
- Annie Kent
- Annika Brayan
- Anoop Kapoor
- Anoushka Reddy
- Ansh Bhatia
- Ansh Joshi
- Anshul Bedi
- Anshul Priya
- Anshumaan Kamble
- Anshuman Rathore
- Ansley Necaise
- Antara Boro
- Anthony Auster
- Anthony Chia
- Anthony Clive
- Anthony Jenkins
- Anthony Moore
- Anthony Rocus
- Anthony Schindler
- Anthony Sherman
- Anthony Washington
- Anthony White
- Anthony Wright
- Antione Sotelo
- Antoine Buffington
- Anton Torres
- Antonio Ayers
- Antonio Bedingfeld
- Antonio Chavez
- Antonio Farrell
- Antonio Price
- Antonio Reid
- Antonio Russo
- Antony Crawford
- Antony Robinson
- Anubhav Kathuria
- Anubhav Manjhi
- Anuj Parmar
- Anuja Verma
- Anup Mukherjee
- Anupam Sinha
- Anupama Prajapati
- Anupama Trivedi
- Anupreet Singla
- Anuraag Kadam
- Anuradha Bhasin
- Anuradha Chakma
- Anuradha Pathak
- Anurag Bedi
- Anurag Singh
- Anurita Kushwaha
- Anusha Sinha
- Anushree Bhagat
- Anvay Mehta
- Anvika Mehta
- Anvita Singh
- Anwar Hafeez
- Aparna Debbarma
- Aparna Iyer
- Aparna Nair
- Aparna Sood
- Apoorva Bandopadhyay
- Apoorva Mehta
- Apoorva Seth
- Aprajita Kashyap
- April Hilbert
- April Norris
- April Watson
- Araceli Barringer
- Aradhya Nair
- Aravind Mohanty
- Arav Sharma
- Archana Madan
- Archana Sinha
- Archer Green
- Archer Queen
- Archie Baker
- Archie Green
- Archie Rogers
- Archit Kumar
- Archit Soni
- Arely Cazares
- Aria Anderson
- Aria Cress
- Aria Hall
- Aria Kramer
- Aria Mitchell
- Aria Perry
- Aria Sawyer
- Aria Stewart
- Ariana Woodward
- Arianna Cunningham
- Arianna Reeves
- Arielle Hunter
- Arijit Talwar
- Arindam Bordoloi
- Arisha Wilkinson
- Aristotle Lowe
- Arjun Applegate
- Arjun Debbarma
- Arjun Reang
- Arla Beattie
- Armando Ruiz
- Arnulfo Free
- Aron Jimenez
- Aron Rae
- Aron Rees
- Arpita Reang
- Arron Shorter
- Arshad Thakur
- Arshdeep Khera
- Arthur Ball
- Arthur Beckwith
- Arthur Bloomberg
- Arthur Colfer
- Arthur Handley
- Arthur Nelson
- Arthur Willis
- Arthur Yates
- Arti Bagga
- Artie Weissberg
- Arun Kumar Sharma
- Arun Prasad
- Arun Raj
- Arun Samra
- Aruna Iyer
- Arundhati Jain
- Arup Mukherjee
- Arushi Waghmare
- Arvind Bhalla
- Arvind Goswami
- Arvind Khatri
- Arvind Patel
- Arvind Rathod
- Arvind Singh
- Arvind Soni
- Arvind Sridhar
- Arvind Verma
- Arya Saini
- Aryan Sitlani
- Ashanti Paulk
- Asher Clark
- Asher Sampson
- Ashish Anant
- Ashish Grewal
- Ashish Kumar
- Ashish Ranglani
- Ashish Seharawat
- Ashish Trivedi
- Ashish Yadav
- Ashley Coleman
- Ashley Fisk
- Ashley Hemsworth
- Ashley Martin
- Ashley Mills
- Ashley Potter
- Ashley Robertson
- Ashley Waters
- Ashlie Archer
- Ashlyn Bosley
- Ashok Agarwal
- Ashok Devdutt
- Ashok Kumar Srivastava
- Ashok Sawant
- Ashokan Karthik
- Ashton Deane
- Ashton Goldberg
- Ashton Nagle
- Ashton Peterson
- Ashton Scott
- Ashton Ward
- Ashu Pandit
- Ashutosh Apte
- Ashutosh Biswal
- Ashutosh Sethi
- Ashwaghosh Purohit
- Ashwin Bhandare
- Ashwin Gulati
- Ashwin Singhaniya
- Ashwini Kale
- Ashwini Kumar
- Ashwini Suchanti
- Asia Fulkerson
- Asim Lahiri
- Aslam Sheikh
- Asmita Thakare
- Aston Gunn
- Atharv Rampal
- Atithi Kumbhar
- Atlas Yardley
- Atticus Melin
- Atticus Rodger
- Atul Singhaniya
- Atul Talwar
- Aubree Boyd
- Aubrey Roddy
- Aubrey Thomas
- Aubrey Walsh
- Audrey Coon
- Audria Baldwin
- Augusta Lawrence
- Augustus Banner
- Augustus Drew
- Augustus Green
- Augustus Winstead
- Aurelia Steele
- Aurora Carter
- Aurora Churchill
- Aurora Hensley
- Aurora Lewis
- Aurora Moran
- Aurora Moretti
- Aurora Phillips
- Austen Edwards
- Austin Balfour
- Austin Brennan
- Austin Doran
- Austin Richards
- Autumn Fisher
- Ava Bailey
- Ava Bernice
- Ava Bradbury
- Ava Freeman
- Ava Madison
- Ava Santiago
- Ava Smith
- Ava-Mae Dickson
- Avalok Reddy
- Avaneesh Deshpande
- Avani Menon
- Avani Rao
- Aveer Mukhiya
- Avery Steele
- Avianna Stokes
- Avijit Khatri
- Avika Kulkarni
- Avilash Rawat
- Avinash Goyal
- Avinash Verma
- Avtar Panesar
- Avyukt Dewan
- Avyukt Sharma
- Axel Hou
- Ayan Edwards
- Aydan Bailey
- Ayden Llyod
- Ayden Palma
- Ayden Spears
- Ayesha Nair
- Ayla Munger
- Aylin Piazza
- Aysha Beach
- Ayush Raghaw
- Ayush Tambe
- Ayushi Jain
- Ayzel Todd
- Azaan Shakir
- Baala Tanwar
- Baalaji Yadav
- Baani Kapoor
- Baani Patel
- Babita Dutta
- Babita Reddy
- Babul Khatri
- Babulal Jadav
- Badal Sanghvi
- Badari Prasad
- Badarinath Rana
- Badri Sharma
- Badrinadh Upadhyay
- Badriprasad Chauhan
- Badriprasad Suri
- Bahumanya Ghosh
- Bahumanya Malhotra
- Baidyanath Pal
- Baidyanath Rajput
- Bajrang Pawar
- Bajrang Verma
- Bajrang Vishwakarma
- Bala Bansal
- Balachandan Reddy
- Balachandar Nath
- Balachandra Suri
- Balagopal Solanki
- Balaraj Anand
- Balavant Bal
- Balchandra Sethi
- Baldev Chander
- Baldev Dhar
- Baljit Sidhu
- Balkrishan Iyer
- Balvant Nigam
- Balwant Aulakh
- Balwant Nijjar
- Balwant Sidhu
- Banshi Chaurasiya
- Bansi Yadav
- Banu Chander
- Barbara Mayer
- Barbara Pearson
- Barbara Roth
- Barbara Wheaton
- Bargavi Parikh
- Barkha Anand
- Barkha Bhalla
- Barkley Sparks
- Barnaby Abbott
- Barney Laine
- Barney Payne
- Barney Tyler
- Barrett Adkins
- Barrett Lindquist
- Barrie Norman
- Barry Hill
- Bart Begley
- Barton Dockery
- Barun Bhattacharya
- Bashir A.Lone
- Basil Hoyle
- Baylee Beardsley
- Beatrice Pollard
- Beatrix Sharp
- Beau Murray
- Beckham Inskip
- Bela Reddy
- Belinda Bradbury
- Belinda Pitman
- Bella Cunningham
- Bella Harper
- Bella Moody
- Bella-Rose Henry
- Belle Caldwell
- Ben Collins
- Ben Davidson
- Ben Davies
- Ben Henley
- Ben Kinkaid
- Ben Perry
- Ben Simmons
- Benafsha Khan
- Benedict Hunt
- Benedict Nelson
- Benedict Walsh
- Benito Olin
- Benjamin Abbington
- Benjamin Copes
- Benjamin MacClare
- Benjamin Miller
- Benjamin Owen
- Benjamin Phillips
- Benjamin Schultz
- Benjamin Thornberg
- Benjamin Wayne
- Benjamin West
- Benjy Elliott
- Bennett Fitch
- Bennett Perez
- Benny Buchan
- Benny Lewis
- Benson Scott
- Bernard Conley
- Bernard Geller
- Bernard Hanbury
- Bernard Tyler
- Bernard Watts
- Bernard Wilcox
- Bernard Wilde
- Bernhard Ekman
- Bernice Wyong
- Bernie Goldman
- Bert Hudson
- Bert Sawford
- Bertha Russell
- Bertie Chotae
- Bertie Trunbell
- Bertram O'Neal
- Beth Thorpe
- Bethany Ferguson
- Betty Hong
- Betty Karasek
- Beverly Collins
- Bhagat Verma
- Bhagesh Kumar
- Bhagwant Ganguly
- Bhagwati Devi
- Bhakti Dua
- Bhanumati Verma
- Bharat Joshi
- Bharat Raut
- Bharati Rao
- Bhargav Patel
- Bhargavi Krishnan
- Bharti Mishra
- Bhavesh Mishra
- Bhavesh Paramar
- Bhavik Malhotra
- Bhavika Joshi
- Bhavika Suri
- Bhavini Mehta
- Bhavna Chaturvedi
- Bhavyam Sharma
- Bhawna Ghosh
- Bheem Singh
- Bhoomika Narain
- Bhoumik Rana
- Bhupesh Rathod
- Bhupinder Singh
- Bianca Drake
- Bianca Keaton
- Bianka Palmer
- Bidisha Kapoor
- Bijoy Deb
- Bijoy Tripura
- Bikram Verma
- Bill Docherty
- Bill Fraley
- Billy Acord
- Billy Malcolm
- Bilroy Lockhart
- Binod Rana
- Biplab Mukherjee
- Biswajit Jamatia
- Blake Brooks
- Blake Clifford
- Blake Finn
- Blake Forte
- Blake Hughes
- Blake Walsh
- Blanche McGowan
- Blanka Wilson
- Bob Tucker
- Bobbi Trunbell
- Bobby Harrison
- Bobby Jones
- Bobby Perez
- Bonnie Russo
- Bonnie Wakeling
- Boris Vega
- Brad Hill
- Brad Jameson
- Braden Bowen
- Bradley Delk
- Bradley Foster
- Bradley Horne
- Bradley McGrath
- Brady Walton
- Bran Conley
- Bran Powell
- Brandon Chesser
- Brandon Gomez
- Brandon Hanks
- Brandon Holland
- Brandon Taylor
- Brantley Kelley
- Braxton Fitzsimmons
- Braxton Salazar
- Braxton Stewart
- Brayden Anderson
- Braydon Herrmann
- Braylen Stevenson
- Braylon Holden
- Braylon Vincenzo
- Breana Silas
- Brenda Allen
- Brenda Baldridge
- Brendan Marshall
- Brendan Stanfield
- Brenden Swafford
- Brendol Keith
- Brendon Gould
- Brendon Krauss
- Brendon Thorn
- Brenna Boatman
- Brennan McNally
- Brent Burton
- Brent Malcolm
- Breonna Cage
- Brett Rice
- Brian Bechdal
- Brian Gardiner
- Brian Hurley
- Brian Jackson
- Brian Jason
- Brian Jenkins
- Brian Maxwell
- Brian O'Neill
- Brian Shelton
- Briana Eads
- Brianna Gray
- Brianna Hannah
- Brianna Peralta
- Bridget Crafts
- Bridget Harrington
- Bridget Kent
- Brie Forester
- Brielle Cross
- Brielle Pittman
- Brijesh Agarwal
- Brinda Bhatt
- Brinda Kapoor
- Brionna Segal
- Britt Nettles
- Brittany Brookshire
- Brittany McGrath
- Broderick Still
- Brodie Banda
- Brodie Russell
- Brody Walker
- Brooke Hendricks
- Brooke Sheppherd
- Brooks Ware
- Bruce Collins
- Bruce Hardie
- Bruce Hopkin
- Bruce Horak
- Bruce Mullan
- Bruce Rhames
- Bruce Robinson
- Bruno Crump
- Bryan Christenson
- Bryan Evans
- Bryan Lin
- Bryanna Lundgren
- Bryant Emmons
- Bryce Carroll
- Brycen Laning
- Bryson Beattie
- Bryson Bolin
- Bryson Cooper
- Bryson Freeland
- Bryson McCleary
- Bryson Walsh
- Buck Buford
- Bucky Barnes
- Bud Elrod
- Buddy Milam
- Burl Guillen
- Burt Meehan
- Burton Kohler
- Byrant Hill
- Byron Brodie
- Cade Doherty
- Caden Bishop
- Caden Knight
- Caden Mccurdy
- Caiden Boyd
- Caiden Elliott
- Caitlin Pellegrino
- Calanthia Wright
- Cale Benner
- Caleb Bell
- Caleb Davis
- Caleb Elliot
- Caleb Fortier
- Caleb Robbins
- Caleb Watson
- Cali Sebastian
- Callen Hogan
- Callen Lucas
- Callen Norris
- Callen Stokes
- Callie Tolley
- Callum Gray
- Callum Lloyd
- Calton Reed
- Calvin Barker
- Calvin Bush
- Calvin Rhoads
- Calvin White
- Camden Howard
- Cameron Dawson
- Cameron Harris
- Camila Blair
- Camila Christmas
- Camila Thompson
- Camille Hughes
- Camille Zellweger
- Camron Outlaw
- Camryn Fredrick
- Cara Chalmers
- Carey Sledge
- Carissa Riddell
- Carl Booth
- Carl Burt
- Carl Parsons
- Carl Trey
- Carla Mayfield
- Carla Schoonover
- Carli Zink
- Carlie Bernhardt
- Carlos Davenport
- Carlos Dayton
- Carlos Hassey
- Carlos Mattox
- Carlos Rickman
- Carlos Wyatt
- Carly Caraway
- Carlyle Bennet
- Carmelo Poindexter
- Carmen Chitwood
- Carmen Coffey
- Carmen Ferguson
- Carol Connolly
- Carol Devore
- Carol Evans
- Carol Hayes
- Carol Ramsey
- Carol Thorburn
- Caroline Francis
- Caroline Gardner
- Caroline Harrington
- Caroline Rivera
- Caroline West
- Carroll Ferguson
- Carson Diaz
- Carson Evans
- Carson Graves
- Carson Hansen
- Carson Taylor
- Carson Thomas
- Carsten Cooper
- Carter Allen
- Carter Campbell
- Carter Hudson
- Carter Moore
- Casan Anderson
- Casey Judd
- Casey Murphy
- Casey Sacco
- Casey Stokes
- Casey Swanson
- Casper Barnes
- Casper Geller
- Casper Watt
- Cassandra Jones
- Cassandra Shelly
- Cassandra Young
- Cassian Cameron
- Cassius Foster
- Caster Sumner
- Catelyn Wilkerson
- Catherine Hall
- Catherine Hastings
- Catherine Waltz
- Cathy Gates
- Cathy Hogan
- Catlyn Bennett
- Cayden Bell
- Cecilia Bryant
- Cecilia Coggins
- Cecilia Gerhard
- Cedric Hodgson
- Celeste Stewart
- Celia Lopez
- Celina Hardaway
- Celine Henderson
- Cersei Nash
- Cersei Page
- Cesar Gavin
- Cesar O'Neil
- Chaanakya Lal
- Chaarudatt Jai
- Chaarvi Sharma
- Chaarvik Aggarwal
- Chaaya Sehgal
- Chaayavati Pal
- Chaaya Shah
- Chad Downs
- Chad Flemming
- Chadwick Martel
- Chainika Rai
- Chaitali Chandra
- Chaitali Nath
- Chaitaly Goel
- Chaitan Bhatt
- Chaitan Raji
- Chaitana Raji
- Chaitanya Puri
- Chaitra Kapoor
- Chaitravi Jindal
- Chaitrika Patel
- Chakradev Chandra
- Chance Aquino
- Chandan Gulati
- Chandan Joshi
- Chandan Shekhawat
- Chandana Deka
- Chandana Gogoi
- Chander Raj
- Chander Saini
- Chandler Bowens
- Chandni Manohar
- Chandnika Charan
- Chandni Aggarwal
- Chandra Swami
- Chandraaditya Chauhan
- Chandraayan Neela
- Chandrabha Charan
- Chandragupt Nagpal
- Chandrahas Krishnamurthy
- Chandrakant Verma
- Chandrasen Ganesh
- Chang Forman
- Charan Jindal
- Charanjit Padda
- Charanjit Sidhu
- Charita Rao
- Charity Moultrie
- Charles Bale
- Charles Brown
- Charles Burke
- Charles Carter
- Charles Freeman
- Charles Harper
- Charles Heim
- Charles Hughes
- Charles Johnston
- Charles Malkoff
- Charles Murphy
- Charley Cheatham
- Charlie Carson
- Charlie Evans
- Charlie Fennell
- Charlie Fowler
- Charlie Harris
- Charlie Marshall
- Charlie O'Neill
- Charlie Penn
- Charlie Ward
- Charlin Chester
- Charline Ryler
- Charlotte Davies
- Charlotte Lance
- Charlotte Stedman
- Charlotte Sullivan
- Charu Anand
- Charu Dewan
- Charu Jain
- Charu Nagpal
- Charuprabha Nigam
- Charuvrat Chakrabarti
- Charvi Naran
- Charvi Nigam
- Charvik Goenka
- Charvi Manohar
- Chas Neumann
- Chase Harris
- Chase Jones
- Chaya Iyer
- Chayma Hamdani
- Chaz Francisco
- Chelsey Brownell
- Chelsey Ronan
- Cherilyn Jose
- Cheryl Chang
- Cheryl Jollymore
- Cheshta Darsha
- Chester Hunter
- Chester Isbell
- Chester Mann
- Chester Ward
- Chester Watters
- Chetak Punj
- Chetan Aanand
- Chetan Chakrabarti
- Chetan Patel
- Chetan Punj
- Chetana Mehta
- Chetana Sehgal
- Chetna Gupta
- Chetna Vish
- Chiara White
- Chinmay Gandhi
- Chinmay Saini
- Chinmay Saxena
- Chintanika Gandhi
- Chirag Gupta
- Chirag Rao
- Chirag Vasistha
- Chiranjeev Parsad
- Chiranjeev Patel
- Chiranjeev Reddy
- Chiranjeevi Kapoor
- Chiranjiv Saini
- Chitesh Sikka
- Chitra Narang
- Chitrabaahu Saini
- Chitraksh Jindal
- Chitrakshi Nagpal
- Chitraman Veena
- Chitrangada Kumar
- Chitrarati Jindal
- Chitrarthi Dutta
- Chitrika Jindal
- Chitrya Sehgal
- Chittaprasad Saxena
- Chittesh Saxena
- Chloe Clark
- Chloe Cooper
- Chloe Murphy
- Chloe Raines
- Chloe Weber
- Chris Bevan
- Chris Chancellor
- Chris Dunn
- Chris Flagstad
- Chris Frost
- Chris Garcia
- Chris Harvey
- Chris Headley
- Chris Lyons
- Chris Stinson
- Christa Judkins
- Christian Dowson
- Christian Labarta
- Christian Snider
- Christina Marshall
- Christine Avory
- Christine Olive
- Christoper Estep
- Christoph Crowe
- Christoph Fox
- Christopher Ackles
- Christopher Brooks
- Christopher Fleming
- Christopher Gunn
- Christopher Jenkins
- Christopher Keegan
- Christopher Pullen
- Christopher Rhoades
- Christopher Zimmer
- Chuck Armstrong
- Chuck Lancaster
- Chung Currier
- Ciera Bracken
- Cierra Cowell
- Cindy Featherstone
- Citlali Gooding
- Clair Moeller
- Claire Miller
- Clancy Knightley
- Clara Bennett
- Clara Brooks
- Clara Collins
- Clara Fanning
- Clara Farrow
- Clara Harris
- Clara Nesbit
- Clara Perry
- Clara Wallace
- Clara Walter
- Clarence Richmond
- Clark Dawson
- Clark Hiddleston
- Clark Hubert
- Clark Porter
- Claud Way
- Claude McMillan
- Claudia Simmons
- Clavin Wilkinson
- Clayton Fernandez
- Clayton Fisher
- Clayton Murphy
- Clayton Powell
- Clayton Turpin
- Clement Causey
- Clemente Gamez
- Cleo Kahn
- Cletus Schilling
- Clifford Boudreau
- Clifford Moody
- Clifford Short
- Clifton Coughlin
- Clint Giffen
- Clinton Selby
- Clive Flint
- Clive Jarvis
- Clive Koelling
- Clyde Johnson
- Coby Fleming
- Coby Hawkins
- Codie Horton
- Cody Long
- Cody Perez
- Cohen Bell
- Colby Blair
- Colby Gunn
- Colby Smith
- Colby Whedon
- Cole Gray
- Cole Smith
- Cole Wilson
- Coleman Whiting
- Colin Davenport
- Colin Ryder
- Colin West
- Collin Cruz
- Collin Goff
- Collin Markham
- Collin Shephard
- Colman Livingston
- Colt McGarry
- Colt Rico
- Colten Grissom
- Colton Easton
- Colton Scarborough
- Conard Nash
- Conelth Dickerson
- Conner Bale
- Conner Casini
- Conner Long
- Connie Freeman
- Connie Mcguire
- Connor Artis
- Connor Butler
- Connor Harper
- Connor Jenkins
- Connor Smith
- Connor Wilson
- Conor Graf
- Conor Suarez
- Conrad Menard
- Conrad Sinclair
- Constance Stanton
- Conway Fletcher
- Cora Bailey
- Cora Lancester
- Corbin Spencer
- Cordelia Edwards
- Cordelia Owen
- Corey Aiken
- Corey Harrelson
- Corey Reid
- Corey Valentine
- Cornell Waggoner
- Cortez Ford
- Cory Bunn
- Cory Simmons
- Cory Young
- Courtney Hoover
- Courtney Landon
- Courtney Mahan
- Courtney Silver
- Craig Cain
- Craig Smith
- Craig Steward
- Craig Zodikoff
- Crew Simpson
- Cristian Taylor
- Cristiano Shepherd
- Cristin Maxfield
- Cristobal Gooden
- Cruz Hawkins
- Cruz Trout
- Crystal Quillen
- Curtis Carson
- Curtis Clark
- Curtis Cryer
- Curtis Holmes
- Curtis Osborne
- Curtley Berg
- Cyaden Ross
- Cynthia Jefferson
- Cynthia Scribner
- Cynthia Wison
- Cyril Barnett
- Cyril Goode
- Cyrilo Harris
- Cyrus Hank
- Cyrus Holt
- Cyrus Schneider
- Dahlia Walton
- Daisy Clarke
- Daisy Leon
- Daisy Mathews
- Daisy Truman
- Daivik Wani
- Daiwik Jha
- Daiwik Mittal
- Dakota Beckett
- Dakota Gannon
- Dakota Marshall
- Dakota Owen
- Dakota Rooney
- Dakota Schmitt
- Dakota Tallent
- Daksh Jaipal
- Daksh Kaul
- Daksh Malhotra
- Daksh Rai
- Daksh Suri
- Daksha Chaudhary
- Dakshin Kapoor
- Dakshit Madan
- Dalajit Suri
- Dalbir Somal
- Dale Saunders
- Dale Sullivan
- Dallas Bollinger
- Dallas Bowman
- Dallas Lynch
- Dallas Rivera
- Dalton Freeman
- Dalton Higgins
- Dalton Howie
- Dalton Wesley
- Damian Price
- Damian Wayne
- Damien Gordon
- Damien Miller
- Damien Montgomery
- Damien Newman
- Damien Sisk
- Damini Subramanian
- Damodar Sethi
- Damon Ackroyd
- Dan Espinoza
- Dan Heller
- Dandre Cason
- Dane Donald
- Dangelo Mize
- Danice Coy
- Daniel Anderson
- Daniel Brody
- Daniel Campbell
- Daniel Enger
- Daniel Galea
- Daniel Livingston
- Daniel McGuire
- Daniel Moore
- Daniel Ross
- Daniel Santiago
- Daniel Scott
- Daniel Sullivan
- Daniel Walker
- Daniel White
- Daniel Willson
- Daniella Riggs
- Danielle Hair
- Danielle Pratt
- Danik Kishore
- Danish Malik
- Danna Carson
- Danna Herrin
- Dannie Paxton
- Danny Chapman
- Danny Fuller
- Danny Rennie
- Danny Rockwell
- Dante Banks
- Dante Boyd
- Daphne Hopkins
- Daphne Horton
- Darell Crowder
- Darell Hyman
- Darian Dyson
- Dariel Wyatt
- Darien Leyva
- Darika Sahni
- Darion Gilchrist
- Darius Salvador
- Darlene Lew
- Darman Sehgal
- Darmik Saini
- Darnell Pickering
- Darpan Puri
- Darpan Seth
- Darpana Chauhan
- Darpanika Singh
- Darpita Swami
- Darrell Montanez
- Darren Erickson
- Darren Wang
- Darrick Steen
- Darrius Unger
- Darryl Delatorre
- Darsan Chauhan
- Darsh Sachdev
- Darsh Sharma
- Darshan Neela
- Darshika Joshi
- Darshini Iyer
- Darshini Parsad
- Darshish Veena
- Darshita Manju
- Darshni Dutta
- Daryl Dane
- Dashawn Nielson
- Dave Clark
- Dave Hensley
- Dave Stewart
- Dave Whittaker
- David Beaty
- David Bonham
- David Chilton
- David Cooke
- David Crow
- David Hall
- David Hartnoll
- David Householter
- David Irvine
- David McCartney
- David Norman
- David Pruitt
- David Rhodes
- David Robles
- David Ross
- David Simmons
- David Young
- Davin Monahan
- Davinder Sidhu
- Davinderjot Sudha
- Davis Twomey
- Davon Bartholomew
- Davon Matthews
- Dawson Coffey
- Dawson Walker
- Daxton Jason
- Dayana Schreiner
- Dayton Kang
- Deakshit Raman
- Dean Griffin
- Dean Hovey
- Dean Shell
- Dean Watson
- Deanna Terrill
- Deb Willis
- Debajit Changmai
- Debashree Mittal
- Debasmita Roy
- Debasmita Saikia
- Debbie Harms
- Debby Ascroft
- Deblina Sen
- Debolina Rai
- Deborah Black
- Deborah Clooney
- Deborah Edwards
- Declan Bayer
- Declan Hernandez
- Declan Hicks
- Deeksha Bhatia
- Deeksha Sahni
- Deekshana Lalit
- Deenabandhav Saini
- Deep Gandhi
- Deepa Verma
- Deepaansh Mohan
- Deepak Kapadia
- Deepak Shankar
- Deepak Upadhyay
- Deepalakshmi Soni
- Deepali Gokhale
- Deepali Kaur
- Deepali Yadav
- Deepanjali Parsad
- Deepankar Punj
- Deepanshu Ahluwalia
- Deepanshu Chauhan
- Deepanshu Juneja
- Deepaprabha Manju
- Deepashree Majumdar
- Deependra Narang
- Deepika Nadar
- Deepika Tyagi
- Deepika Verma
- Deepinder Srivastava
- Deepmala Rastogi
- Deepmohan Bhatt
- Deepshikha Sharma
- Deepshikha Singh
- Deepta Rai
- Deeptesh Kapoor
- Deepti Batra
- Deepti Chandra
- Deepti Palan
- Deepti Rai
- Deepti Sudha
- Deepti Verma
- Deeptimoy Lal
- Delaney Dominquez
- Delbert Wolf
- Delilah Erickson
- Delilah Kinsley
- Delilah Murdock
- Delilah Quinn
- Delmer Amaya
- Demarcus Hummel
- Demetrius Augustine
- Demi Wright
- Denis Bauman
- Denise Lopez
- Denise Russo
- Denisse Howes
- Dennis Cameron
- Dennis Clanton
- Dennis Close
- Dennis Goetz
- Dennis Hanks
- Dennis Rankin
- Dennis Williamson
- Denny Harper
- Denver Dickson
- Denver Rutherford
- Denver Sosa
- Deon Liles
- Dephne Rowland
- Derek Beaven
- Derek Kennedy
- Derek Pearce
- Derek Portman
- Derek Whipple
- Derick Hudson
- Derrick Newberry
- Deshaun Willey
- Deshawn Coe
- Desmond Ballard
- Desmond Gaskins
- Dev Bhatt
- Dev Mandal
- Deva Anand
- Devabrata Kapoor
- Devadutt Prasad
- Devaj Subramanian
- Devajyoti Subramanian
- Devaki Kumar
- Devakumar Roy
- Devamadana Sen
- Devanand Pawan
- Devansh Arora
- Devansh Sehgal
- Devanshi Gupta
- Devanshi Yadav
- Devarsi Darsha
- Devashish Mehra
- Devashish Naran
- Devashri Puri
- Devayani Lata
- Devender Dhawan
- Devendra Kumar
- Devendra Saxena
- Devesh Singh
- Devguru Punj
- Devika Chaudhary
- Devilaal Dutta
- Devilal Prakash
- Devin Burns
- Devin Lamar
- Deviprasad Narang
- Devisha Shankar
- Devon Corwin
- Devon Mattingly
- Devonte Radford
- Devyani Chhabra
- Devyn Heyward
- Dewayne Hopper
- Dewitt Parris
- Dexter Harvard
- Dexter Rose
- Dhanya Deep
- Dhara Manne
- Dharmesh Kumar
- Dheeraj Suri
- Dhriti Chadha
- Diago Bell
- Diana Bates
- Diana Lucas
- Diana Magnuson
- Diana Marks
- Diana Pollard
- Diane Anderson
- Diane Jeffers
- Diane Mckeon
- Dianne Maxwell
- Dick Baia
- Diego Laughlin
- Diego Wells
- Digvijay Das
- Dillon Graham
- Dimitri Paris
- Dinah Beck
- Dinesh Kanojia
- Dinesh Malhotra
- Dinesh Raman
- Dinesh Solanki
- Dinesh Verma
- Dion Beaulieu
- Dirk Hacker
- Disha Banerjee
- Disha Reddy
- Divit Bhasin
- Divya Singhania
- Dmitri Ivazov
- Dmitry Hofland
- Dollie Gibson
- Domenic Leggett
- Dominic Brady
- Dominic Burdick
- Dominic Cameron
- Dominic Fasso
- Dominic Ford
- Dominic Patterson
- Dominic Pratt
- Dominic Shaw
- Dominic Tate
- Dominick Dowling
- Dominick Pereira
- Dominik Vanwinkle
- Dominique Killian
- Dominique Salgueiro
- Dominique Speight
- Dominque Craft
- Don Boles
- Donald Aspey
- Donald Coleman
- Donald Cronin
- Donald Maxmilian
- Donald Murphy
- Donald Nash
- Donald Peterson
- Donald Ponder
- Donald Vincent
- Donald Wilkins
- Donna Braverman
- Donna Davis
- Donna Tapoi
- Donna Thompson
- Donnell Chastain
- Donnie Stallone
- Donovan Crawford
- Donovan Douglas
- Donovan Linn
- Dontae Spain
- Donte Beverly
- Doreen Rowe
- Dorian Hill
- Dorian Snyder
- Dorothea West
- Dorothy Evans
- Dorothy Green
- Dorothy Rambola
- Dorsey Lopes
- Douglas Barnett
- Douglas Cobb
- Douglas Holliday
- Douglas Irizarry
- Douglas Rodriquez
- Douglas Schwartz
- Douglas Severs
- Douglas Stewart
- Douglas Suarez
- Dr. G. C. R. Jaiswal
- Dr. Javid A. Parray
- Dr. Nirja Singh
- Dr. Ranjeet Kr Singh
- Dr. Satish Kumar S. Hosamani
- Dr. Sridevi J.
- Dr. Suhaib A. Bandh
- Drake Baldwin
- Drake Koch
- Drake Ward
- Dravin Rager
- Drew Adams
- Drew Bentley
- Drew Christie
- Drew Farmer
- Drew Morgan
- Drishti Srivastava
- Duke Jefferson
- Duke Todd
- Duncan Felix
- Duncan Loyns
- Duncan Milner
- Duncan Sellers
- Durga Nair
- Dushyant Dev
- Dushyant Verma
- Dustin Campbell
- Dustin Cook
- Dustin Joseph
- Dustin Knox
- Dusty Cagle
- Dwain Stoddard
- Dwanyne Winfield
- Dwight Cowan
- Dwight Mabry
- Dwight Parcher
- Dwyane Mason
- Dylan Carter
- Dylan Glover
- Dylan Hill
- Dylan Kilmer
- Dylan Long
- Dylan Pruett
- Earl Bermann
- Earl Conley
- Earl Duncan
- Earle Littlejohn
- Earnest Nugent
- Eashan Nath
- Eashana Aggarwal
- Eashav Malhotra
- Eashita Prasad
- Easton Nicholson
- Ed Diego
- Ed Welch
- Eddie Dillon
- Eddie Rocco
- Eddy Kimbrough
- Eden Conte
- Eden Dennis
- Eden Rutherford
- Eden Sparks
- Eden Wilkins
- Eden Witherspoon
- Edgar Crombie
- Edgar Miller
- Edgar Minton
- Edgar Warren
- Edgar Weston
- Edgar Wilson
- Edgardo Turner
- Edison Murry
- Edith Moran
- Edith Powell
- Edith Ross
- Edmond Thor
- Edmund Parker
- Eduardo Hanks
- Eduardo Raymond
- Eduardo Riley
- Eduardo Robinson
- Edward Ackles
- Edward Clark
- Edward Clarke
- Edward Felch
- Edward France
- Edward Grace
- Edward Haighes
- Edward Hayden
- Edward May
- Edward Osborne
- Edward Pepper
- Edward Pollock
- Edward Sommer
- Edward Thomas
- Edwin Bowers
- Edwin Keeler
- Edwin McGregor
- Edwin Parks
- Edwin Roman
- Edwin Tan
- Edwin Vance
- Edwina Orion
- Edwina Weaver
- Eeksha Raje
- Eenakshi Vijaya
- Eesha Menon
- Eeshan Kapoor
- Eeshika Rana
- Eeshta Mittal
- Effie Ross
- Ehsaan Roy
- Ehsaas Nara
- Eijaj Moradi
- Eira Buchanan
- Ekaakshara Bhatt
- Ekaant Chande
- Ekaant Kapoor
- Ekachit Pal
- Ekadant Verma
- Ekagra Subramanian
- Ekansh Kumar
- Ekant Bhatt
- Ekanta Patel
- Ekendra Srini
- Eknaath Rai
- Ekraj Shan
- Ekta Dubey
- Ela Dean
- Elaina Hiller
- Elaine Lashley
- Elaine Pitlik
- Elbert Bullock
- Elden Torrez
- Eldon Miller
- Eldra Lipton
- Eleanor Clark
- Eleanor Cooper
- Eleanor Flores
- Eleanor Holmes
- Eleanor McCarthy
- Eleanor Pardo
- Elen Downey
- Elena Gregory
- Elena Norris
- Elena Poole
- Elena Tinker
- Eli Ellis
- Eli Lewis
- Eli Medley
- Elia Webster
- Elian Massey
- Eliana Copeland
- Elias Bennett
- Elias Foster
- Elias Hawksley
- Elias Zimmer
- Elijah Baxter
- Elijah Brown
- Elijah Collins
- Elijah Cooper
- Elijah Diego
- Elijah Grant
- Elijah Jones
- Elijah Walker
- Elina Stevens
- Eliot Fox
- Elisabeth Crawford
- Elisabeth Enright
- Eliseo Squires
- Elisha Franks
- Eliza Greene
- Eliza Lightner
- Eliza Long
- Eliza Melton
- Eliza Morgan
- Elizabeth Burns
- Elizabeth Lamb
- Elizabeth Lloyd
- Elizabeth Orozco
- Elizabeth Robins
- Elizabeth Swinton
- Elizabeth Welch
- Ella Corbyn
- Ella Hunter
- Ella Keller
- Elle Holmes
- Ellen Bolling
- Ellen Buckley
- Ellen Redman
- Ellie Bennett
- Ellie Coppola
- Ellie Cox
- Ellie Green
- Ellie Legrand
- Ellie Peyton
- Ellie Rogers
- Ellie Ward
- Elliot Alonzo
- Elliot Bishop
- Elliot Franco
- Elliot Jenkins
- Elliot Miller
- Elliot Peters
- Elliott Flanagan
- Ellis Anderson
- Ellis Baker
- Ellis Beyer
- Ellis Simmons
- Elmer Dowse
- Elora Hall
- Elora Melton
- Elouise Watt
- Eloy Lentz
- Elsa Cooper
- Elsa Holt
- Elsa Hunt
- Elsie Collins
- Elsie Perkins
- Elton Gilchrist
- Elvis Green
- Elvis Rosenthal
- Elyana Harold
- Emanuel Bell
- Emanuel Patterson
- Ember Chisholm
- Emely Leeper
- Emerson Chester
- Emerson Dunlap
- Emerson Haynes
- Emerson Markley
- Emery Denson
- Emilee Mcdade
- Emilia Farrell
- Emilia Ferguson
- Emilia Stones
- Emiliano Johnston
- Emiliano Redd
- Emilie Reinhart
- Emilio McMahon
- Emily Blundetto
- Emily Cooper
- Emily Howling
- Emily Jones
- Emma Affleck
- Emma Darling
- Emma Davos
- Emma Fowler
- Emma Layer
- Emmanuel Craig
- Emmanuel Harman
- Emmett Davila
- Emmett Gonzalenz
- Emmett Norton
- Emmett Ring
- Emmett Sloan
- Emmitt Beebe
- Emmy Hamilton
- Emory Weller
- Enoch Coles
- Enrique Preston
- Enzo Archer
- Eric Astwell
- Eric August
- Eric Buchanan
- Eric Gilbert
- Eric Martin
- Eric Richardson
- Eric Saunders
- Eric Stiles
- Erica Helmer
- Erica Kubale
- Erica Young
- Erich Beaton
- Erich Cavazos
- Erick Kitchen
- Erik Hamilton
- Erik Madsen
- Erik Pierre
- Erik Stearns
- Erika De Smet
- Erika Lindgren
- Erika Tanner
- Erin Butcher
- Erin Doe
- Erin Faulkner
- Erin Manzo
- Erina Sullivan
- Ernest Railey
- Ernest Simmonds
- Ernesto Hillman
- Erwin Luke
- Esha Singh
- Esha Wadhwa
- Eshani Rai
- Esme Morris
- Esmeralda Jackson
- Esmeralda Passmore
- Esperanza Rigby
- Estefani Vanburen
- Estelle Jones
- Estelle Matthews
- Estelle Watson
- Estevan Mattson
- Esther Henson
- Esther Randall
- Esther Sinclair
- Estrella Collado
- Ethan Becerra
- Ethan Davies
- Ethan Evans
- Ethan Feng
- Ethan Lewis
- Ethan Scott
- Ethan Snyder
- Ethan Wilson
- Ethen Ivy
- Eugene Bradley
- Eugene Perry
- Eugene Pressley
- Eugene Richards
- Eugene Strange
- Eusebio Mallory
- Eva Fitzgerald
- Eva Murphy
- Eva Sandler
- Evalyn Abbott
- Evalyn Murray
- Evan Adams
- Evan Blair
- Evan Carter
- Evan Green
- Evan Rector
- Evan Riley
- Evan Ryan
- Evangeline Cruz
- Evangeline Dawson
- Eve Versuh
- Evelin Fries
- Evelyn Cox
- Evelyn Cross
- Evelyn Howard
- Evelyn Radford
- Evelyn Rogers
- Everett Bailey
- Everett Davies
- Everett Vogel
- Everette Hoff
- Everly Fanshawe
- Everlyn Graham
- Evie Barnes
- Evie Davidson
- Evie King
- Ewan Lewis
- Ewan Rankin
- Ewen Murray
- Ezekiel Chapman
- Ezekiel Clarke
- Ezekiel Dickson
- Ezekiel Russ
- Ezequiel Worthington
- Ezra Busch
- Ezra Duncan
- Ezra Fisher
- Ezra Flores
- Ezra Hayden
- Ezra Martin
- Ezra Samberg
- Faalguni Singh
- Faareh Rashid
- Faatima Rafiq
- Fabian Kent
- Fabian McLain
- Fabian Wilburn
- Fabiola Hyland
- Fahad Qasim
- Fahima Rashid
- Faith Battye
- Faith Lowman
- Faith Miller
- Faith Sherman
- Faizal Qadri
- Fakhir Mirza
- Falak Malik
- Falgun Kishore
- Falguni Jindal
- Falguni Puri
- Falicia Radcliff
- Fanindra Sen
- Farah Riaz
- Fardeen Mir
- Farheen Mohammad
- Farrell Waltz
- Faruq Majid
- Fathima Rehmann
- Fatima Kazmi
- Fatima Merriman
- Fatima Saab
- Fausto Gallardo
- Fay McGuire
- Fayaz Ahmad
- Fayyaz Bakhtiyar
- Fayzel Azad
- Federico Barger
- Felicia Peltier
- Felicity Darko
- Felicity Salerno
- Felipe Crook
- Felix Hamilton
- Felix Jenkins
- Felix Pope
- Felix Priestley
- Felix Regan
- Felix Rohmer
- Felix Sampson
- Felton Boyles
- Ferdinand Hawthorne
- Fergus Pearson
- Fernanda Spriggs
- Fernando Hogan
- Fernando Lind
- Fernando Morrison
- Fernando Plath
- Feroz Shaikh
- Fidel Avalos
- Finley Allison
- Finley Bradley
- Finley Bush
- Finley Carver
- Finley Edwards
- Finn Cleverley
- Finn Cullen
- Finn Graham
- Finn Miller
- Fiona Allen
- Fiona Browning
- Fiona Hobbs
- Fiona Palmer
- Firoj Alam
- Firoz Sheikh
- Fletcher Sorenson
- Fleur Marshall
- Flora Duffy
- Florence Barnes
- Florence Hall
- Florence Webb
- Florencio Daigle
- Floriana Crawford
- Floyd Freemont
- Floyd Wills
- Flynn Hayes
- Flynn Stevenson
- Frances Metzger
- Francesca Barela
- Francesca Hopkins
- Francesco Morton
- Francis Collins
- Francis Fletcher
- Francis Jacob
- Francis Joyce
- Francis Kenning
- Francis Lawrence
- Francis Rose
- Francis Schmidt
- Francisca Cameron
- Francisco Armstrong
- Francisco Gordon
- Francisco Peralta
- Francisco Watkins
- Frank Bailey
- Frank Cohen
- Frank Elliott
- Frank Kern
- Frank Kesley
- Frank Shiner
- Frank West
- Frankie Casey
- Franklin Burton
- Franklin Coyle
- Franklin Jackson
- Franklin Manser
- Franky Hunter
- Fraser Barrett
- Fraser Cox
- Frazer Murphy
- Fred Acosta
- Fred Byron
- Fred Cole
- Fred Dubose
- Fred Roberts
- Fred Warren
- Freddie Barnett
- Freddie Casey
- Freddie Elliot
- Freddie Harris
- Frederick Ezell
- Frederick Gates
- Frederick Gibson
- Frederick Green
- Frederick Nash
- Fredric Huang
- Fredricka Hofmann
- Freya Ball
- Freya Denwood
- Freya Rankin
- Frida Brill
- Frieda Bush
- Fritz Loomis
- Fulvio Valsangiacomo
- Gabe Burton
- Gabriel Austin
- Gabriel Craig
- Gabriel Gibson
- Gabriel Henderson
- Gabriel Lucas
- Gabriel Murray
- Gabriel Tyler
- Gabriel Woodard
- Gabriela Buchan
- Gabriele Cox
- Gabriele Schenk
- Gabriella Becker
- Gabriella Durand
- Gabriella Goodwin
- Gabrielle Gonsalves
- Gabrielle Morgan
- Gael Martin
- Gagan Kishore
- Gagandeep Joshi
- Gage Grant
- Gage Sams
- Gagnesh Bhatt
- Gagnesh Joshi
- Gail Benson
- Gajdant Aggarwal
- Gajendra Chaudhary
- Gajendra Patel
- Gajendra Vijaya
- Gajendranath Pal
- Gajrup Goel
- Gajvadan Rai
- Gale Foote
- Gambheer Lal
- Gambheer Pal
- Gandhar Nagpal
- Gandhari Gupta
- Gandharv Kumar
- Gandharva Lal
- Gandharva Rai
- Ganesh Chander
- Ganesh Hari
- Ganesh Jai
- Ganesh Shinde
- Ganeshan Rai
- Ganga Mittal
- Gangaa Datt
- Gangesha Chaturvedi
- Ganik Kumar
- Ganisha Srini
- Ganjan Verma
- Gannon Bourgeois
- Gannon Curran
- Ganpat Mittal
- Garima Chaudhary
- Garima Malik
- Garima Prasad
- Garima Sethi
- Garima Soni
- Garisht Kapoor
- Garjan Mittal
- Garnett Carper
- Garret Shearer
- Garrett Cooper
- Garrett Donovan
- Garrett Hoffman
- Garrett Taylor
- Garrick Davenport
- Garry Dove
- Garry Hollis
- Garv Chaudhary
- Gary Baker
- Gary Garcia
- Gary Hansen
- Gary Hutchinson
- Gary Lopez
- Gary Payton
- Gaurab Sriniwas
- Gaurabh Kumar
- Gaurang Lalit
- Gaurang Rana
- Gaurav Charan
- Gaurav Lalit
- Gaurav Randhawa
- Gaureesh Mehta
- Gaureesh Patel
- Gauresh Sara
- Gauri Jain
- Gauri Naath
- Gauri Rana
- Gauri Sikri
- Gaurinath Nirmal
- Gaurish Pawan
- Gautam Lakhan
- Gautam Mehta
- Gautami Sinha
- Gavin Collingwood
- Gavin McKee
- Gavin Moore
- Gavin Prescott
- Gavin White
- Gavisht Sehgal
- Gavistha Nirmal
- Gayan Manohar
- Gayatri Anand
- Gayatri Goswami
- Gayatri Krishnan
- Gayatri Menon
- Gayle Doran
- Gayle Jerome
- Gaynelle Michels
- Gearldine Orton
- Geeta Reddy
- Geeta Sharma
- Geetanjali Reddy
- Geetanka Behl
- Geeth Malik
- Geetham Sehgal
- Gema Reiss
- Gemma Toscano
- Gene Saxe
- Gene Tilley
- Genesis Nickel
- Genevive Dabbs
- Genia Dingle
- Geoff Dyer
- Geoff Gedye
- Geoffrey Gilbert
- Geoffrey Romero
- Geoffrey Watkins
- Geoffrey Williamson
- Geoffrey Wright
- George Armstrong
- George Brown
- George Cousins
- George Delong
- George Dickens
- George Firth
- George Freeman
- George Gardner
- George Hamill
- George Milton
- George Moore
- George Pilato
- George Rivera
- George Singer
- George Thomson
- George Willis
- Georgene Oquendo
- Georgette Paulson
- Georgia Diaz
- Georgia Pattinson
- Georgia Raynor
- Georgiana Mason
- Georgiana Webster
- Georgiann Bettencourt
- Georgianne Creed
- Georgie Cushing
- Gerald Asher
- Gerald Astley
- Gerald Atkins
- Gerald Brooks
- Gerald Cole
- Gerald Davies
- Gerald Gayle
- Gerald Kennedy
- Gerald Paterson
- Geraldo Woodall
- Gerard Comer
- Gerard Power
- Gerardo Bailey
- Gerardo Reaves
- Gerri Rome
- Gersham Levitt
- Gertude Fannin
- Ghanashyam Nirmal
- Ghanshyam Muthu
- Giani Smith
- Gianna Cochrane
- Gianna Watson
- Gideon Allen
- Gideon Schmidt
- Gideon Waddell
- Gidget Haddad
- Gigi Leboeuf
- Gil Kruse
- Gil Merrill
- Gilbert Knowles
- Gilbert Mead
- Gilbert Medrano
- Gilberto Hutton
- Gildroy Swan
- Giles Watkins
- Gilma Santoro
- Gina Simpson
- Gina Trombley
- Ginny Clouse
- Gino Means
- Giorgio Salati
- Giovanna Conger
- Giovanni North
- Giovanni Skaggs
- Giovanny Bruner
- Gira Kapoor
- Giri Sahni
- Giribal Soni
- Giridhar Mehra
- Girik Sai
- Girindra Swami
- Giriraj Subram
- Girish Goyal
- Girish Sachdev
- Girivar Sehgal
- Girvaan Saini
- Girvaan Uddas
- Gisela Crumpton
- Gisele Fowlkes
- Giselle Boyle
- Giselle Dortch
- Giselle Tang
- Gisselle Eagle
- Gita Goswami
- Gita Kalita
- Gita Kersey
- Gitanjali Barua
- Gladis Moten
- Glayds Robledo
- Glen Parr
- Glenden Kaye
- Glendora Windsor
- Glenn Bateson
- Glenn Rogers
- Glenna Bechtel
- Glennis Catlett
- Glinda Chiu
- Gloria Doran
- Gloria Geer
- Gloria Nisbet
- Glynn Clermont
- Gobinath Rajagopal
- Gobinda Nagpal
- Golden Rhyne
- Goldfrey Edwards
- Gopal Asthana
- Gopalakrishnan Kumar
- Gopi Sudha
- Gopikrishna Tyagi
- Gopiram Kumar
- Gordon Hart
- Gordon Hurley
- Gouri Reddy
- Goutam Utsal
- Govind Pal
- Govind Raj
- Govind Subramanian
- Govinda Bhatt
- Govindaraj Rastogi
- Govindaraju Bhatt
- Gowrish Sudha
- Grace Chapman
- Grace Hanson
- Grace Justus
- Grace McCoy
- Grace Paisley
- Grace Parks
- Grace Petrie
- Grace Silva
- Gracie Adams
- Gracie McKinley
- Gracie-Mae Collins
- Graciela Nall
- Graham Attrill
- Graham Eanes
- Graham Jones
- Graham Molloy
- Grant Harper
- Grant Paterson
- Grayson Barker
- Grayson Cliff
- Greg Callister
- Greg Mayhew
- Greg Powell
- Gregorio Paulson
- Gregory Allred
- Gregory Rago
- Gregory Rawlings
- Grenn Jones
- Greta Marshall
- Gretchen Flammer
- Gretchen Kenney
- Greyson Albinson
- Greyson Blackman
- Griffin Cook
- Griffith Reid
- Grover Rubin
- Gruff Carlson
- Guillermina Salyer
- Guillermo Dutton
- Gulam Husain
- Gulzar Momin
- Gulzarilal Ansari
- Gunakar Chander
- Gunasekar Anand
- Gunasekaran Aggarwal
- Guneet Jain
- Gunin Deka
- Gunther Faulkner
- Gunvant Malhotra
- Gunvant Rajagopal
- Gurbaksh Joshi
- Gurbinder Bains
- Gurdayal Suri
- Gurdeep Dhawan
- Gurdeep Kumar
- Gurjas Aggarwal
- Gurjinder Kang
- Gurmeet Anand
- Gurmukh Malhotra
- Gurnam Kapoor
- Gurpreet Malhotra
- Gurpreet Mann
- Gurpreet Nanda
- Guru Dabral
- Guru Lal
- Gurubachan Lal
- Gurucharan Kishore
- Gurudeva Sharma
- Gurudutt Jai
- Gurumurthi Pal
- Gururaj Goel
- Gurvinder Nath
- Gus Winters
- Gussie Sellars
- Gustav Solomon
- Gustavo Cobb
- Guy Lennon
- Gwen Bond
- Gwen Smith
- Gwen Tracey
- Gwenda Boyette
- Gweneth Hopkins
- Gwenn Camara
- Gwyn Deyoung
- Gyan Chand
- Gyan Nara
- Gyandev Kapoor
- Haarsh Lal
- Hadley Blankenship
- Hae Hixson
- Hailee Stitt
- Haley Adison
- Halley Mclane
- Hallie Hartwell
- Hallie McHugh
- Halsey Parkinson
- Hamish Pollock
- Hamza Benavides
- Hamza Lowe
- Hanima Kapoor
- Hank Cathcart
- Hank Loris
- Hanna Matney
- Hannah Cummins
- Hannah Palmer
- Hannah Seabrook
- Hannah Wells
- Hans Affleck
- Hans Parson
- Hans Roth
- Hansa Devi
- Hanshika Verma
- Hansika Sethi
- Hansini Malik
- Hardeep Pawar
- Hardik Charan
- Hardik Johar
- Harendra Kapoor
- Harendra Nirmal
- Haresh Pawan
- Hareshwar Manohar
- Hari Kumar
- Hari Rajan
- Hari Rao
- Hari Sahni
- Haricharan Sehgal
- Haridev Saini
- Harigopal Janardhan
- Harihar Darsha
- Harilal Chauhan
- Harina Swami
- Harinder Kaushik
- Harindranath Joshi
- Harini Kapoor
- Haripreet Veena
- Haripriya Das
- Hariraj Sahni
- Haris Russell
- Harish Purohit
- Harish Shetty
- Harishankar Reddy
- Harita Srivastava
- Harjinder Pannu
- Harjit Deol
- Harjit Kahlon
- Harley Osteen
- Harley Reynolds
- Harley Wells
- Harmanpreet Kaur
- Harmeet Chhina
- Harmendra Srivastav
- Harmony Ledger
- Harmony Raley
- Harold Finley
- Harold Herrera
- Harold Olson
- Harold Salazar
- Harold Snook
- Harpal Dhaliwal
- Harper Amesbury
- Harper Newman
- Harpreet Bawa
- Harriet Bennett
- Harriet Hughes
- Harriet Jacobs
- Harriet Olsen
- Harriet Sawyer
- Harriet Schmidt
- Harriet Tindall
- Harriet Turner
- Harrison Bastock
- Harrison Campbell
- Harrison Cox
- Harrison Howard
- Harrison Jennings
- Harrison Palmer
- Harrison Sheldon
- Harrison Woods
- Harry Adair
- Harry Bailey
- Harry Jones
- Harry Wilson
- Harry Winkler
- Harsh Goyal
- Harsh Malhotra
- Harsha Kaur
- Harsha Trivedi
- Harshad Raje
- Harshada Chander
- Harshala Chaudhary
- Harshat Gairola
- Harshika Rana
- Harshika Sethi
- Harshit Anand
- Harshita Pant
- Harshita Raj
- Harshita Suri
- Harshvardhan Sai
- Harsita Ghose
- Haruni Choudhary
- Harv Kennedy
- Harvey Elliot
- Harvey Graham
- Harvey Knight
- Harvey O'Brien
- Harvey Parker
- Harvey Reid
- Harvey Richardson
- Harvey Rogers
- Harvey Summers
- Harvey Wilson
- Harvinder Deol
- Harvinder Sodhi
- Hasan Mansoor, Kamalkant Mathur
- Hasina Mohammad
- Hasmukh Lal
- Hasmukh Sehgal
- Hassan Judd
- Hasti Rana
- Hayden Cole
- Hayden Nickerson
- Hayley Aiello
- Hazel Lambert
- Hazel Nelson
- Hazel Nygel
- Hazel Saunders
- Heath Cobb
- Heath Howard
- Heath Salter
- Heather Dale
- Heather Fusco
- Heather Leonard
- Heather Moore
- Heather Morrison
- Heather Murphy
- Heather Stevenson
- Heather Wright
- Hector Carling
- Hector Hammer
- Hector Lamb
- Hector Moura
- Hector Nicolson
- Hedy Maple
- Heena Narula
- Heidi Hamlin
- Heidi Howerton
- Heidi Lee
- Heidi Mueller
- Heidi Pratt
- Heike Settles
- Helen Hayden
- Helen Mann
- Helen Stevenson
- Helena Shelton
- Helena Walker
- Hellen Boettcher
- Hema Bisht
- Hema Pillai
- Hema Sharma
- Hemachandra Roy
- Hemalatha Nirmal
- Hemang Juneja
- Hemang Sahni
- Hemangini Chauhan
- Hemant Kandwal
- Hemant Patel
- Hemanth Bansal
- Hemanth Desai
- Hemanth Kumar
- Hemanth Mehta
- Hemanth Rao
- Hemanthi Sharma
- Hemaraj Muthu
- Hemendra Desai
- Hemlata Krishnamurthy
- Hemlata Talukdar
- Hendrik Medina
- Hendrix Zachary
- Henrietta Koonce
- Henrik Olsen
- Henry Allen
- Henry Booth
- Henry Brosnan
- Henry Carden
- Henry Collier
- Henry Evans
- Henry Martin
- Henry Martinez
- Henry Medina
- Henry Robinson
- Henry Stamp
- Henry Wang
- Henry Webber
- Herb Connell
- Herbert Benn
- Herbert Buchanan
- Herbert Diaz
- Herbert Dunda
- Herbert Dundas
- Herbert Lotus
- Herbert McCoy
- Hermelinda Luong
- Hermina Pender
- Herminia Sanches
- Hershel Looney
- Hester Aguayo
- Hetal Acharya
- Hetal Raghuwanshi
- Hien Bucher
- Hilary Deberry
- Hildegard Hoke
- Hildegarde Lees
- Hillary Duncan
- Hillary Narvaez
- Hillary Newland
- Himaadri Narang
- Himaanshu Naran
- Himabindu Veer
- Himadri Samuel
- Himaghna Srivastava
- Himank Srivastav
- Himansh Saini
- Himanshu Tripathi
- Himisha Grewal
- Hinata Kenshin
- Hiroko Sandberg
- Hiten Ambani
- Hiten Makhija
- Hiten Vashisht
- Hitendra Patil
- Hitesh Mehta
- Hitesh Shetty
- Hoa Brazil
- Holden Clark
- Holden Ray
- Hollie Montgomery
- Hollis Gilbreath
- Holly Dunham
- Holly Lambert
- Holly Mckeever
- Holly Philips
- Homer Gagne
- Hope Miller
- Horace Dawson
- Hortense Nakamura
- Howard Currant
- Howard Wu
- Howard Zea
- Hridayanath Singh
- Hrithik Choudhary
- Hubert Parks
- Hubert Reeve
- Hudson Fox
- Hudson Pettit
- Hudson Rees
- Hudson Warner
- Hue Appel
- Huey Witherspoon
- Hugh Brennan
- Hugh Colley
- Hugh Melville
- Hugh Patmore
- Hugh Waddell
- Hugo Dawson
- Hugo Hodges
- Hugo Kaye
- Hugo Longoria
- Hugo Romero
- Hulda Donato
- Huma Shaikh
- Hunter Dawson
- Hwa Gragg
- Hyacinth Mccleary
- Hyman Dunn
- Hyman Vera
- Hyon Roybal
- Ian Booth
- Ian Brock
- Ian Cole
- Ian Ferrer
- Ian Glover
- Ian Goodwin
- Ian McDougall
- Ian Menard
- Ian Nicklaw
- Ian Phillips
- Ian Plummer
- Ibrahim Lawrence
- Ibraq Khurshid
- Ida Waddell
- Idell Holtz
- Idris Adams
- Idris Bean
- Idris Galloway
- Iesha Mccants
- Igor Melnikov
- Ike Gibbs
- Iker Morris
- Iksana Sehgal
- Ikshan Darsha
- Ikshita Charan
- Ikshita Kishore
- Iksita Vijaya
- Ilda Swearingen
- Imani Angulo
- Imelda Hollenbeck
- Immanuel Dill
- Imran Ibrahim
- Ina Liddell
- Inder Bhatt
- Inder Kant
- Inderjeet Kaur
- Inderjeet Khullar
- Inderjeet Sharma
- Inderjit Kang
- Inderjit Verma
- Indermohan Rana
- Inderpal Prasad
- Indira Talukdar
- Indraditya Pandit
- Indrajeet Sura
- Indraneel Narang
- Indrani Sudha
- Indrasen Chaudhari
- Indratan Neelam
- Indravardhan Rana
- Indresh Rastogi
- Indu Debnath
- Indubhushan Chaudhary
- Indukant Gayakwad
- Indumati Rai
- Inell Stoker
- Ingrid Bozeman
- Inocencia Harr
- Iona Hogg
- Iona Levi
- Ipsita Rastogi
- Iranna Rehman
- Irene Harris
- Iris Moore
- Iris Murdock
- Iris Terry
- Irma Forster
- Irving Medeiros
- Irving Russo
- Isa Lanning
- Isaac Adams
- Isaac Clements
- Isaac Fitzgerald
- Isaac Hughes
- Isaac Stanton
- Isaac Walker
- Isabel Brown
- Isabel Madison
- Isabel McGrath
- Isabel Myers
- Isabel Nelson
- Isabella Carter
- Isabella Davis
- Isabella Dawson
- Isabella Evans
- Isabella Hughes
- Isabelle Bryant
- Isabelle Fletcher
- Isabelle Lewis
- Isabelle Maxwell
- Isabelle Nickel
- Isadora Mazza
- Isaura Nutter
- Isha Das
- Ishaan Aggarwal
- Ishan Malik
- Ishani Deka
- Ishani Ghosh
- Ishani Ghoshal
- Ishani Hazarika
- Ishika Jai
- Ishit Pal
- Ishwar Goel
- Ishwar Kumar
- Isla Johnson
- Isla Pierce
- Isla Rennie
- Isla Williams
- Isobel Bates
- Issac Cook
- Iswar Nath
- Itisha Reddy
- Itzel Trudeau
- Ivan Sheen
- Ivelisse Abner
- Ivie Nathaniel
- Ivor McGarry
- Ivory Hendon
- Ivy Baker
- Ivy Gemmell
- Ivy McCallum
- Ivy Mendez
- Ivy Ramsay
- Ivy Stanford
- Ivy Wood
- Izaiah Harvey
- Jaabir Malik
- Jacalyn Turman
- Jace Murdock
- Jace Murphy
- Jacelyn Alfred
- Jacey Murray
- Jacinda Derosa
- Jack Atkinson
- Jack Barker
- Jack Burrell
- Jack Collins
- Jack Marlow
- Jack Penn
- Jack Pittman
- Jack Quinn
- Jack Riley
- Jack Thompson
- Jackeline Mackie
- Jackelyn Langer
- Jackie Otto
- Jackie Pape
- Jacklyn Slaton
- Jackqueline Beane
- Jackson Andrews
- Jackson Lawrence
- Jackson Spencer
- Jackson Taylor
- Jackson Williams
- Jacob Davis
- Jacob Goddard
- Jacob Jones
- Jacob Lopez
- Jacob Meyer
- Jacob Rowe
- Jacob Thomas
- Jacob Wright
- Jacqualine Borrego
- Jacqueline Roldan
- Jacques Howard
- Jacquetta Marchand
- Jacquiline Peeler
- Jacquline Steel
- Jada Thrash
- Jade Duddridge
- Jade Murphy
- Jaden Evans
- Jaden Thompson
- Jaden Ventura
- Jae Calabrese
- Jael Payne
- Jaenette Mountford
- Jagan Gokhale
- Jagan Parekh
- Jagat Anand
- Jagatveer Patel
- Jagbir Chawla
- Jagdeep Sidhu
- Jagdish Chand
- Jagdish Roy
- Jagdish Shah
- Jaggu Maan
- Jagmohan Aulakh
- Jagmohan Mann
- Jagriti Dubey
- Jagriti Kumar
- Jahnavi Chopra
- Jai Amble
- Jai Verma
- Jaidayal Kaushik
- Jaiden Young
- Jaime Allison
- Jaime Hunter
- Jaime Wampler
- Jaipal Bedi
- Jairo Reeder
- Jake Bennett
- Jake Burns
- Jake Dewey
- Jake Patel
- Jake Spencer
- Jakir Husen
- Jakob Hay
- Jakobe Cahill
- Jaleesa Mahaffey
- Jalyn Click
- Jalynn Flagg
- Jama Pomeroy
- Jamaal Udeen
- Jame Schiller
- Jameel Husain
- James Burke
- James Cameron
- James Carter
- James Clifton
- James Cook
- James Corday
- James Defoe
- James Denton
- James Fillis
- James Metz
- James Moffett
- James Walker
- Jameson Kemp
- Jameson Lopez
- Jamey Whyte
- Jami Andre
- Jamie Artley
- Jamie Hagan
- Jamie Hanks
- Jamie Kelley
- Jamie Langdon
- Jamie Spooner
- Jamika Briseno
- Jamil Dawkins
- Jan Cooper
- Jana Mckenney
- Janae Munn
- Jane Darcy
- Jane Urry
- Janee Lindstrom
- Janel Peel
- Janelle Pounds
- Janet Hoffman
- Janeth Withrow
- Janett Barba
- Janetta Barham
- Janette Cowles
- Janice Brando
- Janice Campbell
- Janice Hunter
- Janis Rayford
- Janki Das
- January Drayton
- Janvi Deshmukh
- Jaquelyn Giron
- Jared Barnes
- Jared Jones
- Jared Kroff
- Jared Peters
- Jaren Oakes
- Jaron Finley
- Jarrod Hamlin
- Jarvis Stern
- Jasbir Mann
- Jase Fitzgerald
- Jasleen Kaur
- Jasmika Mehta
- Jasmin Malley
- Jasmin Wright
- Jasmine Frost
- Jasmine Rogers
- Jason Angstrom
- Jason Fawn
- Jason Harbison
- Jason Hendon
- Jason Hogan
- Jason Lafferty
- Jason Long
- Jason Patterson
- Jason Penn
- Jason Stansberry
- Jason Toledo
- Jason Wayne
- Jaspal Gill
- Jaspal Kaur
- Jaspal Nanda
- Jasper Bates
- Jasper Harrison
- Jasper Hill
- Jasper Meyer
- Jasper Mistry
- Jasper O'Brien
- Jasper Pittman
- Jasraj Sekhon
- Jaswant Rao
- Jaswinder Bains
- Jaswinder Sidhu
- Jatin Bajpai
- Jatin Kaul
- Jatin Seth
- Javid Bhat
- Javid Malik
- Jax Bailey
- Jaxon Garrison
- Jaxon Parry
- Jaxon Phillips
- Jaxon Pine
- Jaxon Roberts
- Jaxon Wheeler
- Jaxson Eaton
- Jay Amsel
- Jay Chauhan
- Jaya Chakma
- Jaya Goswami
- Jaya Laghari
- Jaya Mason
- Jayant Poonia
- Jayanta Chakma
- Jayanta Debbarma
- Jayanti Kalita
- Jayce McCarthy
- Jayce Noonan
- Jaycee Seymore
- Jayceon Garcia
- Jayda Sisco
- Jayden Miller
- Jayden Robertson
- Jayden Stevens
- Jayden Weis
- Jaydon Baez
- Jayesh Daga
- Jayesh Verma
- Jaylen Conn
- Jaylen Hay
- Jaylin Ferreira
- Jaylon Langston
- Jayme Razo
- Jayraj Dixit
- Jayson Bird
- Jazlyn Kovach
- Jazmine Lombard
- Jazmyn Navarrete
- Jean Adkins
- Jean Boynton
- Jean Tabor
- Jean Wilkinson
- Jeanette Jarvis
- Jeanette Stegall
- Jeanice Hindman
- Jeanie Lauer
- Jeannette Troy
- Jeevesh Baweja
- Jeewan Desai
- Jeff Caldwell
- Jeff Hansen
- Jeff Norton
- Jeff Romano
- Jeff Wilson
- Jefferey Cornell
- Jeffery Clarke
- Jeffery Desmond
- Jeffrey Boggs
- Jeffrey Cain
- Jeffrey Carvey
- Jeffrey Penn
- Jeffrey Swann
- Jeffrey Thorpe
- Jemima Carmichael
- Jen Blackwood
- Jena Spencer
- Jena Van
- Jene Ketchum
- Jenee Linville
- Jeniffer Boisvert
- Jenna Brandenburg
- Jenna Whitney
- Jennefer Foret
- Jenni Huntington
- Jennie Leake
- Jennifer Chism
- Jennifer Harvey
- Jennifer Hicks
- Jennifer Ward
- Jensen Gilbert
- Jensen Helberg
- Jensen Hunter
- Jensen Reed
- Jenson Gonzalez
- Jenson Wells
- Jeramy Zavala
- Jeremiah Downey
- Jeremiah Wallace
- Jeremy Ballard
- Jeremy Browning
- Jeremy Every
- Jeremy Giamatti
- Jeremy Harper
- Jeremy Peirson
- Jeremy Riordan
- Jeremy Rogerson
- Jeremy Wilke
- Jeri Benefield
- Jerica Bottoms
- Jermaine Eaton
- Jerold Gee
- Jerome Baker
- Jerome Fucile
- Jerome Graves
- Jerrod Wesley
- Jerry Larson
- Jerry Miller
- Jerry Thorpe
- Jeshna Goel
- Jesse Charles
- Jesse Hanson
- Jesse Keller
- Jesse Rose
- Jesse Santos
- Jessica Brown
- Jessica Carol
- Jessica Clan
- Jessica Finley
- Jessica Hoover
- Jessie Benson
- Jesus Conrad
- Jett Ryan
- Jhanvi Gill
- Jharna Bara
- Jharna Kalita
- Jhumpa Bajwa
- Jiganasha Yadav
- Jignesh Iyer
- Jignesh Malik
- Jilesh Batra
- Jill Clark
- Jill Lynch
- Jim Foster
- Jim Griffiths
- Jim Salley
- Jim Schermerhorn
- Jim Wang
- Jim Williams
- Jimmy Becker
- Jimmy Gordon
- Jimmy Robb
- Jimmy Taylor
- Jina Redlin
- Jinendra Bawa
- Jithu Mukherjee
- Jitin Biswas
- Jitu Bhuyan
- Jivika Bhasin
- Jiya Chandra
- Joan Bradley
- Joan Stirling
- Joanna Burke
- Joanne Galbraith
- Joanne Perry
- Joaquin Noah
- Joaquin Weber
- Jocelyn Bader
- Jodee Quinonez
- Jodi Rosenbaum
- Jodie Sharkey
- Jody Kilgore
- Joe Becker
- Joe Carry
- Joe Myers
- Joe Oswald
- Joe Sawyer
- Joe Taylor
- Joel Reynolds
- Joel Turner
- Joel White
- Joelle Catalano
- Joerg Porter
- Joesph Gabriel
- Joetta Hershberger
- Joey Gallegos
- Joey Holland
- Joffrey Butler
- Jogendra Basu
- Jogindar Ray
- Johan Saunders
- Johana Meyer
- Johann Casini
- Johann Wells
- Johanna Muller
- Johanna Stuart
- Johanne Loftin
- John Bailey
- John Bell
- John Boyd
- John Dalvi
- John Dixon
- John Fenmore
- John Frost
- John Hardiman
- John Herald
- John Holland
- John Jensen
- John Lacey
- John McGee
- John Morris
- John Mosley
- John Sheridan
- John Tegmeyer
- John Vela
- John Wayne
- John Williams Barrow
- Johna Nowlin
- Johnetta Shore
- Johnnie Caskey
- Johnnie Marin
- Johnny Carrey
- Johnny Fuller
- Johnny Hendrix
- Johnny Hofstader
- Johnny McDougall
- Johnson Dumas
- Joi Henke
- Joie Maclean
- Joleen Medlock
- Jolene Roller
- Jolie Gatewood
- Joline Tenney
- Jonah Armstrong
- Jonah Hedges
- Jonah Holmes
- Jonah Lyons
- Jonah Martinez
- Jonah O'Kelly
- Jonah Stewart
- Jonali Bajwa
- Jonas Bailey
- Jonas Dexter
- Jonas Hoover
- Jonathan Ayers
- Jonathan Farmer
- Jonathan Frost
- Jonathan King
- Jonathan Molaro
- Jonathon Saunders
- Jonelle Loper
- Jonie Tejada
- Jonita Grover
- Jordan Berg
- Jordan Bryant
- Jordan Goldberg
- Jordan Henry
- Jordan Jacobs
- Jordan Long
- Jordan Smith
- Jordan Taylor
- Jordy Swan
- Jorge Green
- Jorge Harker
- Jose Barnett
- Jose Beck
- Jose Clark
- Jose Doherty
- Jose Mabry
- Jose Palacios
- Jose Wells
- Josefina Bruton
- Joseph Anderson
- Joseph Budd
- Joseph Hand
- Joseph Howard
- Joseph Keene
- Joseph Keller
- Joseph Kent
- Joseph Lowell
- Joseph Owens
- Joseph Welker
- Joseph Young
- Josephine Buren
- Josephine Randall
- Josephine Wilson
- Josephine Winston
- Josette Gracia
- Josh Connolly
- Josh Creel
- Josh Olson
- Josh Wiseman
- Joshia Franko
- Joshita Thakur
- Joshua Barnard
- Joshua Cole
- Joshua Garrett
- Joshua Grayson
- Joshua Hall
- Joshua Hawk
- Joshua Holt
- Joshua Kelly
- Joshua Krieger
- Joshua Scott
- Joshua Watkins
- Josiah Jackson
- Josiah Walker
- Josie Frazier
- Josie Lewis
- Josie Sparks
- Josue Richards
- Jovan Dahl
- Jovany Lin
- Jovita Gandhi
- Joy Adam
- Joy Foster
- Joy Moody
- Joyce Bradbury
- Joyce Kennedy
- Joycelyn Dollar
- Joyeeta Banerjee
- Juan Daniels
- Juan Heflin
- Juan Heller
- Juan Landers
- Juanita Redmon
- Judah Carter
- Jude Boucher
- Jude Boyd
- Jude Chapman
- Jude Cooper
- Jude Major
- Jude Randall
- Jude Smyth
- Jude Stinton
- Jude Turner
- Judi Teeter
- Judith Baker
- Judith Hopkins
- Judson Cates
- Judy Dickens
- Judy Landis
- Jugal Puri
- Jugalhans Lamba
- Jugalkishore Giri
- Jugalraj Chauhan
- Jules Waddell
- Julia Doyle
- Julia Page
- Julia Pizzo
- Julia Taylor
- Julian Cass
- Julian Cruz
- Julian Custer
- Julian Evans
- Julian Hodges
- Julian Keane
- Julian Silva
- Julian White
- Juliana Lang
- Julianne Hickson
- Juliet Patterson
- Juliette Backer
- Juliette Brookes
- Juliette Watts
- Julio Bolton
- Julio Dell
- Julio McDonell
- Julius Duffy
- Jun Yu
- Junaid Malik
- June Garmon
- June Palmer
- June Stewart
- Jung Horan
- Junie Ives
- Juri Bhuyan
- Justin Clifford
- Justin Curthoys
- Justin Riggs
- Jyestha Arya
- Jyothika Dayal
- Jyoti Dayal
- Jyoti Goel
- Jyoti Kalra
- Jyoti Pandey
- Jyotibala Chaterjee
- Jyotica Mahajan
- Jyotika Chaterjee
- Jyotindra Chopra
- Jyotiranjan Bhati
- Jyotirmaya Bakshi
- Jyotirmayee Sundaram
- Jyotirmoyee Balakrishna
- Jyotsna Agarwal
- Kaashi Ganguly
- Kaashif Shoaib
- Kabeer Bapat
- Kabir Chopra
- Kacey Conley
- Kacie Goulet
- Kacper Robertson
- Kade Sebastian
- Kaden Hunt
- Kaela Lennon
- Kaelyn Orellana
- Kahkashan Aziz
- Kai Hughes
- Kaia Burnett
- Kaia Sena
- Kaiden Fountain
- Kaiden Higgins
- Kaiden Mueller
- Kailash Bohra
- Kailash Kapoor
- Kailash Rampal
- Kailash Seth
- Kailash Singh
- Kailashdevi Durga
- Kailashnath Das
- Kailyn Candelaria
- Kainaat Kapoor
- Kaitlyn Morris
- Kaitlynn Funderburk
- Kaiya Jorgenson
- Kajal Deshmukh
- Kajal Gupta
- Kajal Kumari
- Kajol Parekh
- Kale Sheffield
- Kale Stewart
- Kaleb Lynch
- Kaleb Stirling
- Kaley Ann
- Kalinda Basu
- Kaliyah Sturm
- Kalkin Luthra
- Kallie Will
- Kalpana Adhikaari
- Kalpana Hooda
- Kalus Wagner
- Kalyan Sastry
- Kalyani Roy
- Kalyn Worth
- Kamal Faujdar
- Kamal Kakkar
- Kamala Menon
- Kamala Nunley
- Kamala Rafi
- Kamalan Gambhir
- Kamalbandhu Gupta
- Kamaldev Kohli
- Kamaljit Mann
- Kamalkaar Chauhan
- Kamalkant Mathur, Hasan Mansoor
- Kamalkishore Rao
- Kamalnain Tyagi
- Kamalnath Shah
- Kamalnayan Bagchi
- Kamarupa Mohan
- Kambod Menon
- Kambodi Mitra
- Kamboj Arora
- Kamden Carney
- Kamendra Bajwa
- Kameron Ricks
- Kameron Smith
- Kamesh Dhingra
- Kameshwar Deb
- Kamin Bhonsle
- Kamini Boro
- Kamini Yadav
- Kamla Kaushik
- Kamla Shinde
- Kamlapati Mishra
- Kamlesh Dabral
- Kamod Maurya
- Kamraj Nayar
- Kamron Ackerman
- Kamsa Tripathi
- Kamukh Sehgal
- Kamya Nanda
- Kanakamya Sethi
- Kanaklata Khosla
- Kanakpriya Shetty
- Kanaksudha Chowdhury
- Kanan Desai
- Kanav Puri
- Kanchan Mani
- Kanchanprabha Munshi
- Kanchi Taneja
- Kandi Coward
- Kandice Buss
- Kandra Dorris
- Kandy Galbraith
- Kane Carlisle
- Kane Harlow
- Kane Lloyd
- Kaneer Ahuja
- Kaneez Salman
- Kangana Ahluwalia
- Kangana Mishra
- Kanhaiya Deshpande
- Kanika Arora
- Kanika Rao
- Kanika Seth
- Kanimozhi Mangal
- Kanisha Linkous
- Kanishk Ray
- Kanishka Randhawa
- Kanishtha Khanna
- Kankeyan Gokhale
- Kannmani Das
- Kanta Gupta
- Kanti Dubey
- Kantimoy Chauhan
- Kanu Madan
- Kanupriya Deshmukh
- Kanwaljeet Biswas
- Kanwardeep Saxena
- Kapidhwaj Thakur
- Kapil Sachdev
- Kapila Singh
- Kapilesh Yadav
- Kapirath Dhillon
- Karamjit Bhasin
- Karamveer Wadhwa
- Karan Mittal
- Karan Patino
- Karan Shah
- Karan Varma
- Karanvir Bajwa
- Karen Brooks
- Karen Cusack
- Karen Hardt
- Karen McMahon
- Karen Miles
- Karena Spalding
- Karie Wilt
- Karim Sayyed
- Karina Kuntz
- Karisa Perrin
- Karishma Choudhury
- Karishma Irani
- Karl Meloni
- Karl Pegg
- Karl Rauch
- Karl Seibert
- Karla Hodges
- Karlee Shumaker
- Karlene Whited
- Karmjit Nigam
- Karmveer Ahluwalia
- Karnik Nair
- Karolina Jensen
- Karryn Beltran
- Karson McCormack
- Kartar Mahadevan
- Karter White
- Karthi Kamdar
- Karthika Banerjee
- Karthikan Ahuja
- Kartik Doshi
- Kartik Sinha
- Kartik Thakur
- Kartikeya Bahl
- Kartiki Sarwaan
- Karuna Dang
- Karunanidhi Shyam
- Karunashankar Patani
- Karunasree Dutta
- Karunesh Sapru
- Kasandra Dunne
- Kasey Coates
- Kasey Holcombe
- Kasha Mackay
- Kashika Tandon
- Kashinathan Godbole
- Kashish Mehta
- Kashmeera Jha
- Kashvi Raghav
- Kasi Nabors
- Kasinathan Rao
- Kason Hurst
- Kassandra Horowitz
- Kassie Bertram
- Kassim Aziz
- Kassim Sheikh
- Kasturi Bansal
- Katarina Lemke
- Kate Banks
- Kate Brown
- Kate Erickson
- Kate Fellows
- Kate Hedges
- Kate Holland
- Kate Porter
- Kate Summers
- Kate White
- Kate Wright
- Katelyn Harding
- Katelyn Wentz
- Katelynn Alcala
- Katerina Beeler
- Katerine Durden
- Katharyn Hostetler
- Katheleen Marlowe
- Katherin Mortensen
- Katherina Roberge
- Katherine Camarillo
- Katherine Howard
- Katherine Potter
- Katherine Stokes
- Kathern Shrader
- Kathi Covert
- Kathie Greiner
- Kathleen Curtin
- Kathleen Lloyd
- Kathlene Hatchett
- Kathline Laporte
- Kathlyn Prentice
- Kathrine Taber
- Kathryn McCarthy
- Katie Beckett
- Katie Nixon
- Katie Phillips
- Katie Stevens
- Katina Fuqua
- Katlin McAndrew
- Katy Sam
- Kausar Gosain
- Kaushal Mehta
- Kaushal Tulsi
- Kaushali Verma
- Kaushalya Chawla
- Kaushik Chaudhary
- Kaushiki Deka
- Kaustubh Khanna
- Kautilya Bahuguna
- Kaveeesha Raman
- Kavini Sahni
- Kavita Bhuyan
- Kavita Borah
- Kavita Jain
- Kavya Rajan
- Kavya Rao
- Kavyashree Mohanty
- Kawalpreet Jaiswal
- Kay Weed
- Kaya Bajwa
- Kaya Chabbra
- Kaya Speed
- Kayce Battaglia
- Kayden Robertson
- Kayden Thompson
- Kayla Dawson
- Kayla Treadway
- Kayra Sahrawat
- Kayson Binnington
- Keaton Bower
- Kedar Goswami
- Keegan Mason
- Keena Reno
- Keenan Mcneal
- Keerthi Arya
- Keerthi Iyer
- Keerthi Prasad
- Keerthika Awasthi
- Keira Darius
- Keira O'Donnell
- Keira Styles
- Keith Hagar
- Keith Liverman
- Keith Steen
- Keith Wheatley
- Keitha Doll
- Keli Gaskin
- Kellan Sparks
- Kelle Langdon
- Kelley Crews
- Kelley Mccaffrey
- Kelli Tribble
- Kellie Ahern
- Kelly Stanley
- Kelly Ward
- Kelsey Malone
- Kelton Abrams
- Ken Lao
- Ken Shaw
- Ken Spiner
- Kena Wirth
- Kenda Andres
- Kendall Grant
- Kendall Jefferson
- Kendrick Porter
- Kendrick Sanderson
- Keneth Huggins
- Kenna Mcswain
- Kenneth Berger
- Kenneth Cliffe
- Kenneth Dimick
- Kenneth Frost
- Kenneth Hailey
- Kenneth Hayes
- Kenneth McAllister
- Kenneth Washington
- Kennith Quintana
- Kenny Lang
- Kenny Pierre
- Kenny Ward
- Kent Buchanan
- Kent Daly
- Kent Olsen
- Kenyon Muller
- Kenza Wilson
- Kenzie Fenner
- Keri Petit
- Kerri Ritchey
- Kerry Bond
- Kesar Mehta
- Keshav Dev Singh
- Keshav Kulkarni
- Keshav Malhotra
- Keshia Easton
- Ketak Agnihotri
- Ketaki Bawa
- Keturah Garris
- Keven Ladner
- Kevin Chapman
- Kevin Dollar
- Kevin Elmer
- Kevin Hodnett
- Kevin Houston
- Kevin Keys
- Kevin Matthews
- Kevin Merriman
- Kevin Ortega
- Kevin Parker
- Kevon Coker
- Kewalkishore Bhalla
- Keyla Griswold
- Keyshawn Crocker
- Keziah Scott
- Khadijah Schott
- Khagendra Ahluwalia
- Khalid Mckinley
- Khalilah Bussey
- Khanak Chaudhary
- Khayali Pandey
- Khursheed Habeeb
- Khursheed Mir
- Khush Wahi
- Khushank Acharya
- Khushmita Jaiswal
- Khyati Gada
- Kiaan Dwivedi
- Kian Bennett
- Kian Churchill
- Kian Hamilton
- Kian Peoples
- Kiana Halverson
- Kianna Isaacson
- Kiara Woods
- Kiara Yadav
- Kieran Helton
- Kieran Rhodes
- Kieran Robertson
- Kieron Gillen
- Kiersten Roderick
- Kiesha Kunkel
- Killian Sullivan
- Kim Geller
- Kim Moniz
- Kim White
- Kimaya Sachdev
- Kimball Cho
- Kimber Pantoja
- Kimberely Pipkin
- Kimberlee Snipes
- Kimberley Briones
- Kimberli Ingle
- Kimberlie Kozlowski
- Kimberly Cook
- Kimberly Flynn
- Kimberly Mills
- Kimberly Porter
- Kimberly Wiese
- Kimble Molina
- Kimbra Pointer
- Kimi Turnbull
- Kimiko Wooden
- Kina Banuelos
- Kingston Hunt
- Kip Fink
- Kira Chilton
- Kira Jenkins
- Kiraat Rana
- Kiran Rani
- Kiranmala Dewan
- Kiratmani Kapadia
- Kireeti Trivedi
- Kirit Bhatt
- Kirk Anderson
- Kirk Jeffries
- Kirstie Jacks
- Kirstin Ripley
- Kirti Kapoor
- Kirtibhushan Awasthi
- Kirtsten Faucit
- Kiruthika Oberoi
- Kishan Joshi
- Kishore Bhatta
- Kishore Chakraborty
- Kishore Deb
- Kishore Raj
- Kishore Verma
- Kit Tellez
- Kittie Zhang
- Kitu Grewal
- Kiyansh Anand
- Kiyansh Jain
- Kizzy Kirkwood
- Klara Cook
- Kobe Roberts
- Kokila Gokhale
- Kole Costello
- Kolton Lowry
- Kolton Warner
- Komal Menon
- Konkona Biswas
- Korbin Bowers
- Korey Espinosa
- Korey Maximilian
- Kornelia Wood
- Koshin Kamble
- Koushik Roy
- Kousika Goel
- Kovidh Mukherjee
- Kovind Kaul
- Kriday Jaiswal
- Kripa Parekh
- Kripanandan Pant
- Krish Dewan
- Krisha Sanghvi
- Krishan Shetty
- Krishang Parkhi
- Krishanu Ahuja
- Krishanu Takkar
- Krishna Kumar
- Krishnamohan Sethia
- Krishnamurti Bhattacharya
- Krishnan Rao
- Krishnendu Dutta
- Krishnendu Mukherjee
- Krishnendu Vyas
- Kristal Limon
- Kristan Meeker
- Kristen Bone
- Kristian Gilmore
- Kristian Phipps
- Kristie Ames
- Kristie Granados
- Kristle Paredes
- Kritagya Chopra
- Kritika Kapoor
- Kritika Luthra
- Kritika Singh
- Krushal Awasthi
- Kruthika Kansal
- Kruti Oberoi
- Kruttika Uppadhay
- Krystal Wild
- Krystina Mesa
- Krystyna Pogue
- Kshantu Solanki
- Kshipra Tyagi
- Kshiraj Agrawal
- Kshitee Bansal
- Kshitij Saxena
- Kshitij Verma
- Kshma Sharma
- Kshtidhar Bhatnagar
- Kulbhushan Ray
- Kuldeep Vaidya
- Kuldip Srivastava
- Kuljeet Sagar
- Kulraj Hans
- Kulranjan Swarup
- Kulwinder Deol
- Kumkum Tandon
- Kumud Patel
- Kumudavalli Kashyap
- Kunal Chadha
- Kunal Garg
- Kunal Sehgal
- Kundan Mani
- Kunshi Apte
- Kuntal Bedi
- Kunti Bakshi
- Kurneet Kalra
- Kurt Correa
- Kurt Marcel
- Kushad Chabra
- Kushal Dhar
- Kushal Wadhwa
- Kushala Bindra
- Kushwant Jaiswal
- Kusum Acharya
- Kusum Bhattacharya
- Kusum Deka
- Kusum Sarma
- Kusuma Laghari
- Kusumanjali Jain
- Kye Young
- Kyla Dang
- Kylan Wilkins
- Kyle Baldwin
- Kyle Baxter
- Kyle Becnel
- Kyle Bonilla
- Kyle Hill
- Kyle Sprouse
- Kyle Walker
- Kylian Harper
- Kymberly Browder
- Kyra Dochertyt
- Kyra Trask
- Kyrie Hamilton
- Kyrie Zuniga
- Kyung Jefferies
- Lacey Serrano
- Lachlan Graham
- Lachman Dasgupta
- Laci Tuggle
- Lacie Matthews
- Lacy Embry
- Lady Luttrell
- Lael Mccloskey
- Lafiza Rehman
- Lai Sorrell
- Laila Prady
- Lakeesha Christman
- Lakeisha Concepcion
- Lakendra Heim
- Lakesha Ramon
- Lakeshia Samples
- Lakhan Bohra
- Lakia Schweitzer
- Lakisha Tremblay
- Lakita Wynne
- Laksha Yadav
- Lakshit Malik
- Lakshita Chandra
- Lakshita Mohanty
- Lakshith Jaiswal
- Lakshiv Kaushik
- Lakshiya Varma
- Lakshmikant Chopra
- Lakshminarayan Grewal
- Lakshmna Basu
- Laksit Kapoor
- Lalit Deol
- Lalit Dhar
- Lalit Kochar
- Lalit Tuli
- Lalita Chatterjee
- Lalita Dobriyal
- Lalitesh Basu
- Lalitesh Lamba
- Lambert Jones
- Lan Doan
- Lana Roche
- Lancaster Mason
- Lancel Herring
- Landen jimenez
- Landon Jenkins
- Lane Cobb
- Lane Dempsey
- Lanette Song
- Lanita Demers
- Lanny Self
- Lanora Hildreth
- Laquita Mabe
- Lara Halcomb
- Larae Mcinnis
- Larissa Hassell
- Laronda Keel
- Larraine Manson
- Larry Edgerton
- Larry Graham
- Larry Madison
- Larry Mah
- Larry Olson
- Larry Stone
- Lars Grund
- Larue Sutter
- Lashaun Clemmons
- Lashawnda Sumpter
- Lashay Breedlove
- Lashell Desantis
- Lashon Greenlee
- Lashonda Longo
- Lashunda Oates
- Lasonya Tam
- Latanya Yount
- Latarsha Baumann
- Latesha Morehead
- Latika Dhanraj
- Latisha Akin
- Latonia Gist
- Latonya Goble
- Latosha Montero
- Latrina Burley
- Latrisha Lowell
- Laura Hart
- Laura Kent
- Laura Vivian
- Laureen Creighton
- Laurel Harper
- Lauren Acosta
- Lauren Barrett
- Lauren Cartwright
- Lauren Ingram
- Lauren Marini
- Laurence Denton
- Laurene Hedges
- Lauretta Koonce
- Laurie Fulmer
- Lavanya Jain
- Lavanya Mistry
- Lavanya Sawant
- Lavern Crockett
- Laverne Corral
- Lavette Larry
- Lavina Oh
- Lavinia Scarbrough
- Lavish Ahuja
- Lavita Jha
- Lavitha Patel
- Lavitra Pahwa
- Lavjeet Kriplani
- Lavonia Moe
- Lavonne Urbina
- Lawanda Duval
- Lawanna Fong
- Lawrence Baker
- Lawrence Bech
- Lawrence Bell
- Lawrence Daley
- Lawrence Davenport
- Lawrence Grattan
- Lawrence Mueller
- Lawrence Poole
- Laxit Jindal
- Laxman Nagaraj
- Laxman Patnaik
- Laxmi Mahto
- Laxmigopal Bhat
- Laxmipati Gautam
- Laxmisrinivas Iyer
- Laxya Narayan
- Layla Barnaby
- Layla Warner
- Layne Burt
- Layton Russell
- Layton Stanford
- Lazaro Arthur
- Lean Ruby
- Leann Wentworth
- Leanna Faber
- Leatrice Keeton
- Leda Monson
- Lee Hoskins
- Lee Seaton
- Lee Stanton
- Lee Zieger
- Leeann Trapp
- Leeanna Albers
- Leeanne Borges
- Leela Patel
- Leeladhar Khanna
- Leelakar Jadhav
- Leelavati Dewaikar
- Leena Reang
- Lehar Kulkarni
- Lehr Desai
- Leia Hildebrand
- Leigh Mcmurray
- Leighann Ferraro
- Leila Alistair
- Leila Humes
- Leisha Matheny
- Lekhan Dange
- Lekhit Chabbria
- Lela Shin
- Leland Carlyle
- Leland Lam
- Leland Morrow
- Lennart Davenport
- Lennon Carlson
- Lenny Hart
- Lenore Ashdown
- Leo Goldberg
- Leo Graham
- Leo Roberts
- Leo Wright
- Leoma Whitlow
- Leon Batchelor
- Leon Beach
- Leon Cameron
- Leon Chapman
- Leon Darwin
- Leon Heseltine
- Leon Hopkins
- Leon Webster
- Leon Welsh
- Leona Casteel
- Leonard Fisher
- Leonard Hensley
- Leonard Roosevelt
- Leonard Sutherland
- Leonarda Coble
- Leonardo Hules
- Leonardo Reeves
- Leonel Davila
- Leonel Ware
- Leonida Weatherford
- Leonidas Neilson
- Leontine Neuman
- Leopoldo Mata
- Lesa Fairley
- Lesley Coffman
- Lesley Easton
- Lesley Graham
- Lesley Parsons
- Lesley Redden
- Leslie Hunt
- Leslie Schwartz
- Leslie Taylor
- Leslie Whaley
- Leslie York
- Lesly Whitmire
- Lester Bane
- Lester Bingham
- Lester Jacob
- Lester Price
- Letha Merrick
- Letitia Stpierre
- Levi O'Brein
- Lewis Allison
- Lewis Britton
- Lewis Cerny
- Lewis Clowers
- Lewis Humphries
- Lewis Price
- Lexus Harwood
- Leyton Gray
- Lia Coutts
- Liam Hopkins
- Liam Lewis
- Liam Lopez
- Liam Owens
- Liam Page
- Liam Romano
- Liam Spencer
- Liam Williams
- Libby Nutt
- Liberty Flores
- Libin Arora
- Lien Poore
- Lilian Mandelbaum
- Liliana Cooper
- Liliana Doyle
- Liliana Lombardi
- Lilli Nagy
- Lilliam Warfield
- Lillian Harper
- Lillian Stephen
- Lilliana Saunders
- Lilliana Wimberly
- Lillie Conyers
- Lilly Armstrong
- Lilly Ferry
- Lilly Martin
- Lilly Walker
- Lily Barker
- Lily Bowen
- Lily Chen
- Lily Hartman
- Lily Hill
- Lily Kingsley
- Lily Thomas
- Lin Chapin
- Lina Calder
- Lincoln Burns
- Linda Cartman
- Linda Morand
- Linda Morant
- Lindsay Ayala
- Lindsay Garfield
- Lindsay Settle
- Lindsey Enos
- Lindy Bowman
- Linh Mullin
- Linn Reis
- Linwood Novak
- Lionel Russ
- Lipakshi Dave
- Lipika Chaturvedi
- Lipika Reddy
- Lisa Jordan
- Lisa Page
- Lisa Rowe
- Lisa Swinton
- Lisabeth Francois
- Lisandra Ostrander
- Lisette Solano
- Lishanth Hooda
- Litiksha Vij
- Livia Cowie
- Lizzy Rattini
- Logan Bowman
- Logan Fletcher
- Logan Hayes
- Logan Herr
- Logan Moore
- Logen Robinson
- Loida Clarkson
- Lois Epstein
- Lokmaya Malviya
- Loknath Hooda
- Lola Harris
- Lolita Mancuso
- Lomesh Chabbria
- Lon Hilton
- Lonna Daily
- Lonnie Herron
- Lonny Moyer
- Lopa Kapoor
- Lopesh Mhatre
- Loralee Picard
- Loren Gibbons
- Loren Gilbert
- Lorena Shuman
- Lorena Watson
- Lorenza Calkins
- Lorenzo Fernandez
- Lorenzo Jacobs
- Lorenzo Jade
- Lorenzo Thompson
- Loreta Fairbanks
- Loriann Rash
- Lorraine Croteau
- Lorraine Fisher
- Lorretta Nagel
- Lorrine Hardesty
- Lottie Mcclung
- Louann Bruns
- Louie Montes
- Louis Baker
- Louis George
- Louis Georgeson
- Louis Kemp
- Louis Kimball
- Louis Rose
- Louis Ward
- Louis Young
- Louisa Alba
- Lourie Mcintire
- Love Searcy
- Lovely Tiwari
- Lovetta Arndt
- Lowell Beatty
- Lu Furman
- Luana Houghton
- Luba Tibbs
- Luca Dowling
- Luca Mason
- Lucas Collins
- Lucas Davis
- Lucas Lincoln
- Lucas Mitchell
- Lucas Morgan
- Lucas Weber
- Lucas Wood
- Lucia Wheaton
- Luciana Bourne
- Luciano Ritter
- Lucias Chapman
- Lucie Hay
- Lucila Hamrick
- Lucilla Masterson
- Lucille Samson
- Lucina Stowe
- Lucio Price
- Lucius Graves
- Lucius Walker
- Lucrecia Crider
- Lucus Payne
- Lucy Balderas
- Lucy Chisholm
- Lucy Flynn
- Lucy Malone
- Lucy Phillip
- Lue Mcneely
- Luis Bender
- Luis Mason
- Lukas Brooks
- Lukas Hastings
- Luke Chesterton
- Luke Dewing
- Luke Fitzgerald
- Luke Holt
- Luke Madison
- Luke McCoy
- Luke Mosley
- Luke Nguyen
- Luke Stanton
- Luna Bailey
- Luna Foster
- Luna Haywood
- Luna-Rose Strachan
- Lurlene Lemus
- Lurline Morley
- Luther Doyle
- Luther Webber
- Luvdeep Ahlawat
- Luz Craddock
- Lydell Norris
- Lydia Hemsworth
- Lydia McFarland
- Lydia Perry
- Lydia Stephens
- Lyla Collins
- Lyla Phillips
- Lyla Smith
- Lyla Wood
- Lyle Gore
- Lyman Krueger
- Lynda Feidan
- Lyndon Mckinney
- Lyndsay Ellsworth
- Lynetta Fanning
- Lynette Hamblin
- Lynn Mcdonnell
- Lynne Brumfield
- Lyric Sauls
- Maadhav Gupta
- Maahi Irani
- Maalavika Luthra
- Maanav Batra
- Maanav Gour
- Maanya Kundar
- Mabelle Batista
- Mac Godfrey
- Maci Valerio
- Mack Blanton
- Mackenzie Carlos
- Mackenzie Ruiz
- Madalyn Keefer
- Maddison Cunningham
- Maddox Clooney
- Maddox Moran
- Madelene Cota
- Madeline Davidson
- Madeline Iremonger
- Madelyn Crews
- Madelyn Goodman
- Madelyn Wilson
- Madhav Mannan
- Madhav Tiwari
- Madhav Verma
- Madhavan Rao
- Madhumita Ohri
- Madhumitha Mathur
- Madhur Puri
- Madhura Kansal
- Madhuresh Chawla
- Madhuri Borah
- Madhuri Chaudhary
- Madhushree Dewan
- Madina Richards
- Madirakshi Anand
- Madison Morgan
- Madison Sturgeon
- Madison West
- Madison White
- Maegan Brent
- Magali Reinhardt
- Magan Birch
- Magaret Edge
- Magdalene Peak
- Maggie Crosby
- Maggie Klein
- Magnolia Bigelow
- Mahendra Kumar
- Mahesh Kapadia
- Mahesh Kumar
- Mahfuz Murshed
- Mahi Reddy
- Mahikaa Ahluwalia
- Mahima Bakshi
- Mahindar Goel
- Mahir Johar
- Mahira Iyer
- Maia Gustin
- Maira Dutta
- Maire Garnett
- Maisie Lockheart
- Maisie Riggins
- Maisie Walter
- Maisie Wright
- Maison Owen
- Maisy Houston
- Maitreyi Mehta
- Majeed Khan
- Major Magee
- Makayla Armijo
- Makayla Lynwood
- Makenna Jay
- Malachi Adams
- Malachi Rutherford
- Malaika Tiwary
- Malakai Shoemaker
- Malcolm Becker
- Malcolm Fisher
- Malcolm Gover
- Malcolm Kripke
- Malcolm Stark
- Malcom Orozco
- Maleeni Grover
- Malena Parker
- Malia Perales
- Malika Ainsworth
- Malinda Doughty
- Malinda Lynn
- Malisa Hamel
- Malissa Mojica
- Malkiat Nijjar
- Malkiat Toor
- Mallory Royer
- Malorie Falcon
- Mamta Gautam
- Manandeep Kalra
- Manas Mukherjee
- Manas Vashisth
- Manashvi Gupta
- Manav Laghari
- Manav Lalvani
- Mandeep Gill
- Mandeep Waraich
- Mandie Shackelford
- Mandira Verma
- Mangesh Murthy
- Mani Hansraj
- Maniistha Mishra
- Manika Kansal
- Manika Vaidya
- Manikaant Pant
- Manil Sanghvi
- Maninder Grewal
- Manipal Taneja
- Manish Goenka
- Manish Kaul
- Manish Reddy
- Manisha Dayal
- Manisha Deka
- Manisha Nair
- Manisha Patel
- Manisitha Lohia
- Manit Dhooper
- Manjeet Mhatre
- Manjeet Singh
- Manju Dhaliwal
- Manjusha Kumar
- Manjushri Murthy
- Manjyot Irani
- Manmohan Chadha
- Mannan Shoaib
- Manoj Kriplani
- Manoj Mulchandani
- Manoshi Vaidya
- Manpreet Cheema
- Mansi Karnani
- Mansi Kundar
- Mansingh Talwar
- Manual Tatum
- Manuel Moser
- Manuela Beckham
- Manushi Jha
- Manushika Goel
- Manushree Jaiswal
- Manveer Sagar
- Manveet Sehgal
- Manvi Kapoor
- Manvik Tripathi
- Manvir Bhonsle
- Many Behrens
- Manya Bhardwaj
- Mao Kolb
- Mara Allan
- Maragaret Barbosa
- Maragret Do
- Maranda Lavoie
- Marcelina Bueno
- Marcelle Boling
- Marcelo Mahoney
- Marchelle Marx
- Marcia Dion
- Marcie Fortin
- Marco Malloy
- Marco Patton
- Marcos Parrish
- Marcus Gardner
- Marcus Hawkins
- Marcus Hintz
- Marcus Lewis
- Marcus Newman
- Marcus Pearce
- Marcus Ward
- Marcy Purnell
- Marcy Ward
- Maren Bohannon
- Marg Gentile
- Margaret Barton
- Margaret Booth
- Margaret Colgan
- Margaret Crayton
- Margaret Hunter
- Margaret Morris
- Margaret Nash
- Margaret Ziegler
- Margarete Amador
- Margaretta Foy
- Margart Edward
- Marge Mcarthur
- Marget Lemieux
- Margo Field
- Margo Upson
- Margot Reilly
- Margurite Beckett
- Margy Chavarria
- Maria Forest
- Maria Malone
- Maria Walters
- Maria White
- Marian Lucas
- Marian Mcnutt
- Mariana Warne
- Marianne Wilde
- Maricela Alicea
- Marie Linares
- Mariella Julian
- Marielle Rendon
- Mariko Grogan
- Marilou Valdes
- Marilynn Harry
- Marina De Lima
- Marina Mount
- Marina Wright
- Marinda Gurley
- Mario Crowley
- Mario McClure
- Mario Walker
- Marion Wilks
- Maris Delvalle
- Marisha Hiatt
- Marjory Stclair
- Mark Ackles
- Mark Avis
- Mark Berger
- Mark Christensen
- Mark Harper
- Mark Kersey
- Mark McFadden
- Mark Romano
- Mark Schulze
- Mark Sheeran
- Mark Teel
- Mark Walters
- Markel Armstrong
- Marko Silver
- Markus Ibarra
- Markus Wagner
- Marlee Colwell
- Marlen Burleson
- Marlena Cromwell
- Marley Harding
- Marline Mena
- Marlon White
- Marlow Coffey
- Marques Vang
- Marquetta Brownlee
- Marquez Helms
- Marquise Bacon
- Marquita Cornish
- Marrianne Fox
- Marry Gibbs
- Marshall Blair
- Marshall Davies
- Marshall Mora
- Marshall Roy
- Martha Butler
- Martha Dixon
- Martha Lesley
- Martha Pratt
- Martha Roper
- Martin Akafeldt
- Martin Bate
- Martin Harker
- Martin Hoover
- Martin Limestone
- Martin Meeks
- Martin Pearson
- Martin Reid
- Martin Whitehead
- Martin Winter
- Martine Herzog
- Marty Galvan
- Marvel Havens
- Marvella Westmoreland
- Marvin Childs
- Marvin Conner
- Marvin Heather
- Marvin Hensen
- Marvin Rauch
- Marvin Trey
- Marvin Ward
- Marvis Harder
- Mary Durrant
- Mary D’Souza
- Mary Felix
- Mary Kellar
- Mary Moreno
- Mary Murphy
- Marya Troutman
- Maryam Sasser
- Maryanne Seward
- Maryellen Kinder
- Maryjo Choate
- Marylee Mcduffie
- Marylin Millard
- Marylouise Crawley
- Marylyn Hauser
- Mason Archie
- Mason Bell
- Mason Burgess
- Mason Button
- Mason Carter
- Mason Corbyn
- Mason Harris
- Mason Jones
- Mason Lopez
- Mason Swain
- Mateo Friedman
- Mateo Roberts
- Mateo Thomson
- Mathew Crowe
- Matilda Dixon
- Matilda Ebert
- Matilda Phillips
- Matilda Schmidt
- Matt Danson
- Matt Ferrier
- Matt Fulcher
- Matt Goodwin
- Matt Keaton
- Matt Weilberg
- Matthew Benoit
- Matthew Boswell
- Matthew Crosby
- Matthew Glenn
- Matthew Griffin
- Matthew Langer
- Matthew Martin
- Matthew Perez
- Matthew Taylor
- Matthew Thomas
- Maud Bostic
- Maude Dowd
- Mauli Sarkar
- Maurice Abbot
- Maurice Granger
- Maurice Kendall
- Maurice Milner
- Maurice Willis
- Maurine Robb
- Mauris Ryan
- Maurvika Tripathi
- Maverick Henderson
- Maverick MacMillan
- Maverick Slaughter
- Mavis Culp
- Max Cowen
- Max Guthrie
- Max Holcomb
- Max Hopkins
- Max Hughes
- Max Jackson
- Max Kirby
- Max Wells
- Maxima Bustamante
- Maximilian Elder
- Maximina Colby
- Maximus Noel
- Maximus Stanley
- Maximus Turner
- Maximus Ward
- Maximus Yang
- Maxine Durham
- Maxine Lovelace
- Maxwell Christie
- Maxwell Little
- Maxwell Oliver
- May Church
- May Hooper
- May Sanders
- Maya Boro
- Maya Deka
- Maya Hawkins
- Maya Kant
- Maya Kundra
- Maya Singh
- Mayank Jain
- Mayank Kapoor
- Mayanshi Sharma
- Maybell Tomlin
- Mayola Motley
- Mayra Anand
- Maysa Wright
- Mayur Kohli
- Mayur Malviya
- Mayura Ahuja
- Mayuresh Dixit
- Mayuri Kapoor
- Mayuri Khatri
- Mckayla Clawson
- Mckinsey Harper
- Meadow Laplante
- Meagan Musser
- Meaghan Seeley
- Meda Lance
- Medhansh Awasthi
- Medina Walsh
- Meena Kapoor
- Meena Laghari
- Meena Ojha
- Meenal Sharma
- Meera Reddy
- Meeta Bakshi
- Meg Rocco
- Megan Baker
- Megan Cosgrove
- Megan Durham
- Megan Tice
- Megha Jalota
- Megha Wadhwa
- Meghan Agnew
- Meghan Higgins
- Meghanshi Narayan
- Mehak Rishi
- Mehbooba Faruqi
- Mehreen Khatun
- Mehul Rao
- Mei Irby
- Meisha Balakrishna
- Mel Roth
- Melanie Back
- Melanie Simon
- Melba Yanez
- Melda Hardison
- Melia Meek
- Melina Duckett
- Melina Lewis
- Melissa Easterlin
- Melissa Gould
- Melita Heaton
- Mellissa Stepp
- Melody Frost
- Melody Glover
- Melody Sawyer
- Melvina Arce
- Mendy Varney
- Mercedes Martens
- Mercy Madrigal
- Meredith Morton
- Meri Marlow
- Merilyn Crouse
- Merissa Fraley
- Merle Guthrie
- Merlin Forbes
- Merrill Mcwhorter
- Merry Qualls
- Mervin Williamson
- Metty O'Brown
- Mia Booth
- Mia Jones
- Mia Rae
- Mia Steers
- Mia Williams
- Miah Clanton
- Mica Morrissey
- Micaela Damron
- Micah Harris
- Micah Taylor
- Micah Valencia
- Michael Backman
- Michael Bradshaw
- Michael Cedric
- Michael Dedini
- Michael Fuller
- Michael Glass
- Michael Gonzalez
- Michael Greco
- Michael Higgins
- Michael Jones
- Michael Schaefer
- Michael Silva
- Michael Stock
- Michael Waterson
- Michael Wyman
- Michal Hewitt
- Michal Linton
- Michale Rasmussen
- Michalina Davis
- Micheal Rinehart
- Michele Grigsby
- Michelle Cooper
- Michelle Henderson
- Michelle Jacobs
- Michelle McGuire
- Michelle Randall
- Michelle Vine
- Mick Benson
- Mick Reece
- Migdalia Redman
- Mignon Shuler
- Miguel Moreno
- Miguel Rodriguez
- Miguel Rudolph
- Miguel Sanchez
- Mihika Chaudhary
- Mihir Doshi
- Mikayla Hall
- Mikayla Reid
- Mike Costello
- Mike Crowley
- Mike Finch
- Mike Rudd
- Mikey Cunningham
- Mikhael Kular
- Mila Cleary
- Mila Powers
- Milan Carson
- Milan Collins
- Milan Dale
- Milda Caruso
- Mildred Fontaine
- Miles Carr
- Miles Carter
- Miles Eron
- Miles George
- Miles Glover
- Miles Lester
- Miles Scott
- Miles Workman
- Miley Davis
- Miley Whitaker
- Mili Kundra
- Milind Dhar
- Milissa Linder
- Millicent Quezada
- Millie Dawson
- Millie Donovan
- Millie James
- Milly Richardson
- Mimi Cheng
- Min Leavitt
- Mindi Harms
- Mindy Adams
- Minh Grantham
- Minnie Hutchison
- Minnie Quarles
- Minta Brinkley
- Miquel Madden
- Mira Luther
- Miranda Cole
- Miranda Hudson
- Mireya Casas
- Miriam Cohn
- Miriam Court
- Mirta Robinette
- Mirza Rehman
- Misael Ratliff
- Misha Bob
- Misha Peralta
- Mishika Sankar
- Mishka Desai
- Mishkat Ohri
- Misti Moffett
- Mistie Nieto
- Misty Howell
- Mitali Jadeja
- Mitanshi Pahwa
- Mitanshu Kansal
- Mitch Hoppe
- Mitch Ruffolo
- Mitch Sellin
- Mitchell Penn
- Mitchell Price
- Mitchell Spencer
- Mitesh Biswas
- Mitesh Sehgal
- Mithun Roy
- Mithun Thakur
- Mitra Iyer
- Mitsue Rider
- Mitzie Garvin
- Mohak Shekhar
- Mohamed Mukhtar
- Mohammad Sharef
- Mohammed Conrad
- Mohan Sehgal
- Mohan Vashisth
- Mohinder Ahluwalia
- Mohini Jain
- Mohisha Jadeja
- Mohit Bhatt
- Mohit Dhyani
- Mohit Iyer
- Mohit Lakhani
- Mohit Reddy
- Moin Hyder
- Moira Kilpatrick
- Mollie Reichert
- Molly Drake
- Molly Hamilton
- Molly Ismay
- Molly Lambert
- Monali Jaiswal
- Monica Hoskin
- Monica Slater
- Monika Rai
- Monika Vyas
- Monisha Chauhan
- Monroe Castaneda
- Monroe Griffiths
- Monserrat Gillen
- Montana Hargis
- Monty Holden
- Morgan Bell
- Morgan Key
- Morgan Menendez
- Morgan Rutherford
- Morgan Stuart
- Morris Beckler
- Morris McMahon
- Mose Baird
- Mouli Sethia
- Moulik Shukla
- Moumita Basu
- Mouni Tyagi
- Mozell Layne
- Mozella Baer
- Mridul Kochar
- Mridul Kulkarni
- Mridul Makhija
- Mridula Agarwal
- Mridula Joshi
- Mrigesh Bhonsle
- Mritansh Shinde
- Mrunal Kochar
- Mrunal Rao
- Mudil Ray
- Mudit Rai
- Mudita Basu
- Mugdha Deshmukh
- Mughda Kundar
- Muhammad Aziz
- Muhammad Mcgowan
- Muhammed Azam
- Mukesh Mhatre
- Mukhtar Ansari
- Mukta Dey
- Mukta Lokhande
- Mukul Atri
- Mukul Desai
- Mukul Kottary
- Mulshankar Taneja
- Muneendra Swarup
- Muneesh Aziz
- Munir Sahni
- Munira Siddiqui
- Munisha Phogat
- Munit Tandon
- Muoi Reardon
- Murad Kochar
- Murali Gopal
- Murishka Reddy
- Murphy Hannah
- Murphy Lane
- Muskaan Kanojia
- Muskaan Sahai
- Mustafa Farikh
- Myah Alves
- Myles Gallagher
- Myles Spencer
- Myra Das
- Myra Duncan
- Myrta Duckworth
- Myrtie Lombardo
- Naavika Arya
- Naazneen Amir
- Nabhav Gada
- Nabhita Trivedi
- Nachiket Wadhwa
- Nadeem Ashraf
- Nadene Schuster
- Nadia Crawford
- Nadia Fallon
- Nadine Jenkins
- Naeemhusain Shaikh
- Nagesh Banerjee
- Nageshwar Yadav
- Nagma Ahmed
- Naimisha Bhati
- Naina Jumani
- Naina Sinha
- Naitika Bakshi
- Nakia Pressley
- Nakshit Varman
- Naman Das
- Naman Dubey
- Namish Tyagi
- Namit Desai
- Namita Bhatia
- Namita Sinha
- Namita Tripura
- Namrata Desai
- Namrata Hassan
- Namrata Kapoor
- Namrata Mehta
- Namrita Narayan
- Nancie Hayward
- Nancy Cahoy
- Nancy Faulkner
- Nancy Maxwell
- Nandani Prasad
- Nandini Chakraborty
- Nandini Dixit
- Nandini Kapoor
- Nandita Barman
- Nandita Singhal
- Nanditha Oberoi
- Naomi Bowman
- Naomi Watts
- Napoleon Mcpherson
- Narav Chandra
- Narayana Swamy
- Narayanan Rao
- Naresh Ahuja
- Naresh Bagchi
- Narmada Bedi
- Narmada Reddy
- Nas Wilson
- Nash Deller
- Nash Stokes
- Natalia Crosby
- Natalia Davies
- Natalia Roberts
- Natalie Harrison
- Natalie Mitchell
- Natalie Spagner
- Natalie Theresa
- Natasha Dhayani
- Natasha Kennedy
- Natasha Rivera
- Nate Newman
- Nathalie Porter
- Nathan Balakrishnan
- Nathan Bush
- Nathan Hamilton
- Nathan Miguel
- Nathan Mitchell
- Nathan Morgan
- Nathan Paul
- Nathan Payne
- Nathan Rice
- Nathan Walter
- Nathaniel Gordon
- Nathaniel Harris
- Nathaniel Wren
- Nauheed Akhtar
- Navalika Narang
- Navdeep Kang
- Naveen Chandra
- Naveen Dixit
- Naveen Verma
- Naveena Mhatre
- Navidita Vij
- Navisa Ghazi
- Navjot Baring
- Navkiranjot Tandon
- Navkirat Soni
- Navneet Mathur
- Navneeta Vohra
- Navya Ahuja
- Navya Sharma
- Nayan Ray
- Nayan Yadav
- Nayanika Mehta
- Ned Burnett
- Ned Kennard
- Ned Wolf
- Neehal Awasthi
- Neeharika Vashisth
- Neel Poddar
- Neelam Kaul
- Neelam Rao
- Neelam Verma
- Neelansh Hans
- Neelasha Choudhary
- Neelima Mani
- Neelu Gill
- Neelu Mishra
- Neena Batra
- Neera Handa
- Neetali Wadhwa
- Neeti Narula
- Neevedhita Kaushik
- Neha Paul
- Neha Rani
- Neha Rao
- Nehemiah Wyatt
- Neida Baum
- Neil Dalton
- Neil Green
- Neil Griffin
- Neil Perry
- Neil Singh
- Neil Swan
- Neilesh Deshmukh
- Neilesha Jha
- Neill Hopkins
- Nelia Jarrell
- Nelida Pepper
- Nelima Singh
- Nell Croft
- Nella Kearns
- Nellie Farrell
- Nelly Foreman
- Nelson Carter
- Nelson Palmer
- Nenita Zeigler
- Neomi Hopson
- Nereida Kohler
- Nessa Oka
- Neta Weldon
- Netra Chaterjee
- Nevaan Kalra
- Nevada Renteria
- Nevaeh Melancon
- Neville Hooper
- Newman Wagner
- Newton Watkins
- Ngoc Dias
- Nguyet Newby
- Niam Farooqi
- Niceto Salazar
- Nicholas Holt
- Nicholas Lott
- Nicholas Pitt
- Nicholas Roche
- Nicholas Thomson
- Nicholas Torrens
- Nichole Sell
- Nicholle Gale
- Nick Easterling
- Nick Fulton
- Nick Gilmour
- Nick Wu
- Nicklaus Hyde
- Nickole Patten
- Nicky Jameson
- Nico Turner
- Nicol Nesbitt
- Nicola Chadwick
- Nicola Feidan
- Nicola Galecki
- Nicola Norris
- Nicolas Auger
- Nicolas Cooley
- Nicolas Judd
- Nicolas Webb
- Nicolasa Crisp
- Nicole Jones
- Nicole Maden
- Nicole Tanaka
- Nicolette Fox
- Nida Dupre
- Nida Farooqi
- Nidhi Chopra
- Nidhish Lokhande
- Nidhvit Joshi
- Nidia Trimble
- Niesha Creech
- Nigel Hogan
- Nigel Mccarty
- Nigel Redman
- Nigel Stokes
- Nigel Whitaker
- Nihal Bhati
- Nihal Shukla
- Nihar Bhardwaj
- Niharika Khatri
- Niharika Sharma
- Nikeet Bajaj
- Nikesha Jaiswal
- Niketan Taneja
- Niketan Trivedi
- Nikhat Kundar
- Nikhil Khurana
- Nikhil Kumar
- Nikhil Mckay
- Nikhila Bhatia
- Niki Poirier
- Nikita Bentley
- Nikita Laws
- Nikita Luthra
- Nikita Mitra
- Nikita Walia
- Nikkhil Uppadhyay
- Nikki Bounds
- Nikku Kundar
- Nikola Thomson
- Nikole Baggett
- Nilakshi Shandilya
- Nilam Upadhayay
- Nilanjan Lohia
- Nilanjit Kalra
- Nilda Lyle
- Nilima Vats
- Nilofer Siddique
- Nilu Kohli
- Nimanjot Ghai
- Nimiksha Sethi
- Nimish Sethi
- Nimit Acharya
- Nimit Nagar
- Nimit Sobti
- Nimrit Goel
- Nina Clarke
- Nina Duran
- Nina Goldman
- Nina Murphy
- Niranjan Sinha
- Niranjana Banerjee
- Niranjani Mukherjee
- Nirav Yadav
- Nirbhay Bhasin
- Nirmaan Ghai
- Nirmal Singh
- Nirmala Debbarma
- Nirmala Nayar
- Nirmala Talukdar
- Nirmala Tripura
- Nirmit Dixit
- Nirupesh Bajwa
- Nirvesh Mehtre
- Nisha Grover
- Nisha Sahni
- Nishaan Awasthi
- Nishank Goel
- Nishant Aggarwal
- Nishant Bhardwaj
- Nishanth Parekh
- Nishay Kashyap
- Nishi Luthra
- Nishika Gokhale
- Nishita Ghosh
- Nishita Pal
- Nishith Desai
- Nishka Garg
- Nishkarsh Walia
- Nishttha Ganguly
- Nishu Kunwar
- Nissar Gupta
- Nita Lipscomb
- Nita Reddy
- Nita Wadhwa
- Nitant Raghuvanshi
- Nitesh Gokhale
- Nitesh Mehta
- Nithin Raj
- Nitiksha Bapat
- Nitushree Dubey
- Nitya Dora
- Nitya Kansal
- Nityaami Ghosh
- Nityapriya Prasad
- Nityashree Basu
- Nivansh Arora
- Nivansha Mathur
- Nivedita Chauhan
- Nivedita Jindal
- Nivita Luthra
- Nivritti Acharya
- Niya Stuart
- Niyas Fazal
- Noah Atkinson
- Noah Carter
- Noah Martin
- Noah Rodriguez
- Noah Stokes
- Noah Thompson
- Noble Crane
- Noe Travis
- Noel Day
- Noel Lane
- Noel Sterling
- Noel Sykes
- Noel Templeton
- Noella Weathers
- Noelle Green
- Noelle Powell
- Noemi Valles
- Nohemi Altman
- Noor Verma
- Nora Ayling
- Nora Carrillo
- Nora Jonas
- Nora Ortega
- Nora Wilson
- Norah Barbour
- Norbert Mercer
- Noriko Mcclelland
- Norman Cantrell
- Norman Glasser
- Norman Henderson
- Norman Rooney
- Norman Schultz
- Norman Tucker
- Norman Waltz
- Novak Simons
- Nowell Yeager
- Numbers Dillon
- Nyasia Guenther
- Nydia Blalock
- Nyla Ewing
- Nylah Erickson
- Nylah McClane
- Nyles Lind
- Nyra Chauhan
- Oakely Webster
- Ocie Schumacher
- Octavia Clark
- Octavia Couture
- Octavio Hester
- Odell Macdonald
- Odessa Burnham
- Odette Cardwell
- Odilia Mosher
- Odis Bray
- Ofelia Tang
- Ojas Thakur
- Ojas Tripathi
- Ojaswini Bajaj
- Ola Coats
- Olando Martin
- Olene Lofton
- Olga Gil
- Olive Marsh
- Olive Moore
- Oliver Adams
- Oliver Dalton
- Oliver Davis
- Oliver Dunbar
- Oliver Fincher
- Oliver Frakes
- Oliver Haghi
- Oliver Hardy
- Oliver Hedges
- Oliver Jenkins
- Oliver Johnston
- Oliver Jones
- Oliver Stone
- Oliver Williams
- Oliver Young
- Olivia Adams
- Olivia Cunningham
- Olivia Graham
- Olivia Hooper
- Olivia Johnson
- Olivia Kramer
- Olivia Swanson
- Ollie Gill
- Ollie Hall
- Ollie Mcneil
- Ollivier Hawthorne
- Om Chawla
- Oma Yost
- Omari Hurley
- Omer Cabrera
- Omkar Nath
- Omprakash Sehgal
- Ophelia Burgess
- Ophelia Burnett
- Ophelia Pereira
- Ophelia Saunders
- Ora Li
- Oralia Zepeda
- Oren Battle
- Orion Gutierrez
- Orson Ross
- Oscar Alvarez
- Oscar Cross
- Oscar Johnson
- Oscar Matthews
- Oscar Moore
- Oscar Pole
- Oscar Watson
- Osmond Lynch
- Ossie Hinds
- Osvaldo Cantu
- Otha Whitney
- Otis Cardenas
- Otto Thomson
- Owen Abraham
- Owen Chase
- Owen Clark
- Owen Cooper
- Owen Horne
- Owen Morales
- Owen Moran
- Owen Thompson
- Ozell Benedict
- Ozella Huston
- Pablo Avery
- Pablo De Souza
- Pablo Rickman
- Padam Rao
- Padmini Gosh
- Padmini Pandey
- Page Redding
- Paige Tucker
- Pakhi Laghari
- Palash Agnihotri
- Pallavi Jha
- Pam Kellner
- Pamila Finney
- Pamula Huntley
- Pandit Narayan
- Pankaj Trivedi
- Panshul Shenoy
- Pansy Humphries
- Paolo Lindhagen
- Parag Arya
- Parag Mehta
- Parag Sidhu
- Paramita Basu
- Paramjeet Sodhi
- Paramjit Kang
- Parampara Tiwari
- Paramvir Malhi
- Paramvir Nanda
- Paras Dhawan
- Parikshit Das
- Parikshit Sanghvi
- Parineeti Chauhan
- Paris Barry
- Paris James
- Paritosh Mehta
- Parker Cruse
- Parnika Bhatnagar
- Paromita Banerjee
- Parteek Hans
- Parth Gohil
- Parth Jindal
- Partha Chakma
- Partha Deb
- Parthenia Braxton
- Parthvi Malhotra
- Particia Malloy
- Parul Gupta
- Parul Patnaik
- Parvaiz Ansari
- Parvathy Kaushik
- Parveen Chatterjee
- Parvesh Bava
- Parvez Baig
- Parvez Malik
- Pascal Formann
- Pasquale Faulkner
- Pasty Smalls
- Pat Jordan
- Pat Richmond
- Patricia Baker
- Patricia Church
- Patricia Ramsey
- Patricia Sachs
- Patrick Clinton
- Patrick Coulson
- Patrick Faraday
- Patrick Garter
- Patrick Hall
- Patrick Lampard
- Patrick McCann
- Patrick Spencer
- Patsy Edmondson
- Patti Fagan
- Paul Cooper
- Paul Coronado
- Paul Curtis
- Paul Davis
- Paul Hiddleston
- Paul Mahoney
- Paul Patterson
- Paul Spencer
- Paul Stanley
- Paul Vernon
- Paul Wrigley
- Paula Morgan
- Paula Schuster
- Paula Sutherland
- Paula Sutton
- Paula Wallace
- Paula Willoughby
- Paulita Goldsmith
- Paulo Hutchinson
- Pavitra Mathur
- Pawan Chaturvedi
- Pawan Mehra
- Paxton Byrne
- Payal Khatri
- Pearl Hunter
- Pearl Yates
- Pedro Cahill
- Peehu Khandekar
- Peggy Cameron
- Peggy Rusk
- Peggy Sparks
- Penelope Clark
- Penelope Higgins
- Penelope Maynard
- Penelope Payne
- Penelope Williams
- Penny Summers
- Percival Rooser
- Percy Hugo
- Percy Shields
- Percy Valentine
- Percy Vaughn
- Perry Stinson
- Pete Edner
- Pete Fesperman
- Pete Holden
- Pete McCall
- Peter Banks
- Peter Garner
- Peter Haddock
- Peter Hanson
- Peter Hayes
- Peter Holmes
- Peter Jones
- Peter Kemp
- Peter Mackintosh
- Peter Mejia
- Peter Pearson
- Peter Ponce
- Peter Spencer
- Peter Wright
- Peter Wyatt
- Peyton Leung
- Peyton Turner
- Phil Vowles
- Philburt Moore
- Philip Chiders
- Philip Clift
- Philip Newsom
- Philip Rudolf
- Philip Webster
- Phillip Hewitt
- Phillip Lawson
- Phillis Carrier
- Phineas Herrera
- Phoebe Gates
- Phoebe Pride
- Phoenix McWilliams
- Phung Naquin
- Phylis Bliss
- Phyllis Bates
- Picard Henderson
- Pierce Stubbs
- Pierre Moreau
- Pierre Simone
- Piers Jackson
- Pieter Eagleman
- Pihu Puri
- Pihu Sengupta
- Piper Tilton
- Pipli Datta
- Piyush Malkhani
- Polly Leary
- Pooja Chabra
- Pooja Luthra
- Pooja Rawat
- Poonam Sarma
- Poornima Vaidya
- Poorva Jain
- Poorvi Menon
- Poppy Scott
- Porter Dolan
- Praanshu Nagar
- Prabhakar Shetty
- Prabhas Sundaram
- Prabhat Nagar
- Prabhat Reddy
- Prabhdeep Padda
- Prabhjot Chhina
- Prabir Mukherjee
- Prabodh Bakshi
- Pracheta Chawla
- Prachi Das
- Prachi Vasistha
- Pradeep Chandra
- Pradeep Kandpal
- Pradipta Sethia
- Praful Sahni
- Prafula Das
- Pragati Bajwa
- Pragya Agarwal
- Pragya Kapoor
- Prajul Nayar
- Prakash Chandola
- Prakash Iyer
- Prakash Khetani
- Prakash Nigam
- Prakhar Gupta
- Prakruthi Shekhawat
- Pramesh Mukherjee
- Pramod Kumar Singh
- Pramoth Maheshwari
- Pranav Ashley
- Pranav Swarup
- Pranavi Hans
- Pranay Laghari
- Pranay Malhan
- Pranay Pandey
- Pranidhi Malhotra
- Pranisha Jaiswal
- Pranit Mallick
- Pranjal Dahiya
- Pranjal Prasad
- Pranjit Barman
- Prarthana Jha
- Prarthna Singh
- Prasanna Rajput
- Prasanta Dutta
- Prashant Prabhu
- Prashant Singh
- Prasun Agnihotri
- Prateek Saluja
- Prateeksha Wadhwa
- Pratha Parekh
- Prathaa Srivastava
- Pratibha Kumari
- Pratibha Sinha
- Pratigya Yadav
- Pratik Kansal
- Pratik Roy
- Pratiksha Khanna
- Pratiksha Parikh
- Pratima Chakraborty
- Pratima Nagar
- Pratishtha Mehra
- Prativa Rajan
- Pratyush Dubey
- Pratyush Mathur
- Pravasthik Joshi
- Pravat Vyas
- Praveen Dhumal
- Praveen Kapadia
- Praveena Bajwa
- Pravisht Gaur
- Prayag Rawat
- Precious Bertrand
- Preet Jaiswal
- Preetha Awasthi
- Preeti Desai
- Preeti Gupta
- Preeti Sharma
- Preetjot Jaiswal
- Preeto Lamba
- Preetpal Bhatia
- Prem Jaiswal
- Prema Hans
- Premankur Ganguly
- Premendra Bajwa
- Prerna Dua
- Prerna Kohli
- Preshtha Luthra
- Presley Haywood
- Preston Bailey
- Preston Hatfield
- Preston Hickey
- Preston Lloyd
- Preston Runner
- Prince McCurdy
- Prince Salazar
- Princeton Brown
- Prisha Deshmukh
- Prisha Mahajan
- Pritam Baring
- Pritam Bhattacharya
- Pritam Chakma
- Pritam Dhaliwal
- Pritam Jamatia
- Pritam Khurana
- Pritam Mann
- Pritam Mehta
- Pritam Shetty
- Pritam Tripura
- Pritha Grewal
- Prithika Kashyap
- Prithvi Brar
- Prithvi Tuli
- Priya Taneja
- Priyamani Pandey
- Priyanaka Sood
- Priyanka Chillar
- Priyanka Deb
- Priyanka Khanduja
- Priyanka Menon
- Priyanka Tripura
- Priyanshu Lokhande
- Priyanshu Madan
- Priyasha Sagar
- Professor Manoranjan Prasad Sinha
- Puja Srivastava
- Pulak Bhattacharya
- Puneesh Shinde
- Puneet Chandra
- Puneet Dev
- Puneet Uppadhyay
- Punith Shinde
- Purbi Deshmukh
- Pushkar Tandon
- Qaiser Miraj
- Qayyum Lone
- Qiana Keenan
- Queenie Waldron
- Quentin Hardy
- Quentin Merton
- Quiana Esposito
- Quincy Spears
- Quincy West
- Quinn Coyle
- Quinn Livingston
- Quinten Bean
- Quyen Lassiter
- Raag Mishra
- Raagini Basu
- Raahil Mustafa
- Raanish Purohit
- Rachal Parra
- Rachana Sarma
- Racheal Geiger
- Rachel Dell
- Rachel Santiago
- Rachell Hawkins
- Rachna Chaturvedi
- Rachna Gill
- Radha Talukdar
- Radley Harwood
- Rae Babb
- Raeann Denny
- Raegan Freitas
- Rafael Barrett
- Rafael Bryan
- Rafael Nash
- Rafael Wagner
- Rafe Shaw
- Rafe Wallace
- Rafferty Webster
- Raghav Jain
- Raghav Pandey
- Raghavendran Adiga
- Raghu Aggarwal
- Raghubir Malhotra
- Raghunandan Arya
- Raghuram Mangal
- Raghuram Mehta
- Raghuveer Dayal
- Ragii Apte
- Ragish Bakshi
- Ragnar Hart
- Ragvinder Dutta
- Raheem Khan
- Rahil Seth
- Rahini Rao
- Rahitya Parmar
- Rahul Behl
- Rahul Desai
- Rahul Kaushik
- Rahul Sinha
- Rahulkrishna Purohit
- Raiden Carmichael
- Raima Gaikwad
- Raina Khanna
- Rajamohan Bhandari
- Rajan Gaur
- Rajani Ali
- Rajarshi Awasthi
- Rajas Irani
- Rajat Bordoloi
- Rajat Shetty
- Rajdip Dewan
- Rajeet Batra
- Rajeev Bhatia
- Rajeev Guha
- Rajeev Rathore
- Rajendar Jain
- Rajendra Gogoi
- Rajendra Kapadia
- Rajendran Parekh
- Rajesh Bhalla
- Rajeshwari Jain
- Rajeshwari Reddy
- Rajhans Varma
- Rajinder Rana
- Rajinder Uppal
- Rajini Anand
- Rajmohan Thakur
- Rajshri Ahuja
- Rajvika Awasthi
- Rakesh Chauhan
- Rakesh Kumar
- Rakesh Lodhi
- Rakesh Yadav
- Raksha Dubey
- Raksha Dwivedi
- Rakshita Apte
- Rakshya Bakshi
- Rakti Giri
- Ralph Allen
- Ralph Becker
- Ralph Borsella
- Ralph Bowen
- Ralph Britton
- Ralph Hunt
- Ralph McClane
- Ralph Owens
- Ralph Rivers
- Ralph Seguin
- Ralph Walton
- Ram Goswami
- Rama Joshi
- Ramakaant Singh
- Raman Mehta
- Ramanand Chopra
- Ramesh Bhatt
- Ramesh Deshmukh
- Ramon Chalkley
- Ramon Walls
- Ramona Howell
- Ramonita Lujan
- Ramya Kant
- Ranbir Rao
- Randa Whitt
- Randall Bartlett
- Randall Calloway
- Randall Fletcher
- Randall Hubner
- Randhir Deol
- Randhir Panesar
- Randhir Somal
- Randy Dodd
- Ranee Christiansen
- Rani Chowdhury
- Ranjan Gill
- Ranjeet Bakshi
- Ranjeet Kapadia
- Ranjeet Pahwa
- Ranjit Jassar
- Ranjit Multani
- Ranjita Ray
- Ranju Banerjee
- Ranvith Irani
- Ranya Agrawal
- Rapheal Dagget
- Raquel Pannell
- Rashid Kaif
- Rashika Kapadia
- Rashika Rao
- Rashmi Chopra
- Rashmi Wadia
- Rashmika Gupta
- Ratan Jhaveri
- Rati Chatterjee
- Ratika Thakur
- Ratna Seth
- Ratnapriya Reddy
- Ratul Dey
- Raunak Shikhawat
- Raunit Naagar
- Raveena Das
- Raven Brennan
- Raven Spoon
- Ravi Deb
- Ravi Patel
- Ravikirti Tiwari
- Ravina Kishore
- Ravinder Kaler
- Ravinder Rai
- Ravinder Sidhu
- Ravindra Mishra
- Ravindranath Gupta
- Ravneet Rana
- Ray Anton
- Ray George
- Ray Keller
- Ray Phillips
- Ray Shannon
- Rayaan Das
- Rayaana Bashir
- Rayan Williamson
- Raye Jack
- Rayford Ayers
- Raymon Carrillo
- Raymond Finn
- Raymond Foster
- Raymond Mccall
- Raymond Stevens
- Raymonde Matos
- Rayna Stewart
- Reagan Cairns
- Reagan Spooner
- Reagen Hu
- Reanna Strand
- Reatha Bain
- Rebecca Cross
- Rebecca Mayfield
- Rebecca Sharp
- Rebecca Tribiani
- Rebecca Williams
- Reece Hall
- Reece Hughes
- Reed Hamilton
- Reed Spears
- Reeha Begum
- Reena Huddleston
- Reese Burnett
- Reese Trujillo
- Reeta Kashyap
- Reeyansh Majumdar
- Refugio Negron
- Refugio Nixon
- Regan Knight
- Regenia Goddard
- Reggie Bing
- Regina Cobb
- Regina Stuart
- Reginald Berger
- Reginald Matthews
- Reginald Thornburg
- Rehaan Ali
- Rehman Ebrahim
- Reid Barnes
- Reilly Mcclure
- Reilly Richie
- Reina Soares
- Rekha Borah
- Rema Stovall
- Remington English
- Remington Porter
- Remy Bowen
- Renae Russell
- Renaldo Marks
- Renate Herrera
- Renate Hope
- Renato Rojas
- Rene Sava
- Rene Stephenson
- Renee Mangla
- Renesmae Wood
- Renetta Stahl
- Renit Shukla
- Renita Lusk
- Renna Madrid
- Renu Goswami
- Renu Singh
- Reshika Kohli
- Ressie Kincaid
- Reta Staples
- Reuben Chapman
- Reuben Hammond
- Reuben Knox
- Reuben Parker
- Reuben Tidwell
- Revansh Joshi
- Rex Henson
- Rex Slavin
- Rex Turner
- Rey Hendricks
- Reyansh Kashyap
- Reyhaana Qadri
- Reyna Archibald
- Reynaldo Merritt
- Rheba Shipley
- Rheeya Ray
- Rhett McAllister
- Rhett Wilkinson
- Rianna Goad
- Ricardo Clinton
- Ricardo Smith
- Rich Carey
- Rich Falcon
- Richa Mohanty
- Richard Arber
- Richard Blackett
- Richard Burrows
- Richard Gray
- Richard Hackett
- Richie Montoya
- Rick Jacobs
- Rick Thomas
- Ricki Mccracken
- Rickon Hamill
- Ricky Blankenship
- Ricky Nicholson
- Ricky Parks
- Ricky Peyret
- Rico Dewar
- Rida Qureshi
- Riddhi Jain
- Riddhima Chopra
- Ridham Raj
- Ridhhesh Prasad
- Ridhi Patel
- Ridit Chaddha
- Ridit Dholakia
- Rigesh Irani
- Rikki Kearney
- Riley Lewis
- Riley Tate
- Rima Chakraborti
- Rimi Arya
- Rimsha Hasan
- Rina Boro
- Rina Chin
- Rina Gulati
- Rina Jamatia
- Rinish Pandey
- Rinshi Raj
- Ripa Apte
- Ripanshi Chopra
- Ripley Snyder
- Ripu Mukherjee
- Risa Lundy
- Risanth Apte
- Rishabh Dayal
- Rishabh Shingari
- Rishabh Thakral
- Rishav Nikumbh
- Rishika Bhalla
- Rishika Bhatia
- Rishika Kamaan
- Rishima Ahuja
- Rishipriya Guha
- Rishit Mann
- Rishita Mehta
- Rita Lamotta
- Ritajit Ahuja
- Ritesh Joshi
- Ritesh Mohan
- Rithik Sachdev
- Rithika Jha
- Rithvi Parekh
- Ritik Chauhan
- Ritshika Sharma
- Rituja Menon
- Rituparno Mukherjee
- Ritvik Chandra
- Ritvik Vyas
- Riva Mirza
- Riya Deshmukh
- Riya Kadam
- Riya Somani
- Riyaaz Irani
- Riyanshi Pandey
- Rizvi Shah
- Rob Boxer
- Rob Bullock
- Rob Ferrier
- Rob Hanson
- Rob Koslowski
- Rob McCabe
- Robbie Engle
- Robbie Faulkner
- Robbie Hess
- Robbie Larkin
- Robby Duran
- Robbyn Kauffman
- Robert Barker
- Robert Berry
- Robert Campbell
- Robert Dominguez
- Robert Fitt
- Robert Henderson
- Robert Khan
- Robert Meyer
- Robert Miller
- Robert Webster
- Roberta Hansen
- Roberta Powell
- Roberta Purvis
- Roberta Wallace
- Roberto Forbes
- Roberts Goddings
- Robin Deaver
- Robinson Bird
- Robt Wiley
- Robyn Dugger
- Rochel Woodson
- Rochell Wolff
- Rocky Burns
- Rod Mueller
- Roderick Hartman
- Roderick Swayne
- Rodger Olsen
- Rodney Lappin
- Rodrick Keith
- Rodrigo Herrera
- Rodrik Ledger
- Rogelio Glenn
- Roger Carroll
- Roger Conway
- Roger Creed
- Roger Greer
- Roger Hoover
- Roger Mostafa
- Roger Simpson
- Roger Strickland
- Roger Williams
- Roger Wright
- Rohail Sheikh
- Rohan Kumar
- Rohini Bawa
- Rohini Yadav
- Rohit Bhatnagar
- Rohit Kumar
- Rohit Rajput
- Roland Chan
- Roland Graves
- Roland Snow
- Roland Winters
- Roman Campbell
- Roman Fritz
- Roman Gustin
- Roman Morris
- Romana Woods
- Romelia Clinton
- Romeo Hughes
- Romie Pearson
- Romila Pradhan
- Romir Chopra
- Romy Cooper
- Ron Nucci
- Ron Schultz
- Ronald Graves
- Ronald Hogan
- Ronald Tripp
- Ronaldo Wiggins
- Ronan Fernandez
- Ronan Holland
- Ronan Parker
- Ronan Shaffer
- Ronin Massey
- Ronni Schmitz
- Ronnie Elliott
- Ronnie Granger
- Roohi Datta
- Roop Thakur
- Roopa Sethi
- Roopam Acharya
- Roopshri Bhosle
- Roose Ware
- Rory Austin
- Rory Cox
- Rory Curtis
- Rory Dixon
- Rory Morris
- Rory Nolan
- Rory Peterson
- Rosa Leigh
- Rosabella Moore
- Rosalba Winkler
- Rosalee Bateman
- Rosalia Lacey
- Rosalina Peters
- Rosalina Samuel
- Rosalind Lake
- Rosalind Stallings
- Rosalyn Whalen
- Rosamaria Shapiro
- Rosamond Woody
- Rosanna Mann
- Rosario Dominguez
- Rosario Douglas
- Rosario Goldman
- Rosario Harrington
- Rose Bell
- Rose Mcvey
- Rose Torres
- Rose Watson
- Roselee Suggs
- Roselia Bautista
- Roseline Calloway
- Roselle Rosen
- Roselyn Moseley
- Rosemary Charles
- Rosena Mcnair
- Roshika Chowdhury
- Roshni Desai
- Roshni Kumar
- Rosie Burton
- Roslyn Eubanks
- Ross Beckett
- Ross Bell
- Ross Gibson
- Rossana Roper
- Rossie Engel
- Rowan Cook
- Rowan Jordon
- Rowan Owens
- Rowan Reyes
- Rowan Skinner
- Rowan Sutherland
- Rowland Wilson
- Roxana Stacey
- Roxane Darnell
- Roxanna Cody
- Roxanne Stevens
- Roxy Guidry
- Roy Marcus Cohn
- Roy McClen
- Roy Tucker
- Royal Randall
- Royce Shaw
- Royce Sutton
- Rubaina Amin
- Ruben Hawkins
- Rubie Felton
- Rubin Espinoza
- Ruby Edwards
- Ruby Ford
- Ruby Long
- Rudd Deakins
- Rudi Ritchie
- Rudolf Acosta
- Rudolph Dickerson
- Rudra Chaudhary
- Rudra Kaushal
- Rudransh Solanki
- Rudy Fletcher
- Rudy Whyte
- Rudy Willis
- Rueben Ayala
- Rufus Gates
- Rufus Mitchell
- Rufus Stafford
- Rukmaan Khan
- Rukmini Rao
- Rumaisa Rabbani
- Rupal Das
- Rupali Kalita
- Rupali Natt
- Rupali Pathak
- Rupali Verma
- Rupert Collier
- Rupert Condron
- Rupert Fry
- Rupert Kennedy
- Rupert Paul
- Rupert Preston
- Rupesh Bahuguna
- Rupesh Deol
- Rupesh Mishra
- Rushali Nigam
- Rushel Davis
- Rushika Chauhan
- Rushya Mishra
- Russ Cochran
- Russel Odonnell
- Russell Mikel
- Russell Princeton
- Russell Sands
- Russell Santiago
- Rustam Irani
- Rusty Wilcox
- Ruth Brown
- Ruth Clark
- Ruth Hinrichs
- Ruti Rao
- Ryan Cusden
- Ryan Desario
- Ryan Jaxon
- Ryan Jones
- Ryan Loren
- Ryan Matthews
- Ryan McNeil
- Ryan Tandon
- Ryan Webber
- Ryan White
- Ryder Arsenault
- Ryder Dixon
- Ryder Wright
- Ryker Levine
- Ryker Nelson
- Rylan Allison
- Rylan Beckham
- Rylan Dyer
- Rylan Hayes
- Rylee Phelps
- Rylee Swan
- Ryleigh Mattison
- Ryley Collier
- Ryna Sahu
- Saanjh Sharma
- Saavini Nikumbh
- Saba Ali
- Saba Chatterjee
- Sabastian Hogan
- Sabhir Shukla
- Sabra Haskins
- Sabrina Hunt
- Sacha Bassett
- Sachet Mukherjee
- Sachiko Woodson
- Sachin Gaitonde
- Sadashiv Thapar
- Sadhita Deol
- Sadhna Gokhale
- Sadhvi Raj
- Sadie Ammons
- Sadye Stiles
- Saesha Awasthi
- Sagar Barot
- Sagar Israni
- Sagar Thakkar
- Sage Bolduc
- Sahana Bajaj
- Saharsh Zariwala
- Sahibjit Kamte
- Sahil Gole
- Sahil Yadav
- Sahyadri Sethi
- Sai Kumar
- Saige Clough
- Saima Kapoor
- Saima Rao
- Saira Garg
- Sajal Yadav
- Sajita Chauhan
- Saksham Saini
- Sakshima Gill
- Saleem Khan
- Sally Custer
- Sally Renwick
- Salma Begum
- Salome Scruggs
- Saloni Gupta
- Saloni Kaur
- Salvador Flores
- Salvador Mathis
- Salvador Poole
- Salvatore Cortez
- Sam Garfield
- Sam Hurd
- Sam Jones
- Sam Lehmann
- Sam O'Donovan
- Sam Raleigh
- Sam Revere
- Samaira Chhabra
- Samairaa Chaturvedi
- Samairah Sheikh
- Samantha Granger
- Samantha Morales
- Samar Dev
- Samar Malhotra
- Samara Beers
- Samara Bose
- Samarth Giri
- Samarth Saxena
- Samatha Epps
- Sambit Parmar
- Sameera Jain
- Sameera Patel
- Samella Haywood
- Samidha Reddy
- Samir Lamb
- Samira Joshi
- Sampath Garg
- Sampurna Pal
- Samrat Chaturvedi
- Samriddhi Singh
- Samson Colon
- Samson Figueroa
- Samuel D'costa
- Samuel Golding
- Samuel Morgan
- Samuel Ostroff
- Samuel Palmer
- Samuel Robertson
- Samuel Wallace
- Samvrutha Seth
- Samyukta Dhawan
- Sanat Bhattacharya
- Sanatana Reddy
- Sanay Shinde
- Sanchit Agarwal
- Sanchita Ghoshal
- Sanda Devine
- Sandee Prater
- Sandeep Deb
- Sandeep Ghosh
- Sandeep Reddy
- Sandhya Rastogi
- Sandhya Rathi
- Sandhya Shukla
- Sandie Grove
- Sandra Lekin
- Sandra McLeish
- Sandy Patrick
- Saneesh Panikker
- Sang Park
- Sangam Shirke
- Sangeeta Kumari
- Sangeeta Saikia
- Sangini Chauhan
- Sanhita Gulati
- Sanindita Arun
- Sanjana Bajaj
- Sanjana Dewan
- Sanjana Gupta
- Sanjana Rana
- Sanjay Mehta
- Sanjay Reang
- Sanjay Shrivastava
- Sanjay Singhal
- Sanjeeda Abbas
- Sanjeev Bhatt
- Sanjeev Gaikwad
- Sanjeev Reddy
- Sanjeev Shukla
- Sanjoli Kapadia
- Sansa Gilbert
- Santana Platt
- Santiago Christian
- Santiago Dawber
- Santiago Sharp
- Santina Biggs
- Santo Owen
- Santosh Dhirwan
- Sanuja Patel
- Sanvi Kori
- Sapna Jain
- Sapna Kulkarni
- Sapphire Paige
- Saqib Siddiqui
- Sarabjit Seth
- Sarah Crowe
- Sarah Gates
- Sarah Lancaster
- Sarah Lombard
- Sarah Luck
- Sarah Scott
- Saraswati Saikia
- Sarayu Tandon
- Sarbjit Baring
- Sarbjit Khera
- Sareeka Goswami
- Sareesh Chauhan
- Sargam Goel
- Sargun Kulkarni
- Sarika Rohidas
- Sarish Naidu
- Sarita Gogoi
- Saroj Ghosh
- Sarojini Sinha
- Sarthak Bajwa
- Sarthak Patel
- Sarvesh Khanna
- Sasha Kremke
- Sasha MacLeod
- Sasha Ortega
- Sashant Das
- Sasmit Aneja
- Satheesh Majhi
- Sati Kalal
- Satish Burman
- Satpal Chaudhary
- Satrajit Dara
- Satwinder Gill
- Satwinder Rana
- Satya Prakash
- Satya Shukla
- Satyajit Khanna
- Satyajit Sharma
- Satyam Maane
- Satyapriya Seth
- Satyarth Gill
- Satynam Kulhari
- Saudeep Aneja
- Saugandhika Kothari
- Saukhya Nair
- Saul Brock
- Saul Jacobi
- Saul Rowen
- Saumitra Jha
- Saumy Chopra
- Saumya Gandhi
- Saurabh Mann
- Saurabh Verma
- Saurabhi Das
- Saurav Kumar
- Savanah Ma
- Savanna Moreau
- Savion Mccormick
- Savit Chhabra
- Savita Sharma
- Savitri Rout
- Sawyer Combs
- Sawyer Lopez
- Sayantani Barman
- Sayli Jain
- Scarlet Cormier
- Scarlett Beckinsale
- Scarlett Parry
- Scarlett Santos
- Scott Buchanan
- Scott Carter
- Scott Crosby
- Scott Crowley
- Scott Gibson
- Scott Henderson
- Scott Sullivan
- Sean Boyd
- Sean Brisley
- Sean Burkett
- Sean Eastwood
- Sean Fraser
- Sean Gunner
- Sean Hart
- Sean Keegan
- Sean Layman
- Sean Willard
- Sebastian Brown
- Sebastian Driussi
- Sebastian Jones
- Sebastian Moore
- Sebastian Turner
- Sebrina Wesley
- Seema Gupta
- Seema Melvin
- Sehej Thapar
- Sehmat Syed
- Sejal Shah
- Selena Ellison
- Selena Truitt
- Selina Douglas
- Senthil Subramaniam
- Serena Gibson
- Serenity Oswald
- Serina Salgado
- Seth Cohen
- Seth Cole
- Seth Grattan
- Seth Royal
- Setu Kurup
- Seymor White
- Sha Cano
- Shabareesh Menon
- Shad Colon
- Shafqat Azmi
- Shahbaaz Fawaz
- Shahid Afridi
- Shahraan Qasim
- Shahzan Syed
- Shailja Ghose
- Shakeel Hussain
- Shakia Dewitt
- Shakita Messer
- Shakthi Jain
- Shala Irvin
- Shalini Menon
- Shamar Saunders
- Shan Castle
- Shana Henley
- Shanaya Sharma
- Shandi Dupree
- Shane Doyle
- Shane Kern
- Shane Lozano
- Shane Parsons
- Shane Simpson
- Shanel Carmichael
- Shanell Betts
- Shanelle Marino
- Shani Lange
- Shania Gomes
- Shania Treadwell
- Shanita Aldridge
- Shanmugam Rao
- Shannon Baker
- Shannon Council
- Shannon Klemm
- Shannon Richardson
- Shanta Raines
- Shantae Leal
- Shantanu Bhardwaj
- Shantanu Deb
- Shantanu Mishra
- Shantanu Tripura
- Shantell Crowder
- Shanti Nikumbh
- Shantipriya Sinha
- Shanu Chaudhary
- Shaquita Bernal
- Sharan Stover
- Sharee Meredith
- Sharice Land
- Sharif Aslam
- Sharika Lund
- Sharika Rohidas
- Sharleen Quintero
- Sharlene Boswell
- Sharlton Pierce
- Sharmila Debbarma
- Sharmila Jamatia
- Sharmila Talukdar
- Sharmishta Mistry
- Sharolyn Edmonds
- Sharon Garner
- Sharon Levine
- Sharon Manuel
- Sharon Tatum
- Sharonda Richter
- Sharri Hannah
- Sharvi Dutt
- Sharyn Dunham
- Shashank Naik
- Shashi Pillai
- Shashilekha Dagar
- Shashwat Jindal
- Shaun Grantham
- Shaun Robson
- Shaun Tyler
- Shauna Thomason
- Shaunte Colbert
- Shaurya Patra
- Shaurya Rathod
- Shavonne Meza
- Shawanda Singh
- Shawn Guy
- Shawn Kiser
- Shawn Marshall
- Shawn McLean
- Shawn Sandoval
- Shawn Sheehan
- Shawna Hutchings
- Shawnda Lovell
- Shay Carlton
- Shay Fisher
- Shayne Lindsey
- Shayne Milligan
- Sheehan Mahajan
- Sheetal Bansal
- Sheila Gable
- Sheila Reid
- Sheilah Frey
- Shekhar Biswas
- Shekhar Madan
- Shela Pineda
- Shelby Osborne
- Sheldon Davis
- Shelia Reece
- Shella Greenwood
- Shelley Gunn
- Shelley Jones
- Shelley Lynch
- Shelli Teague
- Shemeka Amos
- Shenna Latham
- Sheri Dubois
- Sherika Mcelroy
- Sherley Benson
- Sherlyn Byrne
- Sherlyn Madan
- Sheron Snell
- Sherri Ivey
- Sherrie Bergeron
- Sherron Cuevas
- Sherry Goins
- Sheryl McMillan
- Shewta Tripathi
- Shikha Reddy
- Shikha Sinha
- Shikhar Singh
- Shiksha Arya
- Shiladitya Ghosh
- Shiloh Nix
- Shilpa Dhillon
- Shilpa Gogoi
- Shilpa Nair
- Shilpa Tejwani
- Shipra Mehta
- Shipra Yadav
- Shira Shafer
- Shireesh Gamit
- Shirin Dutta
- Shirleen Christopher
- Shirley Doy
- Shirley Striker
- Shishir Roy
- Shital Gupta
- Shiva Kapur
- Shivaant Ghosh
- Shivakshi Chauhan
- Shivalika Ray
- Shivam Maurya
- Shivam Pillai
- Shivangi Goswami
- Shivani Tendulkar
- Shivansh Khurana
- Shivashish Patel
- Shivaya Mehra
- Shivendra Madaan
- Shivesh Khanna
- Shivin Ahuja
- Shivleekha Aneja
- Shivraj Das
- Shizuko Worley
- Shoaib Ali
- Shobha Apte
- Shobha Deka
- Shobhika Puro
- Shobhita Yadav
- Shraddha Gaikwad
- Shraman Dwivedi
- Shravan Ambedkar
- Shravi Giri
- Shravya Sachdev
- Shree Balakrishnan
- Shresth Shroff
- Shreya Karak
- Shreya Soliz
- Shreyansh Desai
- Shreyasi Gupto
- Shreyovi Das
- Shritiman Hedao
- Shruthakirti Bhede
- Shruthi Rao
- Shubashish Khanna
- Shubh Goswami
- Shubhada Chillar
- Shubham Chauhan
- Shubham Thakur
- Shweta Sehrawat
- Shyam Bhardwaj
- Shyam Sanghvi
- Shyam Sehgal
- Shyama Pandey
- Shyla Cramer
- Sibyl Plummer
- Sid Hodges
- Siddharth Garg
- Siddharth Gokhale
- Siddharth Mahajan
- Siddhi Malhotra
- Sidney Alvarado
- Sidney Berry
- Sidney Forsyth
- Sidney Gillespie
- Sienna Baker
- Sienna Cole
- Sienna Perry
- Sienna West
- Sierra Adkins
- Sierra Montague
- Sikandar Qazi
- Silas Burke
- Silas Kearns
- Silas Maldonado
- Sima Butts
- Sima Chakma
- Sima Deb
- Simarjeet Singh
- Simon Benson
- Simon Bishop
- Simon Byrd
- Simon Doyle
- Simon Oakenfold
- Simon Pade
- Simran Kapoor
- Simran Verma
- Simranjit Sandhu
- Simrat Tripathi
- Sindy Dunbar
- Siobhan Maloney
- Sirisha Mehta
- Sky Malloy
- Skye Carl
- Skylar Forrester
- Skylar Green
- Skylar Ortega
- Skylar Patton
- Skylar Washington
- Skyler Higdon
- Skyler Hopkins
- Skyler Wade
- Slade Decker
- Slaton Channing
- Slyvia Hollis
- Smirit Dalal
- Smita Kalita
- Smith Paul
- Smrita Bhatt
- Sneha Mehta
- Sneha Tripura
- Snehashish Sadhwani
- Sofia Lynch
- Solomon Culver
- Solomon Fleming
- Solomon Geller
- Solomon Hershel
- Solomon Stevens
- Solomon Townsend
- Solomon Willis
- Somdev Patel
- Sommer Mcginnis
- Somya Gupta
- Son Cannon
- Sonal Shrivastava
- Sonia Kawatra
- Sonja Simms
- Sonny Lin
- Sophia Campbell
- Sophia Johnson
- Sophia Nelson
- Sophia Reid
- Sophia Walker
- Sophie Collins
- Sophie Morris
- Sophie Silva
- Soumil Dedhia
- Soumya Desai
- Sourabh Tiwari
- Spencer Blair
- Spencer Chinn
- Spencer Wells
- Spruha Goswami
- Srihari Tandon
- Srikanth Mukherjee
- Sriram Dev
- Sriranjan Thakur
- Srishti Motwani
- Srishti Vasan
- Srivardhana Giri
- Stacey Cordell
- Stacey Patton
- Stacy Escobar
- Stacy Keach
- Stacy Rodgers
- Stacy Spoon
- Stan Daniel
- Stanford Glover
- Stanford Hinson
- Stanislaw Donald
- Stanley Cain
- Stanley Harmon
- Stanley Hill
- Stanley West
- Stanton Farmer
- Starla Costa
- Stefan Jenkins
- Stefani Springer
- Stefanie Childers
- Stella Lee
- Stella Osborne
- Stella Stephenson
- Stephani Reyna
- Stephanie Fraser
- Stephanie Madison
- Stephanie Pendergrass
- Stephen Baggins
- Stephen Hayes
- Stephen Holland
- Stephen Louis
- Stephen Mason
- Stephen Morris
- Stephen Rogers
- Stephnie Rosado
- Sterling Macmillan
- Sterling Santos
- Steve Bailey
- Steve Folger
- Steve Holden
- Steven Butler
- Steven Cook
- Steven Graham
- Steven Gray
- Steven Notley
- Steven Reeves
- Steven Tiff
- Steven Villanueva
- Stewart Griffith
- Stewart Johnston
- Stivie Fox
- Stone Hines
- Stormy Lozano
- Stuart Barber
- Stuart Carey
- Stuart Cooper
- Stuart Gates
- Stuti Garg
- Stuti Mohanty
- Suanne Yarbrough
- Subhashini Sastry
- Subhasis Bhattacharya
- Subhasis Pal
- Subhojit Kumar
- Subhradeep Sen
- Subin Deshmukh
- Subodh Sapru
- Suchir Pandey
- Suchit Goswami
- Suchitra Batra
- Sudeep Negi
- Sudesh Kalra
- Sudhanshu Gupta
- Sudhanshu Khatri
- Sudhanshu Pandit
- Sudhiksha Nayar
- Sudhir Chauhan
- Sudhir Kumar
- Sudie Pearce
- Sudiksha Sant
- Sue Gold
- Suede Crawford
- Suhag Gill
- Suhana Taneja
- Sujata Pandey
- Sujay Kumar
- Sujeet Kamte
- Sujit Gola
- Sujit Kumar Pandey
- Sukanya Barman
- Sukeerti Burman
- Sukhbir Khera
- Sukhbir Rathore
- Sukhdev Grewal
- Sukhdev Kaniyar
- Sukhwant Gaba
- Sukhwinder Sekhon
- Sukhwinder Walia
- Suksham Aggarwal
- Sulekha Sood
- Sulema Dougherty
- Sullivan Princeton
- Sulochana Nair
- Suman Gogoi
- Suman Sikka
- Sumayya Shah
- Sumedh More
- Sumedha Madaan
- Sumeet Bhattacharya
- Sumesh Khatri
- Sumiko Boggs
- Sumit Arya
- Sumitra Biswas
- Summer Conroy
- Summer Goodwin
- Summer Nolan
- Summer Stewart
- Summer Walter
- Sun Boucher
- Sunanda Jain
- Sunil Chawla
- Sunil Khalsa
- Sunil Thakur
- Sunita Gupta
- Sunita Kalita
- Suparn Ghavri
- Suparna Biswas
- Supreet Sehgal
- Surabhi Arya
- Surabhi Rawat
- Suraksha Kant
- Suresh Deora
- Suresh Naik
- Suresh Nautiyal
- Sureshwar Hegde
- Surjeet Johal
- Surojit Bhattacharya
- Suruchi Bhatnagar
- Surveen Kapoor
- Surya Garg
- Surya Sehgal
- Suryansh Bhasin
- Susan Conway
- Susan Curtis
- Susan Gibbs
- Susan Zucker
- Susannah Rouse
- Susanne Vang
- Susanth Saha
- Sushank Agarwal
- Sushant Nagpal
- Sushanta Bhattacharya
- Sushma Mehta
- Sushma Singhal
- Susie Whitley
- Sutapa Dey
- Suvahhdan Haldar
- Suvarna Baswana
- Suyyash Bhandari
- Suzanna Mcmahon
- Suzanne Barlow
- Suzanne Green
- Suzanne Wiener
- Suzie Hyde
- Suzy Bullock
- Suzy Hill
- Swami Sabharwal
- Swaminathan Kumar
- Swapan Mukherjee
- Swapan Shukla
- Swapn Raj
- Swapna Sarma
- Swapna Tripura
- Swarigini Khanna
- Swarnim Meher
- Swasti Tiwari
- Swastika Shroff
- Swati Basu
- Swati Jaswani
- Swati Sen
- Sweety Solanki
- Swena Lesley
- Sweta Sodhi
- Sybil Foreman
- Sydney Erickson
- Sydney Marsh
- Sydney Moore
- Sydney Schneider
- Sydni Puente
- Sylvester Walsh
- Sylvia Benedict
- Sylvia Dickey
- Sylvia Harlow
- Sylvia Wenzel
- Symon Foster
- Synthia Marker
- Taani Purohit
- Tabatha Hendrix
- Tabetha Head
- Taina Mcleod
- Taisha Carney
- Taksh Singhal
- Takshee Chaterjee
- Taksheel Gandhi
- Taksheel Shetty
- Talia Atkins
- Talia Gomez
- Talitha Goff
- Taliyah Boren
- Tama Mccray
- Tamanna Narula
- Tamatha Whitfield
- Tameka Pate
- Tami Rutledge
- Tamica Hays
- Tamie Witt
- Tamika Rosales
- Tamiko Stanton
- Tamim Iqbal
- Tamisha Nielsen
- Tammara Clemons
- Tammi Mooney
- Tamsi Grover
- Tamzin Gillespie
- Tanav Advani
- Tanaya Chawla
- Tangela Riggs
- Tanika Jarvis
- Tanima Chaddha
- Tanima Sood
- Tanisha Devi
- Tanisha Dillard
- Tanisha Patel
- Tanishka Sharma
- Tanishq Khatun
- Tanisi Banerjee
- Taniya Khanna
- Taniya Lima
- Taniya Seshadri
- Tanmay Patil
- Tanmay Sengupta
- Tanmayi Ghosh
- Tanner Perry
- Tanshika Adhikari
- Tanuj Ahuja
- Tanuja Chhabra
- Tanushree Sarkar
- Tanvi Lal
- Tanvi Patel
- Tanvita Banerjee
- Tanya Walker
- Tapan Bhattacharya
- Tapasi Chaddha
- Tapasya Laghari
- Tapendra Walia
- Tapesh Laghari
- Tara Grover
- Taral Malik
- Taran Khanna
- Tarangini Agarwal
- Taranjeet Singh
- Tarasha Jain
- Tari Levy
- Tariq Anwar
- Tarla Verma
- Tarsem Puri
- Tarsha Burch
- Tarshita Modi
- Tarulata Varghese
- Tarun Bhatia
- Tarun Kumar
- Tarun Monga
- Tarun Sharma
- Tarushi Kapoor
- Tashia Calderon
- Tashina Lynn
- Tate Campbell
- Tatiana Barnette
- Tatyana Demarco
- Tawana Cotton
- Tawanda Vaughan
- Tawanna Ewing
- Tawna Coffey
- Tawnya Dunlap
- Tayler Marroquin
- Taylor Bauer
- Taylor Peterman
- Taylor Spencer
- Taylor Stein
- Teagan Sage
- Ted Curry
- Ted Dunham
- Ted Weyland
- Teddy Reynolds
- Teena Pickett
- Teerthankar Suri
- Tej Subramaniam
- Tejas Bakshi
- Tejaswini Sood
- Telsa Floyd
- Temika Stein
- Tempie Bernard
- Temple Galloway
- Tennie Rosario
- Terence Glover
- Terence Halsey
- Terence Maran
- Teresa Brocco
- Teresa Carey
- Teresa Young
- Terry Caldwell
- Terry May
- Terry Ness
- Terry Santiago
- Tess Clarke
- Tessa Cohen
- Tessa Livingston
- Theda Meadows
- Thelma Bosso
- Thelma Chan
- Theo Beck
- Theo Elliott
- Theo Graham
- Theo Stewart
- Theobald Lane
- Theodora Dotson
- Theodore Graves
- Theodore Hammond
- Theodore Mckinney
- Theodore Mitchell
- Theodore Roa
- Theodore Schneider
- Theon O'Brien
- Theresa Heen
- Theressa Maddox
- Theron Sutton
- Thersa Haley
- Thomas Abbington
- Thomas Carrey
- Thomas Clark
- Thomas Grayson
- Thomas Haldane
- Thomas Jackson
- Thomas Kane
- Thomas Keenan
- Thomas Krueger
- Thomas Moran
- Thomas Murphy
- Thomas Spence
- Thomas Taylor
- Thomasena Brennan
- Thomasine Dudley
- Thresa Koch
- Thrisha Dhangar
- Tiara Horvath
- Tien Blackburn
- Tifany Harding
- Tiffani Chen
- Tiffanie Branch
- Tiffany Brown
- Tiffany Derrick
- Tiffany Gardner
- Tiffiny Middleton
- Tilly Martin
- Tim Byrne
- Tim Fischer
- Tim Foreman
- Tim Grayson
- Tim Kurian
- Timothy Armstrong
- Timothy Atkinson
- Timothy Campbell
- Timothy Eubank
- Timothy Feilde
- Timothy Garner
- Timothy Granger
- Timothy Kolaya
- Timothy Lawson
- Timothy Levy
- Timothy Rush
- Timothy Swayer
- Tina Ralph
- Tisa Bauer
- Tish Barr
- Tisha Sharma
- Titus Mason
- Titus Neal
- Tiya Kapoor
- Tiya Kulakarni
- Tobias Fry
- Toby Botkin
- Toby Dermot
- Toby Florey
- Toby Harvey
- Toby Hernandez
- Toby Lang
- Toby Marquez
- Todd Feola
- Todd Hopkins
- Todd Rollins
- Todd Stephens
- Toi Leach
- Tom Anniston
- Tom Byrd
- Tom Donnelly
- Tom Eccleston
- Tom Gladstone
- Tom Halt
- Tom Lee
- Tom Richards
- Tomi Sexton
- Tommie Gentry
- Tommie Hood
- Tommy Haynes
- Tommy McCarthy
- Tommy Villarreal
- Tomos Webb
- Tona Juarez
- Tonette Weiss
- Tonia Hurst
- Tonita Conway
- Tonja Prince
- Tony Andrew
- Tony McPherson
- Tony Sweeney
- Tori Barrows
- Torri Pacheco
- Toshiko Booker
- Toya Mcdowell
- Tracee Hardin
- Tracy Moody
- Travis Call
- Travis Gardiner
- Travis Larson
- Travis Madden
- Travis Reagan
- Travis Xavier
- Travon Romero
- Trent Dunlap
- Trent Lynch
- Trent Powell
- Trenton Hensley
- Trenton Ortega
- Tressa Hutchinson
- Tressie Parrish
- Trever Quinn
- Trevin Nguyen
- Trevor Begley
- Trevor Bowen
- Trevor Cornfield
- Trevor Fernandez
- Trevor Miller
- Treyton Howell
- Tridiva Dalal
- Trilok Kocchar
- Trilok Patel
- Trimurti Shirke
- Trinayani Rathore
- Trinidad Bishop
- Trinity Gill
- Trinity Harper
- Trish Kemp
- Trisha Coppola
- Trisha Datta
- Trishali Gupta
- Trishla Kohli
- Trishna Bhattacharya
- Trishna Boro
- Trishna Dikshit
- Trishna Ranganathan
- Trishna Vyas
- Trista Lu
- Tristan Boyd
- Tristan Howell
- Tristan Powell
- Tristan Swan
- Tristen Regan
- Tristen Williamson
- Tristian Montgomery
- Tristin Chapman
- Triston Rodriguez
- Triveni Kapoor
- Troyon Elwes
- Trudi Savage
- Trudy Bellinger
- Truman Ryan
- Trupti Jain
- Trupti Maitra
- Trupti Pattnayak
- Trystan Fields
- Trystan Summers
- Tucker Banks
- Tucker Nichollas
- Tucker Peters
- Tucker Watson
- Tuhina Chhabra
- Tuli Chaterjee
- Tulika Gupta
- Tunganath Bhushan
- Tunishaa Khanna
- Tushaar Chettri
- Tushaar Kohli
- Tvesha Bhowmick
- Twana Mosley
- Twanda Baxter
- Twila Grimes
- Tyesha Hensley
- Tyler Collins
- Tyler Morrow
- Tyler Myers
- Tyler Porterfield
- Tyler Smith
- Tyler Yeo
- Tylor Carpenter
- Tyrese Andrews
- Tyrone Hart
- Tyson Ernest
- Tyson Fowler
- Ubhay Ghoshal
- Uday Bhatt
- Uday Pandey
- Udaya Kashyap
- Uddhav Rathi
- Udit Choudhari
- Udita Mazumder
- Ujwal Varma
- Ukesh Dongre
- Ulhas Gurjal
- Ulrike Short
- Ulysses Drake
- Ulysses Wagner
- Uma Chaddha
- Uma Hazarika
- Umesh Bose
- Una Hancock
- Unnati Taneja
- Unni Mahajan
- Unnikrishnan Kapadia
- Upasana Kishore
- Upen Malhotra
- Upkaar Patekar
- Uriel Matthews
- Urja Sehgal
- Urjita Garg
- Urmi Nair
- Urmila Iyer
- Urmila Mathur
- Urvang Shekhar
- Urvi Tamboli
- Usaf Shariq
- Usha Aggarwal
- Usha Talukdar
- Ushma Ali
- Utkal Thakkar
- Utkarsh Kohli
- Utkarsh Prajapati
- Utkarsh Singhania
- Utkarsha Bansal
- Uttam Kasturi
- Uttam Kesri
- Uttam Mangla
- Vaanchi Maane
- Vaani Dube
- Vaarush Kapoor
- Vachan Bandyopadhyay
- Vagini Bajwa
- Vahini Mohanty
- Vaibhav Jain
- Vaibhav Verma
- Vaibhavi Menon
- Vairaj Ahluwalia
- Vaishali Grover
- Vaishnavi Shah
- Vajrabaahu Bisht
- Vajresh Kohli
- Vakrabhuj Nath
- Vakti Dalal
- Val Bradford
- Valda Ware
- Valencia Oconnor
- Valene Anthony
- Valentina Dupuis
- Valentina Houston
- Valentine Spencer
- Valeri Wolf
- Valeria Shank
- Valerie Kent
- Valorie Hodge
- Vamshi Rao
- Van Sawyer
- Vance Hawkins
- Vanda Clay
- Vandan Sinha
- Vandana Barman
- Vandana Mohan
- Vandita Kumar
- Vanessa Artiga
- Vanessa Flanders
- Vanessa Melton
- Vanessa Montgomery
- Vanessa Poole
- Vanessa Stafford
- Vanessa Stevens
- Vanna Marquez
- Vannessa Atkins
- Vanraaj Acharya
- Vansh Adhikari
- Vansidhar Advani
- Vanya Dyal
- Vardanya Thakur
- Varesh Khanna
- Varinder Waraich
- Varisha Parekh
- Varisth Ray
- Varman Muthu
- Varnika Dhillon
- Varsha Rao
- Varshini Kapur
- Varshita Malik
- Vartika Singh
- Varun Chatterjee
- Varun Deora
- Varun Grover
- Varun Pathak
- Varun Sahni
- Varun Srivastava
- Varunika Ojha
- Vasant Mehta
- Vasant Sen
- Vasanth Nigam
- Vasanth Sharma
- Vasiliki Bridges
- Vasu Kohli
- Vasu Narayan
- Vasudha Gamit
- Vasundhara Prakash
- Vati Modi
- Vatsaa Sharma
- Vaughn Rose
- Ved Mannan
- Ved Prakash
- Ved Rastogi
- Vedanshi Singh
- Vedant Ray
- Vedanth Shah
- Vedanti Choubey
- Vedantika Mahajan
- Vedaprakash Bachchan
- Vedashri Sachdev
- Vedesh Thakur
- Vedika Tiwari
- Vedishi Pillai
- Veditha Malhotra
- Veekshit Shah
- Veena Chudamani
- Veena Thakur
- Veeru Patil
- Velia Mckenzie
- Vella Underwood
- Vena Boone
- Venessa Harrington
- Venetta Tran
- Venisha Mann
- Vennie Lloyd
- Venu Burman
- Venus Clayton
- Veola Norton
- Vera Shaffer
- Verdell Jefferson
- Verna Moran
- Vernell French
- Verona Simon
- Veronica Martin
- Vertie Sherman
- Vesta Stokes
- Veta Gross
- Viaan Bhattacharya
- Vibha Iyer
- Vibhaakar More
- Vibhas Jain
- Vibhishan Murty
- Vibhor Banerjee
- Vibhor Nagar
- Vibhuti Narayan
- Vibhuti Yadav
- Vibodh Maitra
- Vibusha Saahu
- Vicenta Estrada
- Vicente Palmer
- Vickie Floyd
- Victor Baiss
- Victor Black
- Victor Bonn
- Victor Fargo
- Victor Kennedy
- Victor Martinez
- Victor Nason
- Victor Ogden
- Victor Perry
- Victor Quinn
- Victoria Aveyard
- Victoria Cuffe
- Victoria Heard
- Vidhyut Rao
- Vidur Sharma
- Vidush Narayan
- Vidushi Rawat
- Vidvathi Barot
- Vidya Bahuguna
- Vidya Goswami
- Vidya Lahiri
- Vidya Verma
- Vidyut Dadlani
- Vidyut Parekh
- Vihaan Devan
- Vijay Dalal
- Vijay Dixit
- Vijay Ranganathan
- Vijayalakshmi Yogi
- Vijayamalini Dutt
- Vijeesh Dhillon
- Vijeta Dua
- Vikas Das
- Vikas Yadav
- Vikash Banerjee
- Vikash Mukherjee
- Vikki Adkins
- Vikram Aggarwal
- Vikram Bhowmick
- Vikram Gill
- Vikram Kothari
- Vikram Nanda
- Vikram Verma
- Vikramaditya Khosla
- Vikramjeet Kulkarni
- Vikrant Ghoshal
- Vilma Rios
- Vimal Majumdar
- Vimal Singh
- Vin Lopez
- Vina Erickson
- Vinay Chander
- Vinay Grover
- Vinay Khatri
- Vinay Saxena
- Vinaya Gulati
- Vinayak Ghosh
- Vince O'Riely
- Vince Robertson
- Vincent Carlyle
- Vincent Emerson
- Vincent Fields
- Vincent Green
- Vincent Hopkinson
- Vincent Houston
- Vincent Jennings
- Vincent King
- Vincent Martin
- Vincent Parese
- Vincent Wesley
- Vincent Woods
- Vincenzo Gordon
- Vineesh Brar
- Vineeta Nayar
- Vineeta Reddy
- Vini Chahal
- Vinish Ghosh
- Vinit Bakshi
- Vinit Patel
- Vinita Joshi
- Vinod Mehta
- Vinod Patel
- Vinodini Kapoor
- Viola Patton
- Violet Dalton
- Violet Edwardson
- Violet Knight
- Violet Moore
- Violet Paige
- Violet Reich
- Violet Shaw
- Violet Youngman
- Vipin Chhabra
- Viplab Tripathi
- Vipul Batra
- Vipul Cheema
- Vir Bansal
- Viraj Thakur
- Viranath Dayal
- Virat Bassi
- Virat Mukherjee
- Virender Dalal
- Virender Kumar
- Virgie Strickland
- Virgil Fields
- Virginia Brackett
- Virginia Munn
- Virudh Deol
- Vishal Bhandari
- Vishal Bhardwaj
- Vishal Khanna
- Vishnu Dev
- Vishnudutt Kulkarni
- Vishti Giri
- Vishtika Chatterjee
- Vishv Jain
- Viswa Bhatt
- Vitasta Kumar
- Vittesh Khurana
- Viva Robbins
- Vivaan Adani
- Vivaan Jha
- Vivaan Kochhar
- Vivaana Puri
- Vivan Harmon
- Vivek Lamba
- Vivek Upadhyay
- Vivekanand Luthra
- Vivian Baldwin
- Vivian Belt
- Vivian Dunaway
- Vivian Miles
- Vivian Moritz
- Vivian Stone
- Vivya Narula
- Vladimir Latinovic
- Von Mason
- Vonnie Thornton
- Vrajakishore Madan
- Vrajlal Makkar
- Vrisha Mann
- Vrishabh Meghani
- Vruddhi Gautam
- Vrunda Parikh
- Vrushaali Verma
- Vyas Chauhan
- Vyom Shukla
- Vyshnavi Shah
- Wade Baxter
- Wade Chambers
- Wade Walsh
- Wai Mack
- Wajid Khan
- Walden Coppock
- Wallace Sanders
- Wallace Stevens
- Walter Barlow
- Walter Bell
- Walter Lennox
- Walter O'Hara
- Walter Ramon
- Walter Williamson
- Walton Gomez
- Waltraud Tate
- Wanda Warner
- Waneta Salazar
- Warda Sharma
- Warren Corrigan
- Warren Gibbs
- Warren Gittes
- Warren Guerra
- Warren Keating
- Warren Lyde
- Wasim Akhtar
- Wava Cummings
- Waylon Warren
- Wedge Burton
- Wei Daniel
- Wendel Mason
- Wendell Carter
- Wendolyn Lyons
- Wendy Witte
- Wenona Leonard
- Wesley Chandler
- Wesley Davis
- Wesley Keller
- Wesley Summers
- Weston Abernathy
- Weston Allen
- Whitney Rounds
- Wilbert Foster
- Wilbur Butler
- Wilburn Flores
- Wilford Powell
- Wilfred Clancy
- Wilfred Harding
- Wilfred Jordan
- Wilfrid Stevens
- Wilhemina Powers
- Will Barnes
- Will Davis
- Will Fisher
- Will Shelton
- Willard Bennett
- Willard Leopold
- Willene Santiago
- Willette Bush
- Willey Campbell
- Willia Mcdaniel
- William Barksdale
- William Barrowclough
- William Burton
- William Chang
- William Davies
- William Garcia
- William Miller
- William O'Brien
- William Ramsay
- William Sobol
- William Taylor
- William Young
- Willian James
- Willow Adams
- Willow Apodaca
- Willow Parker
- Wilson Martin
- Wilson Newman
- Wilton Murphy
- Windy Wise
- Winford Morgan
- Winfred Reed
- Winnie Sawyer
- Winter Hayes
- Woody Best
- Woody Bones
- Woody O'Neal
- Wren O'connor
- Wridhi Kohli
- Wyatt Avila
- Wyatt Cox
- Wyatt Kelly
- Wyatt Parker
- Wynne Davis
- Wynona Jennings
- Wynter Brown
- Xander Giles
- Xander Phillips
- Xander Posner
- Xavier Cleland
- Xavier Hazell
- Xavier Laurent
- Xavier Parsons
- Xavier Smith
- Xavier Stephen
- Ximena Redd
- Xochitl Soto
- Xuan Herrera
- Xzavier Mitchell
- Yaalini Chowdhury
- Yaami Bawa
- Yaamini Dhar
- Yaamini Singh
- Yaashvardhan Dhawan
- Yachana Parekh
- Yadevendra Saahu
- Yadhu Varma
- Yadiel Nelson
- Yadita Chaddha
- Yadunath Nehru
- Yadvinder Gautam
- Yagnesh Das
- Yagnik Biswas
- Yagnitha Seth
- Yagnya Deshpande
- Yahaira Vargas
- Yajat Balakrishnan
- Yaksh Ghai
- Yaksha Sharma
- Yakshatra Aggarwal
- Yakshi Mehta
- Yakshit Parihar
- Yakshit Reddy
- Yakshita Gill
- Yalkaa Sen
- Yamika Gujral
- Yamini Divan
- Yamini Iyer
- Yamini Krishnan
- Yan Holland
- Yanira Hoffman
- Yaseeta Ali
- Yash Chowdhury
- Yash Kohli
- Yash Pandey
- Yash Rao
- Yasha Roy
- Yashashree Bhosle
- Yashaswini Mehra
- Yashavini Guha
- Yashica Agarwal
- Yashika Ganguly
- Yashika Jhunjhunwala
- Yashika Singh
- Yashila Kohli
- Yashpal Katyal
- Yashvi Joshi
- Yashvi Kaul
- Yashvi Sharma
- Yashwa Reddy
- Yashwant Dalal
- Yasir Shah
- Yasmin Burns
- Yasmine Avey
- Yatan Kashyap
- Yatin Khattar
- Yatindra Kashyap
- Yatnesh Khullar
- Yazmin Mclemore
- Yen Hanson
- Yeshmita Deshmukh
- Yessenia Shade
- Yogesh Singh
- Yogeshwari Raj
- Yogishri Bhanot
- Yogishri Gokhale
- Yogita Raghavan
- Yolanda Almeida
- Yosha Parmar
- Young Wright
- Yu Richards
- Yudhvir Mahajan
- Yuette Oliver
- Yugant Chhibber
- Yugav Patel
- Yugma Bhandari
- Yuki Vasquez
- Yuko Gutierrez
- Yukta Ghose
- Yukti Chugh
- Yukti Dhansingh
- Yukti Kalluri
- Yun Kelley
- Yutika Dabral
- Yutisha Banerjee
- Yuvaan Dhumal
- Yuval Singh
- Yuvansh Gaitonde
- Yuvika Saahu
- Yuvita Balakrishnan
- Yuvraj Aneja
- Yuvraj Goel
- Yvette Burge
- Yvonne Cowell
- Yvonne Danner
- Zac Fredericks
- Zach Henderson
- Zach Jacob
- Zachary Allen
- Zachary Garcia
- Zachary Morgan
- Zachary Reeves
- Zachary Russell
- Zachary Walker
- Zachery Walker
- Zack Lewis
- Zack Reed
- Zack Wilson
- Zackary Clark
- Zada Fox
- Zaeef Beydoun
- Zafar Bhat
- Zafira Darbar
- Zahary Baharov
- Zahid Hanief
- Zahir Shah
- Zahira Khan
- Zahiya Farooqui
- Zahra Guler
- Zaiden Jonston
- Zain Ritchie
- Zain Thompson
- Zainab Haider
- Zaire Harris
- Zakary Jackson
- Zamda Hakim
- Zana Lane
- Zander Atkinson
- Zander Ellis
- Zander Jean
- Zandra Cunningham
- Zandra Edmonds
- Zane Batley
- Zane Bradley
- Zane Moore
- Zane Petrie
- Zara Bennett
- Zara Harris
- Zara James
- Zara Wilson
- Zarina Rizvi
- Zavier Miller
- Zayden Holcombe
- Zayn Hassan
- Zayn Middleton
- Zayne Brown
- Zayne Oliver
- Zeehan Ghazi
- Zeenat Anwar
- Zeenat Patel
- Zeeshan Ansari
- Zeh Ansari
- Zendaya Spencer
- Zenia Berry
- Zenobia Payne
- Zerrick Francis
- Zetta Gardner
- Zion Chorlton
- Zion Gibson
- Zion Wylie
- Ziyaad Abbasi
- Zoe Downward
- Zoe Eastwood
- Zoe Gilbert
- Zoe Hooper
- Zoe Luce
- Zoe Wordsworth
- Zoe Wright
- Zoey Clark
- Zofia Stone
- Zohan Shaw
- Zoie Slack
- Zoya Akbari
- Zoya Choudhury
- Zoya Marsh
- Zula Shaw

|
Author : Elsa Cooper Subject : Biochemistry, Genetics, Biotechnology and Molecular Biology ISBN :9781682868331 Biotechnology is a broad area of biology concerned with the development or manufacture of products using living organisms, biological systems and their derivatives. It integrates the principles of biological Read More |

|
Bioresource Technology: Concepts, Design and Applications Author : Elsa Cooper Subject : Biochemistry, Genetics, Biotechnology and Molecular Biology ISBN :9781682862261 As an academic discipline, the scope of bioresource technology is vast and it finds applications across many fields such as agriculture, etc. The aim of this book is to present researches that have transformed Read More |
|
Author : Elsa Cooper Subject : Biochemistry, Genetics, Biotechnology and Molecular Biology ISBN :9781682860977 Microbial biotechnology is an interdisciplinary field of study that incorporates concepts and techniques of microbiology and biotechnology to develop useful products. The topics covered in this extensive Read More |

|
Microbial Biotechnology: Methods and Applications Author : Elsa Cooper Subject : Biochemistry, Genetics, Biotechnology and Molecular Biology ISBN :9781641162227 Microbes are microscopic organisms, which include bacteria, viruses, fungi, protozoa and microalgae. They inhabit the soil, water, rocks, hot springs, food and animal intestines. Such a wide diversity Read More |

|
Recent Advances in Microbial Biotechnology Author : Elsa Cooper Subject : Biochemistry, Genetics, Biotechnology and Molecular Biology ISBN :9781641161169 Microbes are microscopic organisms like bacteria, virus, fungi, protozoa, etc. which are either unicellular, multicellular or acellular. Microbiology studies different classes of these microbes and branches Read More |

|
Microbial Physiology: A Practical Approach Author : Elsa Cooper Subject : Biochemistry, Genetics, Biotechnology and Molecular Biology ISBN :9781632399854 Microbial physiology studies the cell structure, metabolism and genetic structure of microorganisms. The fundamental concern of this subject is to understand the characteristics of complex organisms by Read More |
